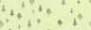
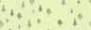

·
·
·
·
HörnerDörfer Heimat UrlaubsDörfer 2023 Urlaubsmagazin · www.hoernerdoerfer.de
Fischen
Ofterschwang
Obermaiselstein
Bolsterlang
Balderschwang



34 - 35 Themenüberblick 36 - 37 Urgewalt 38 - 39 Wasserwerke 40 - 41 Naturpark Nagelfluhkette 42 - 45 Das Wunder Wald 46 - 47 Kräuterwelt Naturkraft 06 - 07 Themenüberblick 08 - 09 3 Höhenlagen 10 - 15 Wandern in den Jahreszeiten 16 - 21 Familienurlaub 22 - 23 Abenteuerlust 24 - 29 Wintermärchen 30 - 31 Karte Skigebiete 32 - 33 Karte Wandern Alpine Erholung 48 - 49 Themenüberblick 50 - 51 Magische Orte 52 - 53 Stille hören 54 - 57 Alpine Auszeit Langsamkeit 2



58 - 59 Themenüberblick 60 - 61 Schlaraffenland 62 - 63 Allgäuer Käse 64 - 65 Grieß Di 66 - 67 Heimatzeit 68 - 69 Veranstaltungstipps 70 - 71 Noch mehr Allgäu Echt Allgäu Majestätische Berggipfel, atemberaubende Ausblicke, ursprüngliche Natur – Genussmomente sammeln. 72 Allgäu-Walser-Card | VIELcard 73 Anzeigen-Legende | Kurbeitrag 74 - 77 Gastgeberliste 78 - 97 Fischen & seine Gastgeber 98 - 107 Ofterschwang & seine Gastgeber 107 Sterneklassifizierung 108 - 117 Obermaiselstein & seine Gastgeber 118 - 127 Bolsterlang & seine Gastgeber 127 Impressum 128 - 135 Balderschwang & seine Gastgeber 136 - 137 Gastaufnahmevertrag 138 - 139 Anreise | Kontakt | Piktogramme Gastgeber & Anhang
Gott UrlaubsDörfer 3
Grüß
HörnerDörfer
Allgäu
Stolze Bergspitzen stehen Pate für unsere traumhafte Heimat: Das Rubihorn, die Hörnerkette mit dem Ofterschwanger und Bolsterlanger, dem Sigiswanger und Rangiswanger Horn und dem höchsten unter ihnen, dem Riedberger Horn. Ihre großartigen, teils felsigen Silhouetten markieren gleichsam den Umriss dieses kleinen Gartens Eden im Allgäu. Die Hörnerdörfer – ein Name aus hohem Stein gemeißelt.
NaturparkNagelfluhkette
Alp Dorf Balderschwang
Das Riedberger Horn, höchste Erhebung der Hörnerkette mit 1.787m
Vorarlberg
Österreich
4

 Kempten
Kempten
Stuttgart
Füssen A7 A8
Memmingen
München
Ulm
Oberstdorf
Lindau
DSV zertifiziertes Loipenparadies Die 2.000-jährige Eibe
Siplinger Nadel Alpenrosen
Riedbergpass, höchstgelegene dt. Pass-Straße
Erleben Unsere „Hörner“

Großer Alpsee Weltcup Dorf Ofterschwang Berg Dorf Bolsterlang Prädikat Heilklima Natur Dorf Fischen Heimat Dorf Obermaiselstein Au waldse e Iller Sonthofen Immenstadt B19 B308 B308 B19 Hörnerkette Hirschsprung Ofterschwanger Horn Weltcup-Piste Weltcup Express-Bahn Apollofalter Der Besler Fossilien entdecken Tiefenberger Moos Bolsterlanger Horn Bogenparcours Oberstdorf Kempten Breitachklamm Die Sturmannshöhle 120 Mio. Jahre Geschichte Eichhörnchen im Weidachwald Steinzeitdorf Hörnerbahn 5
Alpine Erholung

Atemberaubende Ausblicke: Vom wiesenweiten Illertal bis in die Allgäuer Hochalpen. Ursprüngliche Natur und 360-Grad-Gipfelblick wecken ungeahnte Glücksgefühle. In der frischen Bergluft, wenn gemütlich grasende Kühe zu Zaungästen werden und die Ruhe vom Zwitschern der Vögel und dem Glucksen eines Bachlaufs untermalt wird – dann wird Erholung zum Grundgefühl.
Urlaub im Rhythmus der Berge.

6

7
Wandern

3 Höhenlagen



Die fünf Hörnerdörfer im Oberallgäu liegen verteilt auf drei Höhenlagen. Sie bieten das Schonklima eines Gebirgstales wie auch das „reizende“ Klima der Gipfelluft. Zwischen dem Illertal und den Bergspitzen der Hörnerkette, von den Sonnenköpfen bis zu den Gipfeln der Allgäuer Hochalpen, hat die Luft Bewegungsfreiraum.

Das Paradies erreicht man zu Fuß. Beim Spazieren im Tal, über sonnige Höhen oder hoch hinauf zum Gipfel. Ringsum faszinierende Natur, rundum erhebender Weitblick –im Bergparadies der Hörnerdörfer.

8





800 m 1.300 m
Am Illerufer
Riedberger Horn
9
Kammwiesenweg Richtung Siplinger
BergFrühling


10
Wandern in den Jahreszeiten
Jede Jahreszeit hat ihre Wege
Die Täler laden mit zarten Frühlingsfarben zum ersten Spaziergang, wenn die Hänge noch in eisweißem Griff gefangen sind. Bald dann erwärmt die Sonne das Leben auf den Alpweiden und die altvertrauten Melodien der Kuhschellen erklingen. Im Alpsommer erfüllt jeder Weg einen Wunsch und weckt einen neuen. Bis der Herbst den Tagen Stunden stiehlt und sie dafür in Gold und Silber kleidet. Die Moore und Wälder reizen mit traumverlorenen Pfaden und schließlich hüllt der Winter die Welt in Weiß und Blau. Schneestille Wege haben die Silhouette der ruhenden Berge vor Augen. Bis die erste Primel den Schnee durchbricht und die Täler zum Spazieren laden ...



Wandern

11
… macht den Kopf frei … macht glücklich ... ändert den Blickwinkel … hebt die Laune … trainiert den Körper … lässt die Brotzeit besser schmecken
Freie Fahrt auf die Gipfel
Gipfelglück und Bergpanorama ohne schweißtreibenden Aufstieg – die Bergbahnen machen’s möglich. Bei vielen Gastgebern heißt es von Mai bis Oktober „Freie Fahrt mit den Allgäuer Hörnerbahnen“. Während des Aufenthalts ist für ihre Gäste täglich eine Berg- und Talfahrt kostenfrei.

Berg Sommer
Frühling – den gibt`s im Allgäu zweimal. Zur Melodie von glucksendem Schmelzwasser gesellt sich die warme Farbe der Allgäuer Paradeblume: dem Löwenzahn Leuchtend gelb recken sich die Federköpfchen den immer kräftigeren Sonnenstrahlen entgegen und die Kühe freut´s. Währenddessen liegen die höheren Lagen noch im weißen Kleid und erst spät erwachen die Gräser und Kräuter aus ihrem Winterschlaf.
Wer dann zu einer Tour aufbricht, kann erneut das Erwachen der Natur erleben. Kraftvoll und kraftspendend und in ihrer Farbpracht sogar eindrucksvoller, weil jedes grüne Hälmchen, jeder der durchscheinend lila Krokuskelche sich vor den letzten Schneefeldern und den reinweißen Berggipfeln wie ein kostbarer Solitär abhebt.

Sommer – wenn die Berge klingen, ist es soweit: Dann grasen die Rinder auch auf den höheren Alpweiden und ihre Schellen liefern den typischen Grundton bei ausgiebigen Wanderungen.
Der Allgäuer Bergsommer kommt mit langsamen Schritten, aber er hat für seine Gäste eine unverwechselbare Landschaft mit einem schier unermüdlichen Potential an Naturentdeckungen und Sportmöglichkeiten im Gepäck. Fast 400 Kilometer Wanderwege für jeden Anspruch lassen sicher keine Langeweile aufkommen. Dass die Energiereserven nicht versiegen, dafür sorgen die zahlreichen Alpen und Hütten mit zünftigen Brotzeiten oder süßen Stärkungen. www.hoernerdoerfer.de Freie Fahrt
Die Alpenrose
Pink ist im Allgäu keine Farbe, sondern eine Jahreszeit! Erleben Sie ein außergewöhnliches Naturschauspiel: die Alpenrosenblüte in den Allgäuer Alpen. Schnell sein lohnt sich, denn Saison haben die knalligen Blüten nur von Juni bis Juli zum Beispiel am Rangiswanger Horn. www.hoernerdoerfer.de Alpenrosenblüte

12
BergHerbst


Unterwegs im Hochmoor



… ein Hauch von Skandinavien umgibt die leuchtenden Moore der Hörnerdörfer und erinnert an die stille Schönheit nordischer Nadelwälder. www.hoernerdoerfer.de Wannenkopf-Wandertour
 Sonderdorfer Kreuz
Sonderdorfer Kreuz
13
Wannenkopf Moor
Schritt für Schritt durchs Hörnerjahr
Herbst – eine Zeit des Loslassens.

Die Obstbäume lassen ihre Früchte und die Buchen ihre rotgoldenen Blätter los. Der Wanderer sollte es ihnen gleichtun. Loslassen, das Jahr gemächlich ausklingen lassen, damit die gelassene Stille der herbstlichen Landschaft der Hörnerdörfer auf die Seele wirken kann. Es ist gut, mal keine Pläne zu machen, sondern dem Tag Raum und Zeit zu geben. Dann wird die milde Herbstsonne zum besten Zeitmesser, weil sie noch ein Stündchen die Ruhebank wärmt. Dann werden glänzende Kastanien, die auf verträumte Pfade kullern, zum Wegbegleiter. Und nach einem Tag in der klaren, weichen Luft ist der Duft einer heißen Tasse Kräutertee oder einer dampfenden Schüssel Allgäuer Kässpatzen so viel intensiver.
Moore erleben– man setzt seine Schritte vorsichtiger. Hier, wo der Boden weich und nachgiebig ist. Man muss genauer hinsehen, um in den dicken Polstern die filigranen Blättchen der Moose zu erkennen, die wie kleine Fingerchen ineinander gehakt sind. Im Herbst glänzen die Tautropfen des Morgennebels noch im Wollgras und die Sonne verdoppelt sich in den lackschwarzen Wasserspiegeln längs des Weges. Ganz eigen muten die Hochmoorlandschaften der Hörnerdörfer an, fast schon nordisch. Ruhig und beruhigend bieten sie spät im Jahr ein farbenprächtiges Schauspiel, als würden flammende Heidelbeersträucher und rostgoldene Gräser mit dem Himmelsblau im Leuchten wetteifern.
Winter – bei jedem Schritt knirscht der Schnee unter den Sohlen, die Welt scheint in weiße Watte gepackt. Der Atem wird sichtbar, die Bergsilhouette zeichnet sich scharf am Horizont ab – es ist Winter in den Hörnerdörfern. Das Wandern auf bestens präparierten Winterwanderwegen ist einfach, das lädt zu stillverträumter Betrachtung ein: Im Bergwald, wo schneebedeckte Zweige sich zum Gruß verbeugen oder bei einer Wanderung im Dämmerlicht, wenn Fackeln und Laternen Muster auf dem Weg tanzen lassen. Entdecken Sie auf www.hoernerdoerfer.de: • Winterwandern Winterparadies zum Wandern
• Tour mit tollen Ausblicken Panorama Winterwanderweg
• Leichte Wanderung Winterspazierweg

Aussicht vom Malerwinkel
14
Wandertrilogie Weit wandern


Die Wandertrilogie zeigt die Vielfalt des Allgäus – von der Hügellandschaft bis zu den Terrassen, das Voralpenland und das Gebirge. Damit bietet sie auf insgesamt 876 Kilometern und 54 Etappen Wandererlebnisse auf drei Höhenlagen. Hier findet jeder Wandertyp gelungene Touren für seine Ansprüche, ob gemütlich durch grüne Wiesen oder ambitioniert über die Gipfel.

Die Hörnerdörfer sind ein Garten Eden der Alpen. „Alpgärten“ nennt sich deshalb der Trilogieraum zwischen dem Portalort Fischen, Ofterschwang, Obermaiselstein, Bolsterlang und dem Etappenort Balderschwang. Vom Illertal bis zu den „Himmelsstürmer“-Wegen zeigt die Wandertrilogie Allgäu hier ihre paradiesische Seite. www.hoernerdoerfer.de Allgäuer Wandertrilogie

15
Gefördert durch das Bayerische Staatsministerium für Ernährung, Landwirtschaft und Forsten und den Europäischen Landwirtschaftsfonds für die Entwicklung des ländlichen Raums (ELER)
BergWinter
Urlaubs-Abenteuer Familie


16


17
Das „Draußen“ erleben

18
Familientag auf der Alpe







19
Berge, Spaß, Abenteuer & entspannte Eltern
Sagenweg
Uralten Mythen auf der Spur. Vom Wilden Fräulein, Drachen und sagenhaften Schätzen. www.hoernerdoerfer.de Sagenweg
Stuimändleweg
Für echte Abenteurer. Abenteuerspielplatz, Hochsitz, Hängebrücke. www.hoernerdoerfer.de Stuimändle Erlebnisweg
„Sich zit long“ weg
Alles, aber ohne Eile. Streichelzoo, Wasserfall und Wildgehege. www.hoernerdoerfer.de Zit long Weg

FamilienTag
Sturmannshöhle

120 Millionen Jahre Erdgeschichte. Hinab steigen in die Tiefen der Erde. www.hoernerdoerfer.de Sturmannshöhle
Kutschfahrten
Spritztour mit 2 PS. Mit Hufgeklapper „querfeldein“. www.hoernerdoerfer.de Pferdekutschfahrten

Breitachklamm

Rauschendes, tosendes, fließendes Nass. Tiefste Felsenschlucht Mitteleuropas. www.hoernerdoerfer.de Breitachklamm


20
Familienspaß am Illerufer

Abenteuer für Groß und Klein

Entdecker-Pass Hier gibt es was zu erleben, hier tanzt der Spaß! Und mit dem Entdecker-Pass wird der Spaß auch noch belohnt: Fürs Wandern, Rätseln, Älpler-Brotzeit-Machen und viele, viele andere Spaßerlebnisse gibt es Stempel und Punkte und die tauscht man dann in den Gästeinformationen gegen eine Spürnasen-, eine Pfiffikusoder sogar eine Tausendsassa-Medaille ein. www.hoernerdoerfer.de Entdecker-Pass


Familienprogramm





In diesem
Heft gibt es noch mehr zu entdecken: beim Besuch bei der Feuerwehr oder Familienrafting auf der Iller, bei der Spurensuche für Naturentdecker und bei einer Schnitzeljagd. Man kann sich verzaubern lassen vom Zauberer genauso wie vom Kasperle oder einfach auch nur von einem leckeren Eis. Egal, auf was die Entscheidung fällt, der Allgäu-Urlaub wird auf jeden Fall „spannend“. www.hoernerdoerfer.de familienurlauballgaeu
21
Abwechslungsreiche Urlaubserlebnisse für Bergfüchse, Naturforscher und Schleckermäuler.





22





23
Weiße Berge, blauer Himmel, strahlender Sonnenschein – endlose Schneewelt Skifahren und Snowboarden

24
Schneeschuhwandern Weltcup in Ofterschwang 2024 Rodeln, Abendrodeln und Schlitteln Langlaufen und Flutlichtlanglaufen
Glitzernde Märchenlandschaft
Jeder Schneeschritt knirscht unter den Sohlen, die Welt in weiße Watte gepackt. Glänzendes Weiß trifft auf tiefes Blau, und unter einer hohen Sonne zeichnet sich die Bergsilhouette scharf am Horizont ab – es ist Winter in den Hörnerdörfern.

Schlittschuhlaufen und Eisstockschießen
Kutschfahrten mit Märchengefühl
Winterwandern
25





26
Höhen-Panoramaweg zum Berghaus Schwaben
LanglaufEldorado
Vom Illertal bis ins schneesichere Hochtal von Balderschwang – mit 110 km ein Langlaufparadies ohne Gleichen. Die auf 1.044 m Höhe gelegene DSV-zertifizierte Grenzlandloipe führt von Balderschwang bis nach Hittisau in Voralberg (Österreich). Die Hörnerdörfer Fischen, Obermaiselstein, Bolsterlang und Ofterschwang bilden zudem ein abwechslungsreiches Loipennetz im Tal. Für Nachtschwärmer steht auch eine Flutlichtloipe zur Verfügung. www.hoernerdoerfer.de Langlaufen … und erschafft in den Hörnerdörfern ein Meisterwerk auf schneeweißer Leinwand. Die Konturen bilden Pisten, Loipen und kilometerweite Winterwanderwege. Rodelbahnen und Schneeschuhrouten im Morgenlicht oder Laternenschein setzen magische Akzente, dazu Liegestuhl und Leibspeise – Winterwonne wie gemalt.




Der Winter ist ein Künstler


27
HörnerSchnee(S)paß 5 Skigebiete – 1 Skipass
Pisten für Skizwerge und Weltcup-Elite
Fünf Skigebiete, die Ski-Neulinge nicht überfordern und auch bei Könnern keine Wünsche offenlassen: Balderschwang, Bolsterlang, Obermaiselstein/ Grasgehren, Ofterschwang und Fischen. Ob mit Brettern oder Board, ob Zauberteppich in der Skischule, Idealhang für junge Familien oder die anspruchsvolle Weltcupstrecke – hier findet jeder die richtige Piste. www.hoernerdoerfer.de HörnerSchnee(S)paß

28







Skigebiet Balderschwang Skigebiet Bolsterlang Skigebiet Ofterschwang Skigebiet FischenSkigebiet Grasgehren 90 Pistenkilometer | 31 Lifte Mit zahlreichen Hütten und Einkehrmöglichkeiten im Skigebiet sowie Schneesportschulen und Skiverleih. www.hoernerdoerfer.de Skiurlaub 29


Hörnerhaus Oberthalhofen Unterthalhofen Iller Piesenkopf1630m HoherIfen2230m Riedbergerhorn1787m Riedbergpass 1409m Wannenkopf 1712m BolsterlangerHorn 1586m Grasgehrenhütte 1447m Obermaiselstein849m Bolsterlang892m Fischeni.Allgäu761m Nachtloipe Ofterschwang864m Weiherkopf 1665m Oberstdorf3km Mittelalpe SkigebietRiedbergerhorn BerghausSchwaben NaturparkNagelfluhkette Winterwanderweg7km Funpark HörnisNest Winterwanderweg3km Kierwang Sonderdorf Talhütte Basislager Snowtubing Mittelstation Ski-undBoardercross Dorflifte Au Langenwang Auwaldsee PassStüble& Loipenkiosk Liftstadl Niederdorf Oberdorf Ried Tiefenberg Sigiswang Schwarzenberglift Hörni‘sKinderland 2erSesselbahn Bolgengratbahn 2erSesselbahn Riedbergerhorn 6erSesselbahn Weiherkopf SkigebietGrasgehren SkigebietHörnerbahn SkigebietStinesser LoipeRichtungOberstdorf LoipeRichtungOberstdorf Hochschelpen1564m S'Mibbadin Pistenhits 30


Wurzelhütte LeitenbachHütte Unterthalhofen Altstädten Iller Ofterschwang864m Weiherkopf 1665m OfterschwangerHorn 1406m Oberzollbrücke Balderschwang1044m Gschwend BodenBalderschwang1250m Fuchs-Alm1310m Schwabenhof NaturparkNagelfluhkette NaturparkNagelfluhkette HochbichlHütte Weltcup-Hütte BerghausBlässe Winterwanderweg2,4km Schelpenalp Westerhofen Sigishofen OfterschwangerHaus Bettenried Hüttenberg SchlitteHitte Sonthofen Erlebnis-und FreizeitbadWonnemar SpeicherteichGaisrücken GunzesriedSäge 6erSesselbahn Gipfel-6er 8erKabinenbahn Ossi-Reichert-Bahn PassStüble& Tiefenberg Muderbolz Sigiswang Schweineberg 6erSesselbahn Hochschelpenbahn Käshütte 4erSesselbahn Schelpenbahn Schwarzenberglift Gelbhansekopflift Gschwendstüble Vorarlberg zurBurgl-Hütte Feuerstätterkopf1645m 6erSesselbahn Weiherkopf Kempten27km SkigebietBalderschwang SkigebietOfterschwangGunzesried SkigebietHörnerbahn Gunzesried889m Januar2022 LoipeRichtungSonthofen Hochschelpen1564m










Oberthalhofen Au Unterthalhofen Weiler Maderhalm Langenwang Berg Niederdorf Oberdorf Jägersberg Ried Sturmannshöhle Sonderdorf Bolsterlanger Wa Riezlern Kleinwalsertal Breitachklamm WalmendingerHornBahn Söllereckbahn Nebelhornbahn Oberstdorf Freibergsee Rubihorn 1957m Rubi Reichenbach Auwaldsee Schöllang Grünten 1738m Untermühlegg Tiefenberg Dietrichs Schweineberg Sigishofen Golfresort SonnenalpOberallgäu (45-Loch) Obermühlegg Schöllanger Burgkirche Biberkopf 2599m Mädelegabel 2645m Trettachspitze 2595m Widderstein 2533m Fellhornbahn Kanzelwandbahn Bergbahn Fischen 761m Bolsterlang 892m Obermaiselstein 876m Wanderträume 32







Bolsterlanger Horn 1586m Wannenkopf 1712m Besler 1679m Grasgehren Weiherkopf 1665m Rangiswanger Horn 1616m Bregenz Bodensee A/CH Sonthofen Riedberger Horn 1787m Hochschelpenlifte Wielenberg Sigishofen Muderbolz Kierwang Sigiswang Westerhofen Bettenried Hüttenberg Gunzesried Weltcup-Express Hörnerbahn Ofterschwanger Horn 1406m Sigiswanger Horn 1527m Hoher Ifen 2230m Piesenkopf 1630m Hochschelpen 1552m Gelbhansekopf 1437m Bleicherhorn 1669m BergbahnIfen Ofterschwang 864m Balderschwang 1044m 33
Naturkraft

Eine Kraft, die formt. Eine Kraft, die schützt und heilt. Eine Kraft, die Sinne und Geist beflügelt. Die Natur - sie modelliert mit Kraft und Zeit den höchsten Berg und die zarteste Blume und präsentiert sich allen, die mit wachen Augen und offenem Herzen sehen.
Kraft, die eigene Natur zu entdecken.

34
Am Hinanger Wasserfall

35
Besler

Vor Millionen Jahren
… überzog eine mächtige Zunge aus Eis das Land - der Illergletscher. Er hinterließ steinerne Vermächtnisse und gewaltige Flussläufe. Die Urgewalt des Eises zwang unterschiedliches Gestein in ein Bündnis, aus vielen Steinen wurde einer: der Nagelfluh Wie in den Fels genagelt scheinen die Kiesel – so fest, wie nur göttliche Hand es vermag, glaubten die Menschen und nannten den Nagelfluh „Herrgotts-Beton“
Heute
… ist jenes Eis vergangen, das das sanfte Gebirge des Naturparks Nagelfluhkette formte. Heute sind die Gipfel einladend, die Terrassen und Höhenzüge offen und zugänglich, ja heimelig liegt die Landschaft da. Und doch will sie ihre Urzeit nicht leugnen: Zu gut setzen bizarre Grate, schroffe Wände oder spektakuläre Felsennadeln einen Kontrapunkt in diese malerische Bergwelt.

36
UrGewalt
Gewaltig und faszinierend
Der Beslergipfel besticht durch seine außergewöhnliche Gesteinsart, dem Schrattenkalk. Mit seinen breiten Gesteinsplatten, den sogenannten Schratten, ist er im Naturpark Nagefluhkette einzigartig. www.hoernerdoerfer.de Beslerrunde
Die Bäume des Waldes hängen voller Zapfen aus Gold.
Die Alten erzählen, dass einst ein Bauer einen Spiegel fand. Er hob ihn auf und erblickte darin den Berghang und den Wald am Schwarzenberg. Die Bäume des Waldes hingen voller Zapfen aus purem Gold und glänzten in den Augen noch prächtiger als funkelnde Eiszapfen im Winter. Er sah ein Männlein, emsig damit beschäftigt, die goldenen Zapfen in einen schweren Sack zu sammeln. Als das Männchen seines Beobachters gewahr wurde, flehte er ihn an, den Spiegel wegzuwerfen, anderenfalls müsse er sterben. Der fromme Bauer tat, wie ihm geheißen und flugs war die goldene Zapfenpracht verschwunden. Das Männlein schenkte ihm zum Dank einen dicken Goldzapfen und der Bauer und seine Familie hatten seitdem keine Not zu leiden.

 Aus der alten Venediger Spiegel-Sage
Aus der alten Venediger Spiegel-Sage
37
Sturmannshöhle

Einzige zugängliche Höhle des Allgäus. Auf über 180 Stufen geht es 300 m tief entlang 120 Millionen Jahre alter Gesteinsformationen. Ganzjährig begehbar bei konstant 8°C.

38
WasserWerke
In unseren Tagen
… zeigt das Wasser zumeist sein sanftes, elegantes Antlitz: Die Gebirgsbächlein murmeln leise, der Scheuenwasserfall sprüht fadenfeine Wasserbordüren, die sich im Sonnenlicht in tausend Farben brechen und der majestätische Strom der Iller gleitet mal in dunklem Azur, mal in hellem Türkisblau der Donau entgegen.


Einst vor langer Zeit

… formte das Wasser die Landschaft mit ausdauernder Kraft. Ammoniten aus warmen Urzeitmeeren zeugen davon. Markante Bergspitzen, die geschwungenen Talränder und weite Flusstäler entstanden durch die Gletscher der fünf Eiszeiten, und noch jeder glattgeschliffene Kiesel, mit dem ein Steinmännle wächst, zeigt dies Erbe, das vom Wasser blieb.

39




 Auf dem Weg zum Riedberger Horn
Auf dem Weg zum Riedberger Horn
40
Birkhuhn






Apollofalter 41
Wunder


42
Auwald und Auwaldsee mit Blick auf die Allgäuer Hochalpen
Wälder Grüne Vielfalt


43



44
Trödeln ist das richtige Tempo. Ein Vollbad in Waldatmosphäre – intuitiv gehen, schlendern, einfach an einen Baum lehnen, im Moos sitzen. Ohne Schrittzähler und Fitness-Tracker. Beim Waldbad kommt man langsam schneller ans Ziel.

Farbe und Licht Sonnenflecken, die in den Ästen tanzen. Ein grünes Dach, das heimelig beschützt. Farbe und Licht wirken hier besonders wohltuend auf‘s Gemüt. Das Grün des Waldes befreit den Geist und beflügelt die Phantasie.

Heute schon gebadet?
Waldbaden wirkt Waldduft ist gesund, denn die Duft- und Botenstoffe der Pflanzen sind stimmungsaufhellend, senken Blutdruck und Cortisolspiegel und stärken die Immunabwehr – auch noch Tage nach einem Waldbad.

Schwimmübung Fotografieren mit den Augen. Erinnerung statt digitaler „Doku“. Eine Waldstimmung lässt sich nicht auf Fotos bannen. Besser: Das Handy bleibt aus und die Sinne übernehmen. Denn der Erinnerungsspeicher der Seele ist groß genug für schöne Momente.
Schwimmübung Ansichtssache Die eigene Körpergröße steht fest, aber die Perspektive lässt sich ändern. Waldbetrachtungen auf einem Baumstumpf oder in der Kniebeuge zeigen neue Seiten – auch an sich selbst.
45
Kräuter
Heilsam, wild, pur





Kräuter parfümieren die Luft von den Berghöhen bis zu den Flussufern im Tal. Sie leuchten in hellen, kräftigen Farben entlang der Wege und geben Käse seinen unvergleichlich würzigen Geschmack. Kräuter umschmeicheln die Sinne, regen an, sie beruhigen, sie stärken. Allgäuer Kräuter tun vom Kopf bis in die Zehen wohl.

www.hoernerdoerfer.de Kräuter
46





47
Langsamkeit
Zeit im Allgäu hat ihren eigenen Takt. Sie rennt nicht, sie hetzt nicht, sie schenkt Ruhe und jedem Augenblick sein verdientes Maß. Ist es die ehrwürdige Stille der Berge, die weite Sicht oder die klare Luft? Sind es die Traditionen, die im Einklang mit dieser ursprünglichen Natur gepflegt werden? Wohl alles zusammen. Und es wirkt. Es erdet, macht achtsam und tut einfach gut. Die Hörnerdörfer sind ein Paradies aus Licht, Luft und Bergen.

Willkommen in der Anderszeit.

48

49
… nichts suchen, nichts erwarten, den magischen Moment willkommen heißen. An Orten, die ein klein wenig mehr sind als nur ein Platz auf der Welt. An Orten, die uns auf besondere Art berühren, weil von ihnen spürbare Kraft ausgeht.


50
Auf dem Riedberger Horn


Magisch Sturmannshöhle Hirschsprung Scheuenwasserfall Illerursprung Orte voll spürbarer Kraft Auwaldsee 2.000-jährige Eibe Tiefenberger Moos Wittelsbacher Höhe Breitachklamm 51
Stille hören
Stille ist etwas anderes als die Abwesenheit von Geräusch. Es ist dieser wertvolle Moment, wenn das Innen mit dem Außen in trauter Zufriedenheit schwingt, wenn die Seele in schönster Kulisse entspannen darf – Tagträumen in den Hörnerdörfern.


Achtsamkeit nach Hörnerdörfer Art TippsfürsInnehaltenundfürsgenaue Hinschauen,fürsRunterfahrenundfürden GenussdesMoments. www.hoernerdoerfer.de Naturkraft Langsamkeit
52
Wo die Uhren erholsam ticken
Zeit im
Allgäu
… heißt sich Zeit nehmen, innehalten, zur Ruhe kommen. In den Hörnerdörfern gibt die Natur den Rhythmus vor. Hier wird das Herz weit und die Seele tankt auf. Oben auf dem Berggipfel schweift der Blick bis zum Horizont. Dort ist die Stille fast hörbar – ein ganz besonderes Wohlgefühl. Einfach dasitzen und genießen, die majestätischen Gipfel der Allgäuer Alpen vor Augen – atemberaubend schön.
Was flüstert eine Wolke?
Wie klingt eine Schneeflocke?
Wie schmeckt frische Bergluft?
53
Wo ist die Welt leise genug, damit ich meine Seele hören kann?


Erholsam Befreit Durchatmen Seelenwärmerauszeit Seele im Takt der Langsamkeit Alpines Heilklima Genussmomente sammeln Berge, die Lebensgeister wecken 54


55
… für die Seele … für den Körper … für den Geist
Wohlfühlen
auf Allgäuer Art

Wohnen mit Wohlfühlfaktor
Ausgewiesene Hotels, Wellness-Resorts und Betriebe, die sich ganz bewusst Entspannung und Erholung auf die Fahne geschrieben haben, sind in den Hörnerdörfern in vielen Facetten zu finden. Entsprechend reicht die Bandbreite der Angebote von (physio-)therapeutischen Schwerpunkten über Meditation und Achtsamkeitsübungen bis zu exquisiten Beautyanwendungen. Neugierige und Kurzentschlossene lassen sich im DaySpa verwöhnen, weil auch eine kleine Prise Luxus Wunder wirken kann.




Reizvolles
Heilklima
Temperatur, Luftdruck, Windrichtung oder Sonnenstunden – in Fischen trifft man diese Klimafaktoren in einem ausgesprochen guten Verhältnis an. Sie wirken einerseits schonend, setzen andererseits aber auch stimulierende Reize. Heilklima zeigt seinen Effekt übrigens nicht nur bei einer Kur oder einem strikten Training, sondern ganz einfach „nebenbei“, z. B. bei einem Spaziergang – und das zu jeder Jahreszeit. Das Zertifikat Premium-Class verdankt der beschauliche Kurort dem Engagement für ein attraktives Ortsbild und seiner Verbundenheit zur Regionalität.
Fischinger Salzgrotte
Die Fischinger Salzgrotte lädt ein zu einer Brise Meeresluft in den Bergen. 20 Tonnen warmes Steinsalz lassen Entspannung zu einem gesunden Genuss werden. Die salzhaltige Luft wird bei Atemwegsbeschwerden und Allergien empfohlen. Das salzige Mikroklima unter einem sanften „Sternenhimmel“, dazu samtweiche Melodien und das leise Plätschern des Solebrunnens darf man sich schlicht auch als wohlige Auszeit gönnen.
56
Berge, Luft und Licht. Inspirierend, kraftvoll, ehrlich.
Vitale Kraft aus den Bergen
Wellness made im Allgäu
Urlaub ist eine gute Zeit, neue Kräfte zu sammeln, den inneren Akku zu laden und sich tief zu entspannen. Zur Erholung, als Prophylaxe oder zur Regeneration. Die Bergnatur der Hörnerdörfer ist die Basiszutat einer heilsamen Belebung. Berge, Luft und die Natur im Zauber der Jahreszeiten wirken erquickend und ihre Nebenwirkungen tun der Seele gut.
Viele Wellness-Anwendungen schöpfen aus der Natur, speziell aus den Gaben der Allgäuer Berge: Kräuterstempel, Dampfbäder mit alpiner Latschenkiefer, Heukraxn oder die innovativen Milchwell®-Produkte sind ein Labsal für die Sinne und ergänzen sich aufs Beste mit traditionellen Wellnessangeboten aus der ganzen Welt. www.hoernerdoerfer.de/wellness Wellnessurlaub

57
Echt Allgäu
Tradition braucht in den Hörnerdörfern weder Retro noch Kitsch. Denn hier wird sie von den Menschen gelebt. Tag für Tag, einfach echt.
Allgäuer Lebensart.


58

59
Vollwertbäckerei
… hier schmecken das Brot, die Dinkelherzen oder Nussecken nach vollem Korn. Ob´s dann butterzart oder kernig sein darf, ist Geschmackssache.
& Brände
… darin schmecken reife, süße Früchte, Kräuter oder knackige Nüsse. Sie werden in der Bergbrennerei im Bauernhaus Busche Berta zum destillierten Genuss der Allgäuer Natur.

Schlaraffen Land
Bergbauernbier

… wenig schmeckt nach viel. Im Bier ergeben wenige Zutaten viele unterschiedliche Geschmacksnuancen. Wie man die Vielfalt von Hopfen und Malz erreicht und wie man sie erschmeckt zeigen die Biersommeliers in der Mikrobrauerei.

Selbstgemachtes
… schmeckt einfach besser. Ob Torten, Kuchen oder Eis - wenn es selbstgebacken, von Meisterhand gerührt und mit Liebe serviert ist, schmeckt man´s raus.
60
Schnäpse
Honig
… schmeckt hell und mild vom Löwenzahn, aromatisch von den wilden Alpkräutern oder dunkelwürzig vom Honigtau im Bergwald.
Heumilch- & Bioeis
… schmeckt nach Schoko, Vanille, Erdbeer. Oder nach Holler, Buttermilch-Hagebutte und Alpenkaramell. Aber alles aus frischer Milch von Allgäuer Kühen.
Gebratene Tauben fliegen nicht durch die Hörnerdörfer, aber auf besondere Genüsse trifft man allerorten. Ein guter Wegweiser sind die Gütesiegel: Das Siegel „Gutes vom Dorf“, die drei blauen Rauten für „Ausgezeichnete Bayerische Küche“ oder die Plakette „Alpgenuss“ zeugen von Frische, Qualität und regionalen Produzenten. Ob Brot und Wurst, Bergbauernbier und Haselnussschnaps, Bioeis und Tortenträume - der Geschmack ist vielseitig aber immer ausgezeichnet. Natürlich rollen auch heimische Alp- und Bergkäseallgäuweit verkostet und mit Gold prämiert – durch das Schlaraffenland der Hörnerdörfer.


Käse
… schmeckt von sahnig-mild bis würzig-scharf. Käse schmeckt als großes Stück vom Laib, als dick belegtes Käsebrot auf der Wanderung oder zerschmolzen auf dem Spätzleteller.
61








steckt
gutem
Das alles
in
Käse …
Milch Vonglücklichen
Diesaisonale
& Licht GesundesBergklimafür Mensch&Tier 62
Tradition Erfahrungsammeln undweitergeben Reines Wasser Kühl,klar, direktvomBerg Frische
Kühen Geduld GeschmackbrauchtZeit zurEntfaltung Alpkräuter
Würzmischung Luft
Im Allgäu ist Käse eine runde Sache
Alpwirtschaft – Beste Basis für Kraut & Kuh. Guter Käse braucht eine gesunde Basis. Im Allgäu pflegt die Alpwirtschaft eine alte Kulturlandschaft mit viel Herzblut und Handarbeit. Die Alpwirtschaft sorgt dafür, dass Lichtweiden offen und Magerwiesen als wertvolle Biotope erhalten bleiben. Und sie achtet darauf, dass jede Alpe mit der passenden Anzahl Vieh beschlagen wird – also gerade so viele Rinder zur Sömmerung zugeteilt bekommt, wie es Tier und Natur gut tut. Die Älpler übernehmen sozusagen die Landschaftspflege in den Bergen –Nutznießer sind neben den Alpkräutern und Kühen aber nicht zuletzt die Gäste, die sich an dieser paradiesischen Natur erfreuen und ihre Früchte genießen dürfen.
Jahreszeiten schmecken. Eine Alpweide sieht im Frühsommer ganz anders aus als im Spätsommer; sie duftet anders und sie schmeckt auch anders! Genauer: Im Käse lassen sich unterschiedliche Nuancen herausschmecken, je nachdem, welche Gräser, Kräuter und Blumen der Milchkuh als Futter dienten. Natürlich bleibt ein Bergkäse ein Bergkäse, aber jeder Laib ist immer ein einmaliges Geschmackserlebnis.

Charakterkäse – gemacht mit Wissen, Zeit und Augenmaß. Mit Milch und Lab ist es beim Käsemachen nicht getan, denn was ein ordentlicher Allgäuer Berg- und Alpkäse oder Emmentaler werden will, muss liebevoll gepflegt werden: Von Hand wenden, in Salz baden und mit viel Geduld ruhen lassen, nur so reift das jeweils charakteristische Aroma. Obwohl auf den Sennalpen und in den Sennereien auch moderne Technik beim Erhitzen oder Rühren hilft, ist das Augenmaß des Käsemeisters entscheidend. Wann ist die „Dicklegung“ fertig? Wie fein muss der Käsebruch sein? Wieviel Druck wird auf die Presse gegeben? Bei diesen und vielen anderen Fra-
gen helfen nur Wissen und der erfahrene Blick. Nur so entsteht am Ende nicht ein 08/15-Käse, sondern ein Qualitätsprodukt mit typischem Charakter. Der Verein Allgäuer Alpgenuss e.V. hat sich deshalb zum Ziel gesetzt, derartig hergestellten Käse und generell regionale Erzeugnisse zu fördern. Die Produzenten und Partner vom Allgäuer Alpgenuss tragen mit der Vermarktung heimischer, nachhaltiger Produkte dazu bei, die traditionelle Alpwirtschaft zu erhalten. Überall, wo sich das Siegel mit der Feinschmecker-Kuh findet, darf man sicher sein: Hier steckt ehrlicher Allgäuer Genuss drin.
Kesselgucker – zu Besuch auf der Alpe. Ein Blick in den Käsekessel kann zu einem Blick über den Tellerrand werden. Wortwörtlich, weil einem bei einem Rundgang auf der Sennalpe erst bewusst wird, wieviel Arbeit in einem Stück gutem Käse steckt. Außerdem lässt sich so ein Besuch mit einem herrlichen Ausflug verbinden, und dann schmeckt die Käsebrotzeit nochmal so gut.
Feuchte Keller, edler Schimmel – perfektes Klima für Käse. Hat ein Hartkäse in seine runde Form und sein „Kampfgewicht“ von 15, 50 oder 120 Kilogramm gefunden, geht es an die Feinheiten. Das heißt, es geht hinein in einen möglichst feuchten Keller: 90 Prozent Luftfeuchte sind ideal für die Reifung des Käses. Je nach Sorte wird hier jeder Laib gewaschen oder mit Salz geschmiert – mindestens drei Monate lang, für die würzigen Exemplare gerne auch drei Jahre und mehr. Käseaffineure erweitern die Aromenvielfalt zuweilen mit einer Umhüllung aus Kräutern, Rotwein und sogar Asche oder „impfen“ die Laibe mit Edelschimmel. Im urigen Käsekeller im Busche Berta-Haus etwa lagern solche verfeinerten Sorten, die bei einer Verkostung eine
enorme Bandbreite an Geschmack offenbaren. Zur runden Sache wird Geschmack in den Hörnerdörfern vor allem deshalb, weil die Qualität stimmt, weil während allen Schritten – von der Kuh bis zum Käsehäppchen – darauf geachtet wird. Bei experimentierfreudig verfeinertem Käse genauso wie bei den beliebten Allgäuer Klassikern.

63


64


... mir
... mir
... bei is
gsea
Authentisch HERZLICHKEIT So wie wir sind Unsere Gastfreundschaft Urtypen GEMÜTLICH Hilfsbereit BODENSTÄNDIG LIEBENSWERT Mit Ecken und Kanten 65
sind stolz uf isa Huimat
lached gean
isch jeda gean
Grieß Di
Ankommen im Zuhausegefühl. Der erste Eindruck: Geborgenheit. Man findet Muße für sich, für das Wesentliche. Ohne Aufregung, ganz natürlich, mit Genuss. „Huimat“ der Allgäuer Berge erleben, eine Heimat fürs Herz.








66







67
Alphornblasen auf dem Ofterschwanger Horn
Fasching

LebendigeOsterbräucheimAllgäu

Funkenfeuer DemWinterFeueruntermHinternmachen


Kirchenfeste und Berggottesdienste


Kulturzeit
Das heißt Kunst, Kabarett und Konzert in allen Varianten. Seien es Altmeister oder Newcomer, große Namen des Allgäus oder Künstler aus der großen, weiten Welt – Fischen bereitet hochkarätigem Kulturgenuss eine Bühne.







Themenführungen
Helau und Alaaf! Auf in die fünfte Jahreszeit!
2
Käse- & Handwerkermarkt
Tage Leibspeis, Ohrenschmaus & Kinderlachen
68
Steinzeitdorf, Obermühle-Säge, Ortsführungen
Blasmusik Tradition&Heimatliebe



Alte Zeiten erleben
Waldfeste & Heimatabende



Olympischer Goldregen funkelt, ein über 500jähriges Mühlenrad klappert und im historischen Hofkeller duftet der Schinken: bei Streifzügen durch das FIS-Skimuseum, die Obermühle Säge oder das Bauernhaus „Busche Berta“ wirkt Geschichte auf alle Sinne.
Viel los
in den Hörnerdörfern
Im Winter draußen feiern

Beim Winterfest, in der Schmolzbar oder vor der EisOase wird einem auch bei eisigen Temperaturen warm ums Herz – man trifft sich spontan und ungezwungen, genießt heißen Glühwein und Punsch und tauscht die Erlebnisse erfüllter Wintertage aus.
Klausentreiben
Mit Schellen und Gebrüll Dämonen vertreiben
69
So feiern die Hörnerdörfer ihre Heimat
Lindau mitseinemHafen,nur70kmentfernt

Skywalk AllgäuBaumwipfelpfad in Scheidegg, nur 59km entfernt


WonnemarSonthofen ErlebnisbadmitSpa&Saunen,nur7

Bodensee mit der Blumeninsel Mainau, nur 95km entfernt



Ottobeuren






Benediktinerabtei und Basilika, nur 65km entfernt
mit Skiflugschanze & -sprungstadion, nur 7km entfernt
70
nurmitDeutschlandslängsterGanzjahresrodelbahn, 20kmentfernt







Erzgruben am Grünten Bergerlebnis der besonderen Art, nur 15km entfernt
Allgäu Noch mehr

TiefsteFelsenschluchtMitteleuropas, nur10kmentfernt

Neuschwanstein & Hohenschwangau, km entfernt


Kempten DeutschlandsältesteStadtmit
CambodunumPark,nur35kmentfernt
71
Allgäu-Walser-Card (AWC)



Ihre Gästekarte
Noch mehr Urlaub genießen
… mit Ihrer Gästekarte, der „Allgäu-Walser-Card“ der Hörnerdörfer (H-AWC). Profitieren Sie von zahlreichen
kostenlosen Leistungen, wie z.B. Fischinger Heimathaus mit FIS-Skimuseum Werkstattbesichtigung in der Sattlerei Vogler in Bolsterlang Parken in Fischen, Park & Ride Parkplatz Erlebnis- & Familienbad Fischen (Ende Mai – Mitte Sept.) Erlebnis- und Freibad Hittisau (Österreich; nur für Gäste aus Balderschwang)
Entdecker-Pass der Hörnerdörfer Besuch des Steinzeitdorfs mit Abenteuerweg, Bolsterlang (Juni – Oktober) Höhen-Grenzlandloipe Balderschwang-Hittisau Loipen in Fischen, Bolsterlang, Obermaiselstein, Ofterschwang Schlittschuhfahren/Eisstockschießen am Natureisplatz in Fischen-Au (je nach Witterung) Nutzung der Familien-Skilifte am Stinesser (tagsüber, nur für Gäste aus Fischen) Nutzung von Wander- und Skibussen auf bestimmten Linien (Infos der jeweiligen Gästeinformationen)
Allgäu VIELcard Einfach aufbuchen
vergünstigten Leistungen, Sturmannshöhle Obermaiselstein Golf-Schnupperkurs auf dem Golfplatz Oberallgäu Kutschfahrten Ermäßigte Fahrten mit der Hörnerbahn Bolsterlang und dem Weltcup-Express Ofterschwang und den Bergbahnen Oberstdorf/Kleinwalsertal Ermäßigter Eintritt bei vielen Freizeiteinrichtungen und Veranstaltungen Schneeschuh- oder Fackelwanderungen (Winter) ÖPNV-Ticket für 4, 7 oder 14 Tage Kartenmaterial der Hörnerdörfer (Wandern)
Mit der Entrichtung des Kurbeitrages erhalten Sie Ihre AllgäuWalser-Card direkt bei der Anreise von Ihrem Gastgeber gegen eine Pfandgebühr, die bei Rückgabe der Karte erstattet wird. Die elektronische Gästekarte ist im Oberallgäu, Kleinwalsertal und Westallgäu gültig.
Entdecken Sie die Vielfalt des Allgäus und genießen Sie mit der VIELcard abwechslungsreichen Urlaubsspaß in über 70 Freizeitattraktionen im gesamten Allgäu und Kleinwalsertal. Sie erhalten die VIELcard bereits ab 54,90 € (gültig für 4 Tage) und können damit je einmal pro Gültigkeitsdauer die Freizeiteinrichtungen kostenlos nutzen. Buchen Sie die VIELcard einfach auf Ihre Allgäu-Walser-Card auf und freuen Sie sich auf mehr Urlaubsvergnügen.
StandMai2022. Änderungenvorbehalten. ErwachseneabJg.2007,KinderundJugendlicheJg.2008-2017,KleinkindbisJg.2018
72
V R VIELcard Preisübersicht 4Tage7Tage14Tage Erwachsene 54,90€74,90€89,90€ Kinder&Jugendliche29,90€39,90€49,90€ Abdem2.Kind 9,90€ 9,90€ 9,90€ Kleinkind gratis gratis gratis
So finden Sie sich leicht zurecht
Die Sortierung der Anzeigen innerhalb des Ortes erfolgt wie hier aufgelistet:
1. Betriebsart
– Hotel
– Gasthof
– Pension/Gästehaus/Ferienzimmer
– Ferienwohnung/Ferienhaus
– Campingplatz, Hütte
Achten Sie bitte auch auf den oberen Rand am Kopf jeder Anzeigenseite. Hier ist nochmals vermerkt, welche Betriebsart Sie auf dieser Seite finden.
Ferienwohnungen und Ferienzimmer werden zum Teil auch von Hotels, Gästehäusern und Bauernhöfen angeboten. Es lohnt sich also ein Blick auf alle Angebote.
2. Klassifizierung absteigend (Bitte beachten Sie, dass die Betriebe erst als klassifiziert bewertet werden, sobald mehr als 50% der Wohneinheiten klassifiziert wurden)
3. Anzeigengröße absteigend
4. Hausname nach Alphabet aufsteigend
Planquadrat/Lageplan
Wenn Sie die Lage Ihres Gastgebers noch genauer bestimmen möchten, verwenden Sie die PlanquadratBezeichnung rechts oben im farbigen Balken der Anzeige. Den Lageplan des jeweiligen Ortes finden Sie immer nach dem Ortseinstieg. Anhand der Quadrate können Sie nun das Segment feststellen, in
dem sich Ihr Gastgeber befindet.
Piktogramme Bildsymbole, die für ein bestimmtes Ausstattungsmerkmal stehen. Sie liefern eine schnelle Angebotsübersicht des Gastgebers und stehen am unteren Rand jeder Bildanzeige. Damit Sie mit den Symbolen schnell vertraut werden, finden Sie auf der Umschlagseite hinten eine Auflistung aller Zeichen mit Erklärung.
Preis Die angebotenen Übernachtungspreise sind Richtpreise pro Tag bei der angegebenen Personenzahl inkl. MwSt. und Nebenkosten für Leistungen wie Heizung, Strom, Wasser und Endreinigung. Der Kurbeitrag wird separat berechnet und ist in den Preisangaben nicht enthalten – es sei denn, es ist explizit erwähnt. Das Übernachtungsangebot der Hörnerdörfer-Gastgeber stellt lediglich eine Angebots- bzw. Leistungsübersicht dar. Ein konkretes Preis-Leistungsangebot erhalten Sie von Ihrem Gastgeber.
Gastaufnahmebedingungen ab
Seite 136.
Klassifizierung
Viele Gastgeber garantieren Ihnen Sternequalität. Diese Vermieter haben an den offiziellen, bundesweit einheitlichen Klassifizierungsverfahren für ...
• Hotels (a bis aaaaa) DEHOGA
• Pensionen (Ga bis aaa) DEHOGA
• Ferienzimmer (bis 8 Betten) (FZb bis bbbb) DTV
• Ferienwohnungen (Fb bis bbbbb) DTV
... teilgenommen. (Stand 2022)
Kurbezirk I
Ermäßigter Kurbeitrag
*KurbeitragsBefreiung
Bitte beachten Sie, dass die Tourismus Hörnerdörfer GmbH nur als Mittler zwischen Ihnen und dem Gastgeber auftritt. Sie haftet deshalb nicht für Leistungsmängel oder nicht eingehaltene Zusagen. Für die Angaben in den Anzeigen ist der Vermieter verantwortlich.
Haftung
Die Sterne finden Sie im Kopfbalken der Anzeige hinter dem Hausnamen. Gastgeber ohne Sterne haben sich diesem freiwilligen Klassifizierungsverfahren nicht unterzogen. Das Fehlen der Sterne sagt jedoch nichts über die Qualität des Angebotes aus. Weitere Informationen s. Seite 107.
Kurbeiträge in der Übersicht
In den Hörnerdörfern gibt es, bedingt durch die Größe der Orte und die Zahl der Einwohner, ein unterschiedliches Infrastrukturangebot. Bitte beachten Sie, dass eine Kurbeitragsbefreiung* nur nach erfolgter Antragstellung in der jeweiligen Gästeinformation erfolgen kann. Der Kurbeitrag gilt pro Person und Nacht.
FischenBolsterlang ObermaiselsteinBalderschwangOfterschwang
Ab 15. Januar 2023
ab Vollendung des 14. Lebensjahres € 3,20 (ab 14 Jahren)
ab Vollendung des 6. Lebensjahres € 1,60 (6-13 Jahre)
Kinder bis zur Vollendung des 6. Lebensjahres (bis 5 Jahre) sind beitragsfrei
Ab 1. Dezember 2022
ab Vollendung des 14. Lebensjahres € 2,50 (ab14 Jahren)
Kinder bis zur Vollendung des 14. Lebensjahres sind beitragsfrei (bis 13 Jahre)
_von Anfang Nov. bis Mitte Dez. 50% Ermäßigung
Ab 1. Dezember 2022
ab Vollendung des 14. Lebensjahres € 2,50 (ab14 Jahren)
Kinder bis zur Vollendung des 14. Lebensjahres sind beitragsfrei (bis 13 Jahre)
von Anfang Nov. bis Mitte Dez. 50% Ermäßigung
Ab 1. Dezember 2022
ab Vollendung des 14. Lebensjahres € 2,00 (ab 14 Jahren)
Kinder bis zur Vollendung des 14. Lebensjahres sind beitragsfrei (bis 13 Jahre)
Ab 1. Dezember 2022
ab Vollendung des 14. Lebensjahres € 1,50 (ab 14 Jahren)
Kinder bis zur Vollendung des 14. Lebensjahres sind beitragsfrei (bis 13 Jahre)
Geschäftsreisende sind vom Kurbeitrag befreit (somit besteht kein Anspruch auf die Leistungen der Allgäu-Walser-Card). Nachweis erforderlich. Gäste mit nachweisbarem Behinderungsgrad ab 80% sowie deren offizielle Begleitperson (eingetragenes „B“) sind kurbeitragsfrei (bei Vorlage des Originalausweises).
73
Ihre Gastgeber im Überblick
In dieser Liste finden Sie alle Gastgeber, die im Anzeigenteil vertreten sind, sortiert nach Ort und Hausname. Hinter dem Hausnamen finden Sie die Betriebsart. Die Betriebsarten sind jeweils mit einem Symbol dargestellt: Hotel Gasthof Pension/Gästehaus/ Ferienzimmer Ferienwohnung/Ferienhaus Hütte Wohnmobilstellplatz
Einige Häuser sind mit einem Stern gekennzeichnet. Dieser gibt an, dass das Haus über eine freiwillige Klassifizierung verfügt:
Hotel-Klassifizierung nachDEHOGA Ferienwohnung-Klassifizierung nachDTV
Die Anzahl der vergebenen Sterne finden Sie in der jeweiligen Gastgeber-Anzeige. Die entsprechende Anzeigenseite finden Sie in der nachfolgenden Liste.
Weitere Infos zu Betriebsarten und den Klassifizierungen finden Sie auf der Seite 107.
Gastgeber Betriebsart SeiteGastgeber Betriebsart Seite
Fischen Aigner, Stefanie Köcheler 87 Aigner-Vogler, Andrea Aigner-Vogler 87 Alexa, Alexandra Huber und Brunhilde Epp 85 Allgäublick, Nicole Aigner 88
Allgäuer Bergblick, Marita und Rogart Burger 90 Allgäuer Landhaus, Anette Pannier-Dippon 91 Allgäulodge, Oliver Pillmeier 90 Alpenblick, Karlheinz Knöbel 82 Alpenflora, Paula Ruppaner 93 Alpenglühen, Anita Denz 93 Alpenliebe, Sabine und Jürgen Ley 89 Alpenruh, Renate Vogler 93 Alpenwiesle, Doris Michaely 88 Althaus, Toni und Kerstin Althaus 88 Andrea, Familie Mayr 93 Andrea, Josef Ochsenreiter 88 Angelika, Thomas Greiter 84
Anger, Roswitha Müller 93 Ankenbrand, Markus Ankenbrand 94 Anna, Bärbel Sauter 88 Anna, Birgit Paluka 94 Anne, Anne Ratzki 94 Anneliese, Michael Schmid 94 Arnika, Gabi Jacobs 90 Atelierhaus, Rosl Spatschil 94
Auffenberg, Michael Reiß 88 Bader, Eva und Hans Bader 94 Beim Schlossar, Hubert Müller 94 Bergland, Rosemarie Jocham 94 Bergsicht, Anton Müller 94 Besler, Anton Besler 94 Bollwein, Florian Bollwein 90 Bollwein, Sonja Schuster 94 Borg, Ingeborg van der Borg 88 Brecheisen, Hubert Brecheisen 94 Brutscher, Petra Neß 89 Burger, Marianne Ethner 84 Burgfrieden, Martin Freisl 88 Burgmühle, Markus Reinheimer 82 Carola, Carola Schmid 90 Dorle-Ruppaner, Otto und Dorle Ruppaner 87 Dornröschen, Beate Eberle 95 Eberle, Alois Eberle 84 Eggensberger. Andreas Fischer 88 Enzian, Marion und Lars Kielhorn 91 Finkel, Christine Kling 90 Fischer, Andreas Fischer 88
Flora & Fauna, Charivari Ferienwohnungen 93 FreiRaum, Martin Schmidbauer 86 Freisl, Monika Lingemann 95 Füß, Gerhard Füß 86 Gaisalpe, Manuela Buchenberg 95
74
Gastgeber Betriebsart SeiteGastgeber Betriebsart SeiteGastgeber Betriebsart Seite
Gaisbock - Der DorfUrlaub, Familie Schöll 87
Gaisbock - Der Ferienhof, Anton Schöll 85
Gschwender, Barbara Gschwender 84 Hartmann, Alois Hartmann 95 Häusler, Renate und Manfred Häusler 95 Heinz, Zenzi Heinz 95 Hilbrand, Agathe Hilbrand 95 Holzer, Anna Holzer 88 Ideal, Charivari Ferienwohnungen 95 Julia, Albert Milz 84
Kannler, Peter Kannler 84 Kaserer, Ute Lechner und Steffen Orben 82 Käshütte, Hans-Peter Schmid 95 Katrin, Heidrun Mayr 95 Keller, Familie Simon 95 Keller, Franz Keller 88 Koch, Leonhard Koch 89
Koros, Peter Koros 95 Lang, Sigrid Lang 96 Linder, Benian Linder 85
Litzinger, Irma Litzinger 85 Lorenz, Helmut Lorenz 90
Luitz-Kennerknecht, Jörg Kennerknecht 85
Lydia, Antonie Schmidt 96
Malerwinkel, Josef Müller-Zeller 89 Martin, Maria Martin 87 Mayer, Nicole und Franz Mayer 89 Meßmang, Hans Meßmang 96 Miller, Veronika Miller 83 Mock, Angelika Mock 96 Müller, Ellen Müller 93 Müller, Marlies Müller 89
Neß, Hannelore Neß 89 Nicole, Kurt und Beate Mayer 96 Nicole, Nicole und Franz Mayer 90 Panorama, Bianca Dörfel 92
Panoramablick, Marita Birzele 93 Reiser, Birgit und Hans Schwärzler 92 Ruppaner, Hannelore Ruppaner 96 Ruppaner, Max Ruppaner 86 Sauter, Martin Sauter 96 Schmid, Kristina Schmid 89 Schmid, Lothar Schmid 83 Schmid, Marianne Schmid 83 Schmid, Regina Schmid 96 Schmidbauer, Gabi Schmidbauer 86 Schöll, Georg Besler 96 Schratt, Florian Schratt 96 Schratt, Hermine Schratt 96 Schroth, Sieglinde Schroth 96 Schwarz, Magdalena Schwarz 97
Seitz, Anita Seitz 89
Sonnenbergle, Charivari Ferienwohnungen 92
Sonnenbergle, Hans Steinbrenner 97
Sonnenbichl, Familie Scheuerl 82
Sonnengrund, Uwe Mayer 83
Sonnenkopf, Peter Holderried 83 Speigl, Florian Speigl 97
Spiß, Andreas Spiß 89
Trettachblick, Rita Damaschun 97

Vogler, Andreas Vogler 90 Vogler, Loni Vogler 86 Vogler, Marianne und Toni Vogler 97 Vogler, Martina Vogler 97
Waldhäusle, Birgit Hiltensberger 89 Walther, Andreas Walther 84 Weitnauer, Jutta Weitnauer 85 Wiesenhof, Beate Geduld-Salzer 84
75
Ofterschwang
Alpenrose, Klaus Finkel 102 Alphorn, Familie Pöschl 102
Am Mühlbach, Cornelia Pohl 102 Auffinger, Ludwig Auffinger 103 Bergblick Lodge, Carola Sowa 103 Bergblick, Margit Deschler 104 Bietsch, Herbert Bietsch 104 Blick in die Berge, Matthias Christoffel 104
Casa Montana, Alexander Prey 103 Chalet F, K. u. F. Fässler 104 Eberle, Sieglinde Eberle 103 Edelweiß, Caroline Schwarz 104 Elfriede, Herbert Socher 102 Engel, Thomas Tröbelsperger 102 Fahnen, Heike und Thomas Schneider 103 Fröhlich, Rainer Fröhlich 103 Haberstock, Alois Haberstock 102 Hartl, Anita und Alfons Hartl 104 Horizont, Silke Busch 104 Hörnerblick, Familie Michael Schmid 102 Inta, Josef Fröhlich 104 Kanstein, Albert Barth 102 Kim, Iris Roscher 104
Kogel, Karin und Dirk-Alexander Kogel 104 Kräuterhof Bächle-Waibel, Waltraud Bächle-Waibel 104 Kuckucksnest, Ute Weiglein-Gilitzer 105 Mayrhof, Herbert Mayr 103 Mooswiese, Gisela u. Anton Greif 105 Müller, Josef Müller 103 Schmid, Andreas Schmid 105 Schneider, Andreas Schneider 105 Talblick, Andrea Socher-Brutscher 105 Wechs, Gudrun Frey-Wechs und Cornelia Wechs-Schenker 103
Obermaiselstein
Adelinde, Franziska Wagner 112
Alpen-Glühen, Rosmarie Berwanger 113 Alpenrose, Silvia Feldengut 112 Alpina, Ulrich Heidekorn 113
Auszeit, Martin Maier 112 Barbara, Kerstin Knabenbauer 114 Beccara, Gabriele Beccara 114
Bergblick, Anneliese und Ludwig Brutscher 112 Berwanger Hof, Familie Berwanger 112 Buhl, Centa Buhl 114 Buhmann, Stefan Buhmann 114 Caser, Ingo Wolf 113 Christine, Claudia Schneider 112 Dornach, Manfred Dornach 114 Forelle, Günther Hafner 112 Gamseck, Hans-Christian und Sylvia Jordan 114 Geg, Marietta Geg 114 Gerling, Tilly Gerling 114 Hartmann, Tanja Reisacher 115 Haselberger, Emil Haselberger 115 Irmgard, Irmgard Rain 115 Jordan, Georg und Gabi Jordan 115 Kennerknecht, Alexander Steiner 115

Kleine Pension, Michaela Pinn 115 Kling, Armin Kling 115 Köberle-Bietsch, Christine Bietsch 115
Koch, Anne Koch 112
Kuhn, Marion und Adolf Kuhn 112 Lenzenberghütte, Stephan Sachs 116 Maier, Xaver Maier 116 Maringga, Carola und Rainer Konietzke 113 Milena, Anton Cop 116 Natterer, Thomas Natterer 116 Pechlaner, Stephan Pechlaner 116 Romantik pur, Susanne und Hans-Joachim Kümmerle 113 Rubihornblick, Helmut Eller 113 Schmid, Schmid & Wiedemann 113 Schmid, Rosel Schmid 112 Schwarzenberg, Klaus Lohmüller 116 Sonnenstrahl, Annegret Sperl 116 Steinweg, Tanja Schneider 116 Stetter, Michael Stetter 113 Stöhr, Achim und Birgit Stöhr 113 Ücker, Andrea und Walter Ücker 116 Walk, Elmar Walk 116
76
Gastgeber Betriebsart SeiteGastgeberSeiteGastgeber Betriebsart Seite
Bolsterlang
Gastgeber Betriebsart Seite
Almlisl, Charivari Ferienwohnungen 124
Alpenflora, Erika Seider 123
Alpensonne, Marie-Luise Kaserer 123
Alpina, Christof Endreß 125
Arnika, Günter Müller und Birgit Müller-Salathé 125
Bächle, Manfred Vachenauer 125 Bachtelmühle, Markus Mühlegg 123
Bergidyll, Charivari Ferienwohnungen 124
Bergkristall, Jörg Vogel 125
Biohof Burger, Martina und Albert Burger 123 Brigitte, Brigitte Papst 125
Charivari Landhaus, Charivari Ferienwohnungen 124
Dreimädelhaus, Siegfried Feldengut 123 Eberle, Bernhard Eberle 125 Exclusiv, Friederike Sauter 123
Exquisit, Manfred Engelbart 122 Ferienglück, Wolfgang Kaecke 125 Gänseliesl, Maximilian Renn 125 Goldener Apfel, Christa Korte 124 Hansbader, Franz und Sabine Natterer 125 Hartmann, Waltraud Hartmann 125 Himmelwies, Charivari Ferienwohnungen 125 Hornblick, Manuela und Alfons Schaidnagl 122 Kapellenblick, Steffi Hartmann 126
Lacher, Ludwig Lacher 126 Martin, Ruth Dornach 123
Martin, Willi Martin 126
Natterer, Hans-Peter Natterer 126 Nehring, Christian Nehring 126
Gastgeber Betriebsart Seite
Neuhauser, Claudia Neuhauser 126 Panorama, Christine und Lorenz Weber 122 Rapp, Christa Rapp 126 Renn, Angelika Renn 126 Riedbergerhorn, Familie Kobler 126 Schmid, Karlheinz Schmid 126 Schmidt, Christoph Schmidt 126 Schöll, Gebhard Schöll 126 Schönblick, Friedrich Ebert 122 Sichler, Monika Sichler 127 Silberdistel, Timo Zebisch 122 Sonnenberg, Richard Seider 123 Tannheimer, Elfriede Tannheimer 127
Vintage-Hotel Charivari, Charivari Ferienwohnungen 122 Vogler, Bianca Vogler 127 Vogler, Rudolf und Brigitte Vogler 127 Wucherer, Josef Wucherer 127
Balderschwang

Gastgeber Betriebsart Seite
Akelei, Wilma und Hubert Hiemer 133 Albinger, Andrea und Robert Knebel 133 Almfrieden, Manfred Heidegger 133 Alpe Berg, Pia und Stefan Steurer 133
Alte Schmiede, Paul Heidegger 133 Anemone, Alfons Bilgeri 133 Anita, Jutta Aschemeier 133
Auerstüble, Theo Schwärzler 133 Bausch, Familie Bausch-Moser 133
Hiemer, Simone und Hans Hiemer 133
Hubertus, Familie Traubel 132 Ifenblick, Bianca Schießl e.K. 132 Ignaz, Erika und Walter Jörg 133 Kienle, Konrad Kienle 132
Oben am Berg, Peter Fischer 134 Rauhbach, Rosa-Maria Lang 134 Säntisblick, Horst Heidegger 133 Schwarzenberg, Christine und Andreas Martin 134

Siplinger Suites, Andreas und Stephanie Holzmann 134
Torgheleʼs Wald & Fluh, Familie Torghele 132 Waldeck, Peter Kienle 134 Wäldle, Heidi Martin 134 Weber, Karl-Ludwig Weber 134
77
Fischen i. Allgäu
HörnerDörfer


Fischen, im weiten Illertal, könnte einem Bilderbuch entstammen. Stillromantische Wege führen durch Auwälder und auf sonnige Hügelplateaus, mit grandioser Aussicht auf die Allgäuer Bergriesen. Hier die historische Sägemühle, dort der Weidachwald mit seinen Eichhörnchen, gegenüber die neue Erlebnis-Golf Anlage, der malerische Auwaldsee oder das erfrischende Erlebnisfreibad – schöne Ziele für Spaziergänge sind schnell gefunden. Fischen vereint Naturgenuss mit einem erlesenen Kulturangebot. Und während des Bummels durch die Läden und den Kurpark, verführt das gastronomische Angebot zu ausgedehnten Pausen.
Der Bewegungsradius ist auch im Winter nicht eingeschränkt, denn präparierte Winterwanderwege und ein vielfältiges Loipennetz bahnen Wege durch das Winterweiß. Am Stinesser Dorflift üben die Kleinsten erste Schwünge und im FIS-Skimuseum bewundert man das Gold der ganz Großen. Zwischen seinen sieben Weilern entfaltet Fischen ein charmantes Flair, bestehend aus klarer Luft, allgegenwärtigem Bergblick und inspirierender Ruhe.
78
im NaturDorf Aufatmen








Erlebnis-Golf-Anlage im Weidach Tief durchatmen im Auwald Historische Obermühle-Säge Skigebiet direkt im Dorf Kräutergarten im Kurpark Ausgelassenheit im Freibad 79





































































































































































































ORTSPLAN FISCHEN 80

81
Kath. Pfarrkirche St. Verena
Auf der Insel 2 - 4 · 87538 Fischen Tel. 08326 9950 · Fax 7352 info@parkhotel-burgmuehle.de · www.parkhotel-burgmuehle.de
Die Wellnessinsel in den Bergen

Im Naturparadies des Allgäus bietet die Burgmühle Mehrwert in Hülle und Fülle: ausgezeichnete Premium-Wellness, eine exzellente Gourmet-Küche, edelalpine Bergblicksuiten sowie kurze Wege zu den Highlights der Allgäuer Alpen. Von der Golfpartie mit Bergblick bis hin zur entspannten Fahrt ins Gipfelpanorama. Anschließend lassen Sie sich in unserem 2000 m2 Wellnessbereich verwöhnen.


Wir freuen uns auf Ihren Besuch. Familie Reinheimer
Preis auf Anfrage
cmnwIa gb235f
Sonnenbichl, Hotel am Rotfischbach aaaa C4
Freuen Sie sich auf Wohlfühlurlaub in den Alpen. Wellnesswohnen in modernem Design und lebendigem Ambiente. Entspannen im Vitaldörfle: Hallenbad, Massagen, Dampfbad, Sauna und InfrarotKabine, Ayurveda, Kosmetik und viel Platz zum Relaxen im Freien. Genießen Sie im Restaurant und auf der Terrasse unsere GourmetKüche mit heimischen Schmankerln. Zum Tagesausklang: Treffpunkt Wintergarten mit offenemKamin.Wirfreuenunsauf Ihren Besuch!


9 EZ, 40 DZ
Preis auf Anfrage
chmnosbq
Hotel Alpenblick aaaSuperior
C2
Maderhalmer Weg 10 87538 Fischen Tel. 08326 9791 · Fax 9794 info@hotel-alpenblick.de www.hotel-alpenblick.de
cimwIgb3q
Schönsten Alpenblick genießen Sie von unserem familiengeführten Hotel auf die Berge. Unsere Gästezimmer, Appartements & Suiten sowie FeWos bieten für jeden das ideale Urlaubs-Zuhause. Wanderer, Radfahrer, Familien und Wintersportler finden bei uns den zentralen Ausgangspunkt. Wir verwöhnen Sie in unserem Restaurant/Café mit unserer abwechslungsreichen Halbpension oder à la carte. Entspannung finden Sie in unserem kleinen Wellnessbereich.
19898
10 DZ, 6 MBZ, 8 App./Suiten, 35-40 qm, 2-5 Pers. DZ mit HP € 72,- bis 113,- p. P.
Ute Lechner und Steffen Orben GbR
Gundelsberger Weg 7 · 87538 Fischen Tel. 08326 36040 · Fax 360460 · hotel-kaserer@t-online.de steffen.orben@t-online.de · www.hotel-kaserer.de
...für unbeschwerte Ferien... besuchen Sie unser familiär geführtes Haus in ruhiger Ortsrandlage. Herrlicher Ausblick auf die Allgäuer Hochalpen. Geräumige, behagliche Einzel- u. Doppelzimmer oder Familien-Appartements
• reichhaltiges Frühstücksbuffet
• NEU: Halbpension buchbar
• Allgäuer Hörnerbahnen gratis. (Mai-Okt.)
• Kaffee und Kuchen, Brotzeiten
• gemütl. Stube, Panorama-Terrasse, Liegewiese
• kleiner Fitnessraum, Tischtennis
• kostenloser Fahrradverleih
• Internet-PC, W-LAN kostenfrei
• NEU: Zirbelholzsauna, Infrarotkabine
• Massagen gegen Aufpreis
Parkhotel Burgmühle aaaaSuperior
Markus Reinheimer
14467 B3
Hotel Sonnenbichl GmbH & Co. KG Familie Scheuerl · Sägestraße 19 87538 Fischen-Langenwang Tel. 08326 994-0 · Fax 994-180 info@hotel-sonnenbichl.com www.hotel-sonnenbichl.com
Karlheinz Knöbel
Panorama-Hotel Kaserer aaa
cimwxb Ir4q5s 4 EZ, 11 DZ, 6 MBZ ÜF € 59,- bis 80,zubuchbare HP € 18,19901 C2 82 Fischen HOTEL
Alpengasthof Sonnenkopf
Sonnige Ortsrandlage, 15 Gehmin. von Fischen, DZ mit Du/WC, TV, Balkon mit Bergblick. Frühstücksbuffet, Große FeWo. Gutbürgerliche Küche.
Peter Holderried
Winkelstraße 2 · 87538 FischenOberthalhofen · Tel. 08326 628 karin.holderried@freenet.de www.alpengasthof-sonnenkopf.de
23976 chimxyrq
2 EZ, 8 DZ · 1 FeWo, 65 qm, 2-4 Pers. ÜF € 28,- bis 41,- / FeWo € 53,- bis 60,- (2 Pers.) / je w. Pers. ab € 15,-
Gästehaus Schmid
Hotel Landhaus Schmid · Lothar Schmid
Weiler 12 · 87538 Fischen Tel. 08326 385969-0 · Fax 8380 info@landhaus-schmid.de · www.Landhaus-Schmid.de
• alle Zimmer mit Balkon, Flachbildschirm, Kühlschrank und kostenlosem WLAN
• großes Frühstücksbuffet
• Getränke und Speiseangebot
• schöne Sonnenterrasse und Liegewiese
• kostenloser Wellnessbereich mit Infrarotkabine/Whirlpool/Sauna
Wir freuen uns darauf, Sie als Gast bei uns begrüßen zu dürfen. Ihre Familie Schmid
Herzlich willkommen! Gepflegtes & gemütl. Gästehaus in ruhiger, sonniger Lage mit Bergblick. Teeküche, Frühstücksraum, Abholservice am Bahnhof.
Gästehaus Miller
B3
Gepflegtes Landhaus in ruhiger Lage mit freiem Bergblick, 5 Minuten zum Zentrum. Schöne DZ zum Teil auch als EZ mit Du/WC, TV und Balkon. 1 Zimmer mit Etagendusche und TV, gemütlicher Aufenthaltsraum, reichhaltiges Frühstück.
19793
Veronika Miller
19806 ckmhvxIq
Marianne Schmid
Mühlenstraße 22 87538 Fischen Tel. 08326 248 gaestehaus-miller@gmx.de
3 DZ
ÜF € 58,- bis 70,- (2 Pers.)
Gästehaus Pension Sonnengrund
2 FeWos mit separatem Schlafzimmer, auf Wunsch mit Brötchenservice. Nähe Freibad, Sportpark, Skilift und Loipe. Parkplatz, Liegewiese. Kostenfreies W-LAN. Ganz einfach den Hausprospekt bestellen.
2 FeWos, 50 qm, 1-4 Pers. ÜF € 17,50 bis 30,FeWo € 45,- bis 75,(1-4 Pers.)Preise zzgl. Kurtaxe
Uwe Mayer
Haus in zentraler, ruhiger Seitenstraße. Alle Zimmer mit Du/WC, TV mit Sitzecke, Balkon mit herrlichem Blick auf die Allgäuer Alpen. Große Liegewiese, Terrasse, Sauna. Reichhaltiges Frühstücksbuffet, Getränke im Aufenthaltsraum erhältlich. Parkplatz am Haus.

In der Vor- und Nachsaison Sonderpreise auf Anfrage oder im Internet!
h cmnvbq 2 EZ, 3 DZ, 5 MBZ ÜF € 36,- bis 58,- pro Person 19855 B2 83 Fischen HOTEL · GASTHOF · PENSION/GÄSTEHAUS/FERIENZIMMER





 Hotel Landhaus Schmid
Hotel Landhaus Schmid
ovwxIg
ÜF
FeWo
19893 C1
ce1hmn
1 EZ, 10 DZ, 4 MBZ, 6 FeWos, 30-60 qm, 2-6 Pers.
€ 55,- bis 75,- (p. Pers.)
€ 84,- bis 104,- (2 Pers.) Je w. Pers. € 14,- / Frühstücksbuffet € 14,-
A1
Zum Tannacker 9 · 87538 Fischen Tel. 08326 3849741 · Fax 381840 info@gaestehaus-schmid.com www.gaestehaus-schmid.com FZ BBB C2
hilmsxIr
2 EZ, 4 DZ
Grüntenstraße 5 · 87538 Fischen Tel. 08326 7235 · Fax 8210 · info@pension-sonnengrund.de www.pension-sonnengrund.de
Beate Geduld-Salzer
Weilerstraße 42 87538 Fischen Tel. 08326 8395 · Fax 8135 wiesenhof-fischen@t-online.de www.wiesenhof-fischen.de
„Herzlich willkommen“ in unserem familiär geführten Gästehaus.
• Ruhige Ortsrandlage, 10 Gehminuten vom Ortskern
• Parkplätze direkt vorm Haus
• reichhaltiges Frühstücksbuffet
• gemütlich einger. Zimmer mit Du/WC, verstellbare Betten, SatTV, z. T. Balkon/Terrasse
• 2-Raum FeWo für 2-4 Pers., Flach-Bildschirm, Du/WC, Balkon, Frühstück zubuchbar
• traumhafter Bergblick
• Gästeküche,Kühlschrank, Mikrowelle, Getränkeautomat
• W-LAN kostenlos
• Nichtraucher
• keine Tiere
1 EZ, 4 DZ, 2 FeWo, 45 qm ÜF € 45,- bis 55,- (p. Pers.) FeWo € 80,- bis 90,- (2 Pers.)
Gästehaus Gschwender
Ornachstraße
· 87538
Tel. 08326 563 · Fax 385399 info@pension-walther.de · www.pension-walther.de

Unser modernes, zentral gelegenes Haus mit gemütl. Aufenthaltsräumen, Fernsehraum und rustikaler Pilsstube bietet Ihnen alles, was man von einem erholsamen Urlaub erwartet. Gut bis erstklassig ausgestattete Zimmer, Appartements m. KabelTVAnschluss und SatTV im Zimmer, rustikal einger. Ferienwohnungen bieten Ihnen geruhsame Tage zu günstigen Angeboten in der Vor und Nachsaison. Wir würden uns freuen, auch Sie bald als Gast in unserem Haus begrüßen zu dürfen.
Gemütl. FeWo, Wohnschlafr. m. Kochnische, Du/WC, Südbalkon m. Bergbl. DZ m. Sitzecke, Du/WC, TV. Zentr. ruhige Lage, Parkplatz u. Liegewiese.
Ruhige, sonnige Ortsrandlage. Ein-/ Zweibettzi. Du/WC, Sat-TV-Anschluss und Balkon. Reichhaltiges Frühstück. Parkplätze.TolleWandermöglichkeiten. Nichtraucherhaus.
Gästehaus Angelika D2
Ruhige, freie Ortsrandlage, herrl. Bergblick, gemütl. Aufenthaltsraum, Gästekühlschr., gepfl. FeWos, idealer Ausgangspunkt für Wanderungen und Radtouren.
Thomas Greiter Achweg 41 · 87538 Fischen Tel. 08326 7362
gaestehaus-angelika@oberallgaeu.de www.gaestehaus-angelika.com
eimwxIq
2 EZ, 4 DZ · 2 FeWos, 33-48 qm, 2-4 P. ÜF € 24,50 bis 40,- / FeWo € 49,- bis 59,- (2 Pers.) / je. w. Pers. € 11,-
Landhaus Julia D2
19732
Pension Kannler PENSION/GÄSTEHAUS/FERIENZIMMER






Unser Haus bietet einmaligen Bergblick. DZ mit Balkon, Sat-TV, DU/WC, Frühstück FeWo mit Südterrasse, Wiese, sep. Eingang. Inkl. Endreinigung.

Gepfl. Gästehaus in freier, sonniger Lage. Gemütl. Zimmer mit Du/WC und reichhaltigem Frühstück. Neu errichtete 2-Raum-Ferienwohnung.
Marianne Ethner
Auf der Höh 1a · 87538 Fischen Tel. 08326 663
Gaestehaus-Burger@gmx.de www.Gaestehaus-Burger-Fischen.de
19740 hlmvxIq
6 DZ, 1 FeWo, 42 qm, 2 Pers. ÜF € 50,- bis 66,- (2 Pers.) FeWo € 45,- bis 48,- (2 Pers.)
Gem. Frühstückspension in zentraler Lage. Wanderwege u. Loipe am Haus. 6 DZ, 1 EZ, komf. 2-Raum-Suite mit Himmelbett. Frühstücksbuffet, Terrasse u. Garten.



19773 Fischen
Alois Eberle Ornachstraße 12 87538 Fischen Tel. 08326 7238
landhaus-eberle@t-online.de
19670 hkmnwxIq
1 DZ · 1 FeWo, 45 qm, 2-3 Pers.
ÜF € 25,- / FeWo € 45,- (2 Pers.) je weitere Pers. € 7,-
Barbara Gschwender
Beslerstraße 7 87538 Fischen Tel. 08326 1276
e1hilmnw
2 EZ, 3 DZ · 1 Fewo, 44 qm, 2 Pers.
ÜF € 30,- bis 32,Fewo € 52,- (2 Pers.) inkl. ER
19761
Albert Milz
Beslerstraße 26 · 87538 Fischen Tel. 08326 1013 anfrage@landhaus-julia.info www.landhaus-julia.info
ehikmnxI
2 DZ, 1 FeWo ÜF € 30,- bis 34,FeWo € 70,- bis 90,-
19686
1 EZ, 6 DZ, 1 Suite, 43 qm, 2-3 Pers. ÜF € 40,- bis 47,Suite ÜF € 46,- bis 50,-
Pension Walther
Andrea Walther
ce1hik mvwIq7 2 EZ, 5 DZ, 3 MBZ 4 FeWos, 30-75 qm, 2-4 Pers. ÜF € 44,50 bis 52,- (p. Pers.) / EZ € 47,FeWo € 68,- bis 83,- (2 Pers.) je weitere Pers. € 15,(bis 3 Tage Zuschlag € 5,-) 19895 B2 cekmvwxq 23909 Pension-Gästehaus-FeWo Wiesenhof B1
10
Fischen
Gästehaus Burger C2
Landhaus Eberle B2
C2
chmnvxIr
Peter Kannler · Sägestraße 6 87538 Fischen-Langenwang Tel. 08326 7011 info@Pension-Kannler.de www.Pension-Kannler.de B5 84
Gästehaus Litzinger am Kurpark B3
Gästehaus Luitz-Kennerknecht A2
Gemütliches Gästehaus direkt neben Kurpark + Kurhaus. Wanderwege, Skilifte, sowie Bus und Bahn in der Nähe. Reichhaltiges Frühstück.
Unser Gästehaus befindet sich in ruhiger, sonniger Lage im Ortsteil Au. Zimmer mit Balkon, Du/WC, Sat-TV. Mehr Infos auf unserer Homepage.
Ihre Ruheoase auf der Sonnenseite Fischens! Umgeben von saftig grünen Wiesen liegt Ihr Urlaubszuhause. Wir freuen uns auf Ihre Anfrage!
Traumferienhaus mit Sicht auf die Allgäuer Alpen. 2 moderne luxuriöse FeWos mit Balkon oder Terrasse. Großzügige, separate Schlafzimmer mit sep. Bad/WC. Nähe Golfplatz.




Irma Litzinger
Bahnhofstraße 4 · 87538 Fischen Tel. 08326 7969 · Fax 7969 Gaestehaus.Litzinger@t-online.de
19848 e1hijmvx
1 EZ, 6 DZ, 3 FeWos, 2-4 Pers. ÜF € 34,- bis 37,FeWo € 47,- bis 67,- (2 Pers.)
Jörg Kennerknecht
Am Burgstall 5 · 87538 Fischen Tel. 08326 7980 · Fax 9178 info@luitz-kennerknecht.de www.luitz-kennerknecht.de
himvwxqI
2 EZ, 3 DZ, 3 MBZ ÜF € 30,50 bis 41,-
19783
Frau Jutta Weitnauer
Am Burgstall 12 · 87538 Fischen-Au Tel. 08326 7891 juttab61@web.de www.fischen.de
xhlmnv1q
5 DZ, 2-3 Pers. (ab 3 N.) 2 FeWos, 32-38 qm, 2-3 Pers. (ab 5 N.) ÜF € 41,- bis 52,- / FeWo € 34,- bis 36,-
23839
Familie Anton Schöll
Alexandra Huber u. Brunhilde Epp GbR Weiler 30 · 87538 Fischen-Weiler Tel. +43 676 3087220 info@fewo-alexa.de www.fewo-alexa.de
28991 swIxz35m
4 DZ, 2 FeWos, 97-100 qm, 4-8 Pers. FeWo € 155,- bis 170,- (2 Pers.)
Beslerstraße 22 · 87538 Fischen Tel. 08326 2569330 info@fischen-urlaub.de · www.fischen-urlaub.de


Landleben und Allgäuer Herzlichkeit
Erleben Sie die schönste Zeit des Jahres auf unserem Ferienhof, gelegen am Ortsrand von Fischen und mit traumhaftem Ausblick auf die Allgäuer Bergwelt. Es erwarten Sie sechs voll ausgestattete Wohnungen für 2 bis 7 Pers. mit 4- bis 5-Sterne-Komfort – alle mit Zugang zur Terrasse bzw. zu einem Balkon. Unsere FeWos sind m. schnellem WLan ausgestattet u. in jedem Schlafzimmer finden Sie einen zweiten Fernseher. Ein Grillplatz bietet die Gelegenheit, die anderen Gäste kennen zu lernen, während die Kinder auf dem hauseigenen Spielplatz spielen. Der Ortskern von Fischen ist in ca. 10 Min. fußläufig erreichbar. Dort finden Sie versch. Restaurants in denen Sie den Abend entspannt bei gutem Essen ausklingen lassen können.
Gundelsberger Weg 4 · 87538 Fischen-Berg Tel. 08326 3090326 · info@fewolinder.de www.ferienwohnung-linder.de


Ankommen und wohlfühlen. In unseren exklusiven, komfortablen und allergikerfreundlichen FeWos genießen Sie den Panoramablick auf die Allgäuer Alpen. Ruhig und doch zentral gelegen zu den Bergbahnen, Skigebieten und Freizeitattraktionen.
Erwarten SIE von unseren sehr geräumigen Wohnungen DAS, was Urlaub erholsam macht. Zwei getrennte Schlafzimmer mit Boxspringbetten, moderne Wohnzimmer, sep. Essbereiche, komplett ausgest. Küchen mit Geschirrspüler, Bad und Balkone bzw. Terrasse.
Gästehaus Weitnauer A2
Alexa Ferienwohnungen 2F BBBBB C1
Gaisbock der Ferienhof 3F BBBBB / 3F BBBB
e1ijmxI
6 FeWos, 2-7 Pers. FeWo € 72,- bis 105,- (2 Pers.) je weitere Pers. € 15,19837 C2
rzqwsln
3F
Ferienhaus
Linder 1F BBBBB /
BBBB
Frau Benian Linder
1hijlm nx@Izq 4 FeWos, 52-95 qm, 2-4 Pers. FeWo € 100,- bis 145,- (2 Pers.) ER inkl. / zzgl. Kurtaxe 19692 C2 85 Fischen PENSION/GÄSTEHAUS/FERIENZIMMER · FERIENWOHNUNG
FeWo
Loni Vogler
Altstädter Straße 4 87538 Fischen-Unterthalhofen Tel. 08326 1010
info@loni-vogler.de www.loni-vogler.de
1imosvwq
Das Wohlfühlhaus mit herrlichem Bergblick auf der ruhigen Sonnenseite von Fischen. Komfort-FeWo ingehobenerAusstattungm.liebevollem Ambiente, teils mit Kachelofen. Alle Fewos mit separatem Schlafzimmer, 2 FeWo mit 2 Schlafzimmern und 2 Bädern, Küche jeweils mit Spülmaschine, WLAN,HörnerbahnenvonMai–Okt. gratis, Spielwiese, Ausgangspunkt fürWanderungen,Langlauftouren.
Aktionswochen: 7 Tage wohnen – 5 Tage bezahlen (Zeiträume erfragen Sie direkt beim Gastgeber oder im Web) Vor-/Nachsaison bis -15% 04.03. - 11.03. / 15.04. - 27.05./ 07.10. - 21.10.
6 FeWos, 40-68 qm, 2-4 Pers. FeWo € 64,- bis 79,- (2 Pers.) je w. Pers. € 11,- bis 15,-
19869
Haus FreiRaum
3F BBBBB C4
Genießen Sie Ihren Urlaub in einer unserer 3 neuen, modernen Ferienwohnungen mit eigener Sauna und herrlichem Ausblick.

Martin Schmidbauer
Berger Steige 4d· 87538 Fischen Tel. 08326 3847792 info@hausfreiraum.de www.hausfreiraum.de
hlmwxIbq
3 FeWos, 59-87 qm, 2-4 Pers. FeWo € 110,- bis 175,- (2 Pers.); je weitere Pers. € 25,-
29787
Gepflegtes, familiär geführtes Haus in ruhiger Lage. Komfortable, neu renovierte DZ und FeWos mit Bergblick. Reichhaltiges, vitales Frühstücksbuffet.


Max Ruppaner Achweg 14 · 87538 Fischen Tel. 08326 7776 info@pension-ruppaner.de www.landhaus-ruppaner.de
chmwxIbq
6 DZ · 4 FeWos, 47-62 qm DZ/ÜF € 80,- bis 101,- (2 Pers.) FeWo € 85,- bis 106,- (2 Pers.)
19891
Gabi Schmidbauer Berger Steige 4a · 87538 Fischen Tel. 08326 36120 · Fax 36128
Gabi@Haus-Schmidbauer.de www.Haus-Schmidbauer.de
1imsbwIz
3 FeWos, 54-81 qm, 2-4 Pers. FeWo € 127,- bis 208,- (2 Pers.) je weitere Pers. € 25,-
19868
Freier Eintritt
mit Hörnerdörfer Card
Gerhard Füß
Maderhalm 1 · 87538 Fischen Tel. 08326 38244 · Fax 38245 Landhaus@Fuess.de · www.fuess.de

entspannen – genießen – träumen Gemütliches Landhaus mit einmaligem Panoramablick auf die Allgäuer Alpenkette in freier, ruhiger und sehr sonniger Lage.


• Gepflegte und gemütliche FeWos für 2-4 Personen
• jede FeWo mit Südbalkon oder Südterrasse mit herrl. Bergblick
• separates Schlafzimmer oder Wohn-Schlafraum

• W-LAN
• Digital TV
• Bettwäsche & Handtücher inklusive
• Brötchenservice
• „belebtes Wasser“ für Ihre Gesundheit
• Aufenthaltsraum
• Langlaufloipe am Haus, Skiliftnähe
Loni Vogler
1F BBBBB / 5F BBBB A1
1F
3F
Landhaus Ruppaner
BBBBB /
BBBB C2
Herzlich Willkommen im Haus Schmidbauer mit 3 Luxus-Appartements in zentrumsnaher, sonniger Lage, herrl. Bergblick, Mini-Spa mit Sauna in den Appartements.
Füß 2F BBBB / 4F BBB / 1F
Haus Schmidbauer
3F BBBBB C2 Landhaus
n.k.
1hijlm Isvxrq 7 FeWos, 30-60 qm, 2-4 Pers. FeWo € 35,- bis 90,- (2 Pers.) je weitere Pers. € 10,- bis 15,19758 C3 86 Fischen FERIENWOHNUNG Erlebnis-
Mai
Mitte
& Familienbad Fischen Geöffnet Mitte
bis
September. Spaß für die ganze Familie mit 58 m-Wasserrutsche, Kinderplanschbecken, Cafeteria u.v.m. Info-Telefon: 08326 691 oder 996212
Weiler 21 87538 Fischen Tel. 08326 36100 · Fax 361036
landhaus@aigner-vogler.de www.aigner-vogler.de
Genießen Sie bei uns die schönsten Tage des Jahres!
NICHTRAUCHERHAUS in ruhiger Lage mit Blick auf die Bergwelt.
• liebevolle, großzügige FeWos mit herrlichem Südbalkon
• großerGartenmitFreisitz,Liege-/ Spielwiese u. Spielgeräte
• gemütliche Grillabende und Fackelwanderungen
• z. T. 2 getrennte Schlafzimmer
• Freie Fahrt Allg. Hörnerbahnen
• Golfplatz, Skilift, Loipe, Rad- & Wanderwege in direkter Nähe

• Sonderwochen: 7Tagewohnen–6Tagezahlen Wir freuen uns auf Sie!
3 FeWos, 60-70 qm, 1-5 Pers. FeWo € 70,- bis 87,- (2 Pers.) je weitere Pers. € 20,Kinder bis 4 Jahre frei!
Fischinger Gastro GmbH & Co. KG · Familie Schöll Hauptstraße 11 · 87538 Fischen Tel. 08326 2569330
info@fischen-urlaub.de · www.fischen-urlaub.de




Komfortable FeWos im alpin-modernen Stil Mit traumhaften Blick in die Allgäuer Bergwelt und in bester Lage im Ortskern von Fischen präsentieren sich unsere komfortablen 3- und 4-Sterne Ferienwohnungen für 2–5 Personen. Gemütlich und alpenländisch eingerichtet mit vollausgestatteten Küchen bringen sie die nötige Entspannung in Ihre freien Tage. Wir bieten alle Freiheiten und die Privatsphäre einer Ferienwohnung, gepaart mit dem Komfort eines Hotels.

Buchen Sie auf Wunsch unser reichhaltiges Frühstücksangebot oder Halbpension im hauseigenen Restaurant zu Ihrem Aufenthalt dazu. So starten Sie gestärkt in den Tag oder lassen ihn bei gutem Essen ausklingen.
• neuzeitlich, gemütlich eingerichtete Ferienwohnungen und Appartements
• Sehr ruhig und doch zentral gelegen
• Alle mit Balkon und Bergsicht, Flachbildschirm und Kabel-TV
• Kurpark, Kurhaus, Skilifte und Langlaufloipe in der Nähe
• Getränke- u. Brötchenservice
• Abholung von Bus u. Bahnhof
• Parkplätze direkt am Haus
4 FeWos, 42-56 qm, 2 Pers.
3 App., 18-38 qm, 1-2 Pers.
4 FeWos € 60,- bis 80,- (2 Pers.)
2 App. € 50,- bis 60,- (2 Pers.)
3 App. € 35,- bis 45,- (1 Pers.)
Andrea Aigner-Vogler
Maderhalm 13
87538 Fischen-Maderhalm Tel. 08326 36100 · Fax 361036
landhaus@aigner-vogler.de www.aigner-vogler.de
1jnosxIq
Erholung auf Fischens
Sonnenbalkon!
Genießen Sie in sehr ruhiger, sonniger Lage den herrlichen, freien Panoramablick auf die Allgäuer Alpen.
• freie Fahrt mit den Allgäuer Hörnerbahnen von Mai bis Oktober
• 2 getrennte Schlafzimmer
• sonnige Südbalkone mit Traumblick
• Spielwiese und Spielgeräte
• unsere Kälbchen freuen sich auf Ihre Kinder
• Kinder bis 4 Jahre frei!
5 FeWos, 45-75 qm, 1-6 Pers.
Landhaus Vogler: 2 FeWos, 35-45 qm, 1-4 Pers.
FeWo € 68,- bis 120,- (2 P.) Vogler € 52,- bis 88,- (2 P.)
Maria Martin
Bolgenstraße 5 · 87538 Fischen
Tel. 08326 1882 info@fewo-haus-martin.de www.fewo-haus-martin.de
Neu renovierte, familiengeführte FeWos in bester, zentraler und ruhiger Lage. Balkone mit Bergsicht. Gepflegtes Haus. Sat-TV und Radio. Kurhaus, Kurpark und Weidachanlagen, Wanderund Radwege, Skilift und Loipe, BusundBahninderNähe.Bahnreisende holen wir gerne vom Bahnhof ab. Idealer Ausgangspunkt für Wanderer und Radfahrer. Als einheimische Vermieter geben wir Ihnen gerne Tipps und Anregungen für Ihre Unternehmungen!
2 App., 31 qm, 2 Pers.
2 FeWos, 47 qm, 2 Pers. App. 31 qm € 48,- (2 Pers.) FeWo 47 qm € 64,- (2 Pers.)
Gaisbock der DorfUrlaub im Herzen von Fischen 8F BBBB / 2F BBB
wxIrqz 10 FeWos, 37-97 qm (1-6 Pers.) FeWo € 58,- bis 121,- (2 Pers.) je weitere Pers. € 15,Frühstück € 12,50 / HP € 28,28686 B2 1oswImiq 19871
Aigner 1F BBBB / 1F BBB / 1F n.k. C1
chijml
Haus
Stefanie Köcheler
Landhaus Aigner-Vogler 5F BBBB Landhaus Vogler 2F n.k.
C3
24064
Ihilmwxq 19744 Ferienwohnungen Dorle-Ruppaner 4F BBBB / 3F BBB B2
und Dorle Ruppaner
7 · 87538 Fischen Tel. 08326 8387 · Fax 385886 fam.ruppaner@t-online.de www.ferienwohnungen-dorle-ruppaner.de ilmnwIxq
BBBB / 2F BBB B2
Otto
Schustergasse
19849 Fewos Haus Martin 2F
87 Fischen FERIENWOHNUNG
Haus Allgäublick
1F
Neue, exkl. Fewo mit eigener Sauna, 3 getrennten Schlafzimmern und Balkonen in Zentrumsnähe. Küche m. Spülmaschine. Traumhafter Bergblick!
Nicole Aigner
Am Nägelesberg 4 · 87538 Fischen Tel. 08326 36100 · Fax 361036 landhaus@aigner-vogler.de www.aigner-vogler.de
1josxIbq
1 FeWo, 110 qm, 2-6 Pers. FeWo € 125,- bis € 170,- (2 Pers.) je w. Pers. € 20,- / Kind bis 4 J. frei
Ferienwohnung
1F BBBB B2
28951
Ferienwohnung Alpenwiesle
Ferienhof Althaus
2F
Exkl. FeWo, sep. Schlaf-/Wohnraum, allergikerfreundlich, Fliegengitter, SatTV,W-LAN,Westbalkon.Wanderwege, Loipe, Bus, Bahn in nächster Nähe.
Alpiner Stil, EG, ruhige Lage, Südterrasse mit Gartenabteil, Carportstellpl., Schlafzi., große Wohnzimmer mit TV und Essbereich, Bad mit Du/WC, Küche, Spülmaschine, Kaffeemaschine. Doris Michaely · Im Wiesle 4 87538 Fischen im Allgäu Mobil 0178 2909779 katharina.michaely@outlook.de www.ferienwohnung-alpenwiesle.jimdosite.com

hilmwxIq
1 FeWo, 60 qm, 2 Pers. FeWo € 80,- (2 Pers.)
29914
Herzlich Willkommen in unseren 2 gemütlich eingerichteten FeWos in ruhiger Ortsrandlage. Tiere und hauseigene Kutschfahrten. Sat-TV, W-LAN, Waschmaschine. Parkplatz am Haus. Toni & Kerstin Althaus · Eybachweg 1 87538 Fischen-Oberthalhofen Tel. 08326 385245 · Fax 385244 ferienhof-althaus@t-online.de www.ferienhof-althaus.de
1mo
2 FeWos, 52-86 qm, 1-4 Pers. FeWo € 70,- bis 115,- (1-4 Pers.)
19730
Sehr gepflegte FeWos in ruhiger Lage. Alle m. sep. Schlafzi., Wohnzi., Küche, Bad, Flat-TV und Balkon m. Bergblick. Nähe Bus/Bahn/Loipe/ Wanderwege. WLAN, Parkpl. a. Haus. Josef Ochsenreiter · Dorfstr. 2b 87538 Fischen-Langenwang Tel. 08326 9181




info@haus-andrea-fewo.de www.haus-andrea-fewo.de
1hilmowx
2 FeWos, 40-60 qm, 1-3 Pers. FeWo 1 € 69,- (2 Pers./Tag) FeWo 2 € 61,- (2 Pers./Tag)
Haus Burgfrieden
19731
3F BBBB B2
2F BBBB / 1F n.k. A2
Gästehaus, Bergpanorama, 2-RaumApp. 1-2 Pers., im Landhausstil, num. Parkpl., 5 Gehm. z. Zentrum, W-LAN, Brötchen- u. Getränkeservice.







28936 1hilmwxq
Bärbel Sauter Burgstraße 5 · 87538 Fischen Tel. 08326 9542 o. 0157 73741771 sauter@allesclar.de www.ferienwohnung-anna-sauter.de
1 FeWo, 43 qm, 1-2 Pers. FeWo € 56,- bis 69,- (2 Pers.) ab 5 Nächten
Gästehaus Eggensberger
4F BBBB B2
Michael Reiß mit Familie Berger Steige 8 · 87538 Fischen-Berg Tel. 08326 426 · Fax 1283 info@gaestehaus-auffenberg.de www.gaestehaus-auffenberg.de
1ikmwIqI
4 Fewos, 40-55 qm, 1-2 Pers. FeWo € 39,- bis 79,- (1-2 Pers.) Endreinigung inkl.
Ferienwohnungen Fischer
19860
Komfortable, gemütliche 2- bis 3-Zi.NR-FeWos, separate Küche, Balkon, Terrasse, freier Bergblick, zentrale Lage, Parkplatz, Nähe Kurpark, Loipe + Wanderwege, W-LAN. Ingeborg van der Borg Pfarrstraße 2 · 87538 Fischen Tel. 08326 7134 vdb-fischen@online.de www.ferienwohnungen-vanderborg-fischen.de
19716 jsxIwr57
3 FeWos, 66-86 qm, 2-4 Pers. FeWo € 70,- bis 82,- (2 P. für 7 Nächte) je weitere Pers. € 12,- bis 17,-
Ferienwohnung Holzer
Sonnenseite von Fischen. Whg. 1 u. 3 m. Kachelofen. Tisch- und Bettwäsche, Bergblick, 10 Gehminuten zum Ortszentrum, Ausgangspunkt für Aktivitäten.
Genießen Sie Ihren Urlaub in liebevoll eingerichteten Fewos mit herrlichem Bergblick in ruhiger und zentraler Lage. 1 FeWo, zzgl. EZ!
Herzlich willkommen in unseren gepflegten FeWos mit je 2 getr. Schlafzi. Süd- o. Westbalkon mit Blick auf die Berge, Bus/Bahn in nächster Nähe.
Gemütliche, gepfl. FeWo in ruhiger, zentr. Lage. Sat-TV, Spülmaschine, Mikrowelle, Du/WC, Südbalkon mit Bergblick. Nähe Kurhaus/LL-Loipe.
19665 1ilmnsxI
Martin Freisl Gerberstr. 17 · 87538 Fischen-Au Tel. 08326 1846 martin-freisl@t-online.de www.martin-freisl.de
3 FeWos, 45-53 qm, 2 Pers. FeWo € 58,- (2 Pers.) ab 14 Nächten keine ER
Ferienhof Keller - Bioland
Unser Ferienhof liegt in sonniger & ruhiger Lage mit herrl. Bergblick. Wir bietenIhnengemütl.&gepflegteFeWos mit zwei separaten Schlafzimmern.
Franz Keller
Andreas Fischer
Weilerstr. 17 · 87538 Fischen Tel. 08326 7320 · Fax 385228 info@fischen-ferienwohnung.com www.fischen-ferienwohnung.com
24045 ilmxqI
4 FeWos, 45-60 qm, 1-3 Pers. FeWo € 75,- bis 100,- (2 Pers.)
Andreas Fischer
Kipfelerweg 7 · 87538 Fischen Tel. 08326 7320 · Fax 385228 info@ferienwohnungen-fischen.com www.ferienwohnungen-fischen.com
23841 Ijzmxql
2 FeWos, 65-90 qm, 2-4 Pers. FeWo € 70,- bis 100,- (2 Pers.) je weitere Pers. € 20,- bis 23,-
Anna Holzer
Schustergasse 2 · 87538 Fischen Tel. 08326 204 urlaub@holzer-fewo.de www.holzer-fewo.de
hilmwxIq
1 FeWo, 45 qm, 2 Pers. FeWo € 48,- bis 60,- (2 Pers.)
23887
Gundelsbergerweg 19 87538 Fischen Tel. 08326 1787 · Fax 366734 info@ferienhof-keller.de www.ferienhof-Keller.de
1hlmiwIq
2 FeWos, 50-60 qm, 1-4 Pers FeWo € 65,- bis 75,- (2 Pers.) je weitere Pers. € 10,- bis 13,-
23911
BBBB C2
1F BBBB A2
BBBB A1
Haus
Andrea 1F BBBB / 1F BBB B5
Anna
Gästehaus Auffenberg 2F BBBB / 1F BBB / 1F n.k. C2
FeWos Inge van der Borg
1F BBBB / 1F BBB B5
1F BBBB B2
88 Fischen FERIENWOHNUNG
2F BBBB C2
Ruhige Lage, Bergblick, komfortable, gemütliche FeWos mit Südbalkon, sonnige Spiel- und Liegewiese, LL-Loipe, Wander- und Radwege ab Haus.
Leonhard Koch
Altstädter Straße 6 87538 Fischen Tel. 08326 8185 · Fax 381667 info@gaestehaus-koch.de www.gaestehaus-koch.de



ijlmowIz
3 FeWos, 45-53 qm, 1-4 Pers. FeWo € 62,- bis 89,- (2 Pers.) Endreinigung inklusiv
19778
Zuhause fühlen in unseren neu renovierten 4-Sterne-Wohnungen.
NEU seit 2018: unser „Schwalben Nest“ – Kinderhaus mit Spielplatz.
Josef Müller-Zeller
Altstädterstr. 16 · 87538 Fischen Tel. 08326 383961 o. 0160 97039345 info@zuhaus-am-malerwinkel.de www.zuhaus-am-malerwinkel.de
1omnsIr
1DZ, 3 FeWos, 30-60 qm, 2-4 Pers. € 70,- bis 105,- (2 Pers.) je weitere Pers. € 15,- / Kind € 9,- / Hund ab € 7,-
19681
Ferienwohnung Müller
Ferienwohnung
Gemütliche FeWo, mit Liebe zum Detail eingerichtet. Brötchenservice, herrlicher Bergblick, 10 Gehmin. ins Ortszentrum. Wir freuen uns auf Sie!
Hannelore Neß
Gerberstraße 15 87538 Fischen-Au Tel. 08326 292 info@landhausness.de www.Landhausness.de
1ilmwxI
2 FeWos, 52-61 qm, 2 Pers. FeWo € 57,- bis 64,-


19800
Lassen Sie in ruhiger Lage bei herrlichem Bergblick die Seele baumeln! Liebevoll eingerichtete FeWos Nähe Skilifte, ca. 8 Gehmin. zum Ortskern.
Kristina Schmid
Am Nägelesberg 8 · 87538 Fischen Tel. 08326 38285 info@fewoschmid.de www.fewoschmid.de
1ijmswIq
3 FeWos, 49-70 qm, 2-4 Pers.
2 FeWos, 2 Zi. € 54,- bis 70,1 FeWo, 3 Zi. € 71,- bis 95,- (je 2 Pers.)
19854
Genießen Sie Ihren Urlaub in unserer gemütlich einger. FeWo in absolut ruhiger Lage und beeindruckender Aussicht vom großzügigen Balkon.
Komfortable 3-Zi-NR-EG-FeWo in ruhiger Lage mit herrlichem Bergblick verfügt über 2 Schlafzimmer, 2 Bäder und ist behindertengeeignet.
Sehr ruhig gelegen am Waldrand. EGFeWo m. Terrasse, 1 bzw. 2 Schlafzi., separate Küche, separates WC. Ski-/ Snowboardschule und -Verleih. Nichtraucherhaus.
Familie Petra Neß
Marlies Müller Haldenweg 3 c · 87538 Fischen Tel. 08326 7744 mueller-fischen@t-online.de www.fewo-mueller-fischen.de
23966 hilmwxIq
1 FeWo, 44 qm, 2 Pers. FeWo € 70,- bis 80,-

Ferienwohnung Seitz
1F BBBB B2
Nicole und Franz Mayer Kapfstraße 10 · 87538 Fischen Tel. 08326 384053
NicoleundFranz@gmx.de www.fewo-nicolem.de
1jmwxIq6
1 FeWo, ca. 90 qm FeWo € 78,- bis 98,- (2 Pers.) je weitere Pers. € 15,-
Ferienwohnungen
25591
Komfort. 2-Zi-FeWo, freier Bergblick im Kernort (kein Ortsteil), sonnig und ruhig in Anwohnerstr.; separate/mod. Küche mit Geschirrspüler, TL-Bad, W/S-Balkon.
Erleben Sie die schönsten Tage des Jahres in freundlicher u. fam. Umgebung. Genießen Sie in ruhiger Lage unsere komf. Ferienwohnungen.
23798 hilmwxIq
Anita Seitz · Sonnenkopfweg 7 87538 Fischen · Tel. 08326 3858738 o. 0176 41704923 fischen-fewo@web.de www.fischen-fewo.de
1 FeWo, 46 qm, 2 Pers. FeWo € 56,- bis 68,- (ab 7 Tage) ER inkl. / je weitere Pers. € 10,-
Herzlich Willkommen!
Unser familienfreundlicher Bauernhof bietet Ihnen gemütlich eingerichtete und gepflegte Ferienwohnungen am Ortsrand von Fischen, in ruhiger und sonniger Lage mit freiem Blick auf die Allgäuer Berge.

19838
•
•
Birgit Hiltensberger
Haslachweg 1 · 87538 Fischen-Au Tel. 08326 381930 · Fax 381931 info@ferienwohnung-waldhaeusle.de www.ferienwohnung-waldhaeusle.de
19719 ijlmoI5
1 FeWo, 54-71 qm, 2-4 Pers. ab 2. Tag: € 55,- bis 74,- (2 Pers./Tag)
Achweg 31 · 87538 Fischen Tel. 08326 38060 · Fax 3849785 info@ferienhof-brutscher.de www.ferienhof-brutscher.de
5 FeWos, 36-60 qm, 2-5 Pers. € 55,- bis 90,- (2 Pers.)
Andreas Spiß
Schustergasse 6 · 87538 Fischen Tel. 08326 1443 · Fax 384665 info@fewo-spiss.de www.fewo-spiss.de
19817 ilmwxIq2
2 FeWos, 55 qm, 2 Pers. FeWo € 65,- bis 69,- (2 Pers.)
Verbringen Sie die kostbarsten Wochen in unserer liebevoll eingerichteten, komplett renovierten FeWo. Mit Skikeller und Fahrradstellplatz.
Sabine + Jürgen Ley Weilerstr. 7 · 87538 Fischen Tel. 01520 4615140 Fax 032222 443674 ley.juergen@t-online.de www.alpenliebe-fischen.com
1 FeWo, 35 qm, 2 Pers. FeWo € 46,- bis 61,-



 Gästehaus Koch 3F BBBB A1
Zuhaus am Malerwinkel
Gästehaus Koch 3F BBBB A1
Zuhaus am Malerwinkel
3F BBBB / 1FZ BBBB B1
Marlies 1F BBBB C2
Nicole Mayer 1F BBBB C2
Landhaus
Neß
2F BBBB A2
Gästehaus Schmid 3F BBBB C2
Spiß 2F BBBB B2
1F BBBB A2 1hiloIq
Waldhäusle
Ferienhof Brutscher 5F BBB C2
• Getränke-undBrötchenservice
• 10 Gehminuten zum Ortszentrum
Langlaufloipe direkt am Haus
Ermäßigung in Vor- und Nachsaison Wir freuen uns auf Sie!
BBB B2 89 Fischen FERIENWOHNUNG
29760 hlmwIzaq Ferienwohnung Alpenliebe 1F
Erholung pur in Bergluft und herrlicher Natur! Gemütliche FeWos im 1. OG, separate Schlafzimmer, Süd/ Westbalkon. Wanderwege und Loipe in unmittelbarer Nähe.

Gabi Jacobs
Bornheimer Str. 13 55237 Lonsheim Tel. 0175 6055886
gabrielejacobs@web.de
ilmxqI
2 FeWos, 48-55 qm, 2 Pers. FeWo € 55,- bis 60,- (2 Pers.)
19859
Gemütliche Komfort FeWo für 2-4 Pers. mit Balkon. Bergblick auf die Allgäuer Berge, kostenloses W-LAN, Bus/Bahn in nächster Nähe.
Florian Bollwein
Dorfstraße 15 · 87538 Fischen Tel. 08326 1502 · Fax 384178 GaestehausBollwein@t-online.de www.GaestehausBollwein.de
1ijmsxIq
4 FeWos, 35-60 qm, 1-4 Pers. FeWo € 40,- bis 90,- (1-4 Pers.)
19863
NR-FeWos mit absolut freiem Bergblick, gemütlich hell möbliert, Balkone südliche Randlage, Busbahnhof um die Ecke. Zustellbett möglich.
Carola Schmid
Bahnhofstraße 11 · 87538 Fischen Tel. 08326 381711 Mobil 0151 57792709 hauscarola-fischen@t-online.de www.hauscarola-fischen.de
hikmwxIq
2 FeWos, 50 qm (2 Pers.) FeWo € 55,- bis 65,- (2 Pers.) je weitere Pers. € 10,-
19666
Gemütliche & geräumige FeWos mit traumhaftem Bergblick und großem Südbalkon, zum Teil mit separatem Schlafraum, Skilift, Loipe u. Wanderwege in der Nähe vom Haus.
Christine Kling Maderhalm 4 · 87538 Fischen Tel. 08326 7096 gaestehaus-finkel@t-online.de www.gaestehaus-finkel.de
1hilnxIq
3 FeWos, 55-72 qm, 2-4 Pers. FeWo € 48,- bis 75,je weitere Pers. € 8,- bis 12,-
19755
Ruhig gelegenes Reihenmittelhaus mit traumhafter Bergsicht. 2 Schlafzi., Bad/WC, sep. WC, Küche mit Spülm., Terrasse, Balkon und Garten.




3 gemütl., gepflegte FeWos mit Bal kon in sehr ruhiger, sonniger Lage. Freier Bergblick, Loipe am Haus. Hofeigene Produkte.
Fünf Wohnungen mit allem Komfort lassen Dich ankommen, wohlfühlen, genießen, daheim sein.
Oliver Pillmeier
25672 hilmwxI5
Im Wiesle 3 · 87538 Fischen Buchung: Helmut Lorenz Breite Straße 2 · 41460 Neuss Tel. 02131 271050 lorenzh@uni-duesseldorf.de
1 FeWo, 60 qm, 4 Pers. FeWo € 500,- pro Woche (2 Pers.) je w. Pers. € 60,- / ab 6 J. € 30,- / bis 6 J. frei
Allgäuer Bergblick
Nicole und Franz Mayer Achweg 15 · 87538 Fischen Tel. 08326 384053 NicoleundFranz@gmx.de www.fewo-nicolem.de
jmswxIzq
1 FeHaus, 90 qm, 2-6 Pers. FeHaus € 78,- bis 98,- (2 Pers.) je weitere Person € 15,-


28979
Andreas Vogler Maderhalm 2 · 87538 Fischen Tel. 08326 566
Gabriele-Vogler@web.de www.vogler-ferienwohnungen.de
1hilswIq
3 FeWos, 25-40 qm, 2-4 Pers. FeWo € 45,- bis 67,- (2 Pers.) je weitere Pers. € 8,- bis 10,- / ER inkl.
19717
Illerstraße 10 87538 Fischen-Au Tel. 08326 3849866 kontakt@allgaeulodge.de www.allgaeulodge.de


5 FeWos, 55-75 qm, 2-4 Pers. FeWo € 102,- bis 122,- (2 Pers.) je weitere Pers. € 15,-

19676
Maderhalm 14 · 87538 Fischen Tel. 08326 36300 info@allgaeuer-bergblick.de · www.allgaeuer-bergblick.de
Träumen in schönen Räumen... Großzügig und harmonisch eingerichtete Wohnungen laden Sie zum Wohlfühlen ein. Vom Balkon genießen Sie einen herrlichen Blick auf die Allgäuer Bergwelt.
• gemütliche 2- und 3-Zimmer-FeWos
• Bettwäsche und Handtücher inkl.
• Brötchen- und Getränkeservice
• sep. Küche mit Spülmaschine und Mikrowelle
• sep. WC, z.T. Doppelwaschtische
• Spielwiese mit Schaukel und Trampolin
• idealer Ausgangspunkt für Wanderer und Radfahrer
• Kurze Wege zur Loipe und zum Skilift
Haus Arnika Fewo Jacobs
2F BBB C1
Gästehaus Bollwein 4F BBB B5
B3
Haus
Carola 2F BBB
3F
C3
Gästehaus Finkel
BBB
Ruhige Lage mit 10 Meter Balkon –ab mittags Sonne. Hochwertige Inneneinrichtung mit Garage.
Ferienwohnung Lorenz 1F BBB
Ferienhaus Nicole 1F BBB C2
Ferienhof Andreas Vogler 3F BBB C4
A2
hijlmwIz allgäulodge
Marita und Rogart Burger
1ijosw xIzqn7 7 FeWos, 48-88 qm, 1-4 Pers. FeWo € 65,- bis € 125,- (2 Pers.) Endreinigung inklusve 23797 C3 90 Fischen FERIENWOHNUNG
auf Anfrage, zzgl. Kurtaxe
1hilmn wxrq
Herzlich willkommen im Allgäuer Landhaus. Lassen Sie sich ein auf erholsame Tage, aktive Stunden und traumhafte Augenblicke in einer der schönsten Wanderregionen Deutschlands. 7 liebevoll eingerichtete Komfort-Ferienwohnungen mit Bergblick im Landhausstil. Ein angenehmes Ambiente und Wohlfühlatmosphäre erwarten Sie bei uns im Allgäuer Landhaus. Brötchenservice und Frühstück auf vorzeitige Anfrage. Grander Wasser für Ihre Gesundheit. Für unsere Gäste kostenloses W-LAN und Bergbahnen Oberstdorf/Kleinwalsertal kostenfrei zubuchbar. Unser Allgäuer Landhaus liegt sehr zentral. Nächste Einkaufsmöglichkeit 5 Min. zu Fuß, nächste Bushaltestelle 3 Min. zu Fuß, Bahnhof 10 Min. zu Fuß. Skilift und Langlaufloipe in unmittelbarer Nähe. Hund auf Anfrage. Herzlich Willkommen bei Fam. Dippon!

Marion und Lars Kielhorn

Gerberstraße 4 · 87538 Fischen-Au Tel. 08326 35150 · Fax 35250 info@haus-enzian.de · www.Haus-Enzian.de
Gepflegtes Landhaus, Südhanglage, herrlicher Bergblick, helle, mit Liebe zum Detail eingerichtete Wohnungen für 2-4 Personen, Natur-Fichtenholz-Möblierung, gemütliche Sofas, Küche, Du/WC, eigener Balkon, Telefon, Sat-Anschluss, Internetnutzung über W-LAN kostenlos. Brötchen- und Getränkeservice. Bahnreisende holen wir gerne am Bahnhof ab. 5 Minuten zum Auwaldsee, Iller; 10 Minuten zur Ortsmitte; Langlaufloipe in nächster Nähe.



Wir würden uns freuen, wenn wir Sie bald bei uns begrüßen dürften.
Fischinger Heimathaus & FIS-Skimuseum


Obermühle-Säge
Besuchen
Allgäuer Landhaus
Anette Pannier-Dippon Berger Weg 18 · 87538 Fischen Tel. 08326 666 · Fax 384512 info@allgaeuer-landhaus.de · www.allgaeuer-landhaus.de
B2
7 FeWos, 35-111 qm, 2-4 Pers. FeWo € 82,- bis 185,- (2 Pers.) Bergbahnticket kostenfrei Oberstdorf/ Kleinwalsertal & W-LAN, Brötchenservice & Frühstück
19789
Ferienhaus Enzian
1hilmw xIrq7
FeWos, 45-55 qm, 2-4 Pers. FeWo € 50,- bis 80,- (2 Pers.)
Pers.
12,-
frei,
inkl. 19841 A2
4
je weitere
€
Kinder bis 4 Jahre
Kurtaxe
und Donnerstag
zwischen 15.00 und 17.00 Uhr Utensilien längst vergangener Tage bestaunt sowie internationale und Fischinger Skigeschichte nachempfunden
239.
Jeden Dienstag
können
werden. Gruppenführungen nach Vereinbarung, Tel. 08326
91 Fischen FERIENWOHNUNG Freier Eintritt* Freier Eintritt* * für alle Hörnerdörfer Gäste mit gültiger Allgäu-Walser-Card
Sie die über 500 Jahre alte historische Sägemühle. Bestaunen Sie bei einer Vorführung die Präzision des Sägewerkes. Erleben Sie, wie viel Kraft der unscheinbare Mühlbach doch hat. Der Säger Hans Maurer beantwortet Fragen rund um die Mühle, die Wasserkraft und vieles mehr. Tel. 08326 36460
ijlmwx Izrabq
Unsere gepflegte Ferienwohnanlage liegt sehr zentral (Einkaufsmöglichkeiten 5 Min. zu Fuß, Bahnhof 10 Min. zu Fuß). Das besondere ist die große Auswahl an individuell eingerichteten Wohnungen. So ist für jeden Geschmack etwas dabei. Alle Wohnungen sind komplett ausgestattet und verfügen über Balkon oder Terrasse mit herrlicher Aussicht auf die Allgäuer Alpen. Unser Schwimmbad ist das InklusivHighlight im Haus. Ganzjährig und fast rund um die Uhr können Sie bei ca. 30° C schwimmen und sich im Liegebereich entspannen. Mit 13 x 6 m ist das Edelstahlbecken groß genug um sportliche Bahnen zu ziehen – die Sauna wechselnd mit Dampf oder Finnisch (gegen Gebühr). Der Zugang führt ganz bequem direkt durchs Haus. Gönnen Sie sich diesen Luxus, wir freuen uns auf Sie!
Birgit und Hans Schwärzler
Kapfstraße 42 · 87538 Fischen Tel. 08326 7375 info@landhaus-reiser.de · www.landhaus-reiser.de

Genießen Sie den großartigen Blick über duftende Wiesen, auf die beeindruckende Bergkulisse. Wir bieten Ihnen:
• attraktive FeWos mit Bergblick, Balkon oder Terrasse


• ruhige, aber dennoch zentrale Lage – 10 Gehmin. zum Ortskern
• LL-Loipen, Wanderwege und Golfplätze in unmittelbarer Nähe



• kostenloser Internetzugang, neue Flachbildschirme
• gehbehindertenfreundliche Terrassenwohnungen
• Bettwäsche u. Handtücher inklusive
• Kinderermäßigung
• keine Haustiere
• Rauchen nur auf Balkon o. Terrasse
• Angebote in der Vor- u. Nachsaison erhalten Sie auf Anfrage o. im Internet
Im Sommer 8 große Bergbahnen kostenlos nutzen! Im Ortsteil Berg, auf dem Sonnenbalkon von Fischen, vermieten wir in ruhiger Lage die Doppelhaushälfte Am Sonnenbergle mit 3 FeWos. Alle haben Balkone mit einer traumhaften Aussicht. Zur Entspannung, nach einem sportlichen Tag, steht Ihnen unsere Alpin-Sauna (gegen Gebühr) zur Verfügung. Freies Kabel-TV/W-LAN. Ebenerdig einfahrbare Garagenstellplätze sind für 3 € zubuchbar.
In ruhiger Ortsrandlage bieten wir in den beiden Häusern Zum Tannacker 17 u. 19 je eine 2-Raum-FeWo im EG mit Terrasse und Gartenzugang, sowie einer traumhaften Panoramabergsicht. Alle Wohnungen haben Laminatboden u. freie Parkplätze direkt am Haus.
Ferienwohnungen Panorama
Bianca
Dörfel Grüntenstraße 12 - 14 · 87538 Fischen Tel. 08326 7595 · Fax 385065 panorama-fischen@email.de · www.panorama-fischen.de
28 FeWos, 45-92 qm, 1-6 Pers. FeWo € 59,- bis € 95,- (2 Pers.) Detaillierte Preisübersicht im Internet oder auf Anfrage 23766 B2
Landhaus
Reiser 1F BBB / 8F n.k.
1Iikmn oszql 9 FeWos, 45-50 qm, 2-4 Pers. FeWo € 67,- bis 72,- (2 Pers.) je weitere Pers. € 15,Endreinigung (ab 5 Nächten) inklusive 19713 C2 Am Sonnenbergle / Zum Tannacker
Zum Tannacker 4b, Zum Tannacker 17 / 19 · 87538 Fischen Charivari Ferienwohnungen · Berger Steige 1 · 87538 Fischen Tel. 08326
· info@charivari-ferienwohnungen.de www.charivari-ferienwohnungen.de mijlwz xIrb5h 5 FeWos, 2-5 Pers. 4 x 2-Raum, 50-65 qm, € 60,- bis 120,1 x 3-Raum, 60 qm, € 80,- bis 140,28952 C2 92 Fischen FERIENWOHNUNG
36000
Roswitha Müller
Am Anger 9 87538 Fischen Tel. 08326 9035 · Fax 385871 info@haus-anger.de
Ankommen und Wohlfühlen in unserem familiär geführten Gästehaus „Am Anger“. Sie wohnen zentral und ruhig am Anger und Kurpark. Unsere 2-ZimmerFeWos sind gemütlich und gepflegt eingerichtet. Sep. Schlafzimmer, Wohnraum mit Schlafmöglichkeit, gut ausgestattete Küchen, Dusche/WC. W-LAN vorhanden.
Tiefgaragenplatz nach Verfügbarkeit. Haustiere auf Anfrage.
Chalets Flora & Fauna
4 FeWos, 36-58 qm, 1-4 Pers. FeWo € 43,- bis 65,- (2 Pers.) je weitere Pers. € 10,- bis 12,-

Gästehaus Müller B2
Herzlich Willkommen im Urlaub! Abseits von Hektik u. Stress verbringen Sie die schönsten Tage in einer sonnigen u. modernen Ferienwohnung.
Postgasse 12: 4 FeWos, davon 3 Wohneinheiten mit 2 getrennten Schlafzimmern für 2-6 Personen.
St. Florianstrasse 1: 2 Wohnungen mit je 55 m2 für 2-4 Personen.
Kirchweg 2 87538 Fischen-Langenwang Charivari Ferienwohnungen Tel. 08326 36000 info@charivari-ferienwohnungen.de www.charivari-ferienwohnungen.de
imxIqhjz
Ellen Müller
Postgasse
Marita Birzele
Achweg 2 · 87538 Fischen Tel. 08326 385426 · 0177 4703730 info@panoramablick-fischen.de www.panoramablick-fischen.de
ijmwosIq
Gästehaus Alpenflora FeWos
C2
10 FeWos, 40-70 qm, 2-6 Pers. FeWo € 44,- bis 86,- (2 Pers.) je weitere Pers. € 10,Kinder bis 5 Jahre kostenlos
Haus Alpenglühen A2
Gästehaus Alpenruh
ANKOMMEN & WOHLFÜHLEN
2 großzügige Komfort-NichtraucherFeWos mit Panorama-Balkon. Ruhige, sonnige und zentrumsnahe Lage.
FeWo auf der Sonnenseite v. Fischen. 2 separate Schlafzimmer, Bergblick, W-LAN,Geschirrspüler,Loipe,Wanderwege ab Haus. Radgarage, bester Ausgangspunkt für Touren.
Paula Ruppaner
Achweg 16 ·87538 Fischen Tel. 08326 1404 info@ferienwohnungen-alpenflora.com www.ferienwohnungen-alpenflora.com
19726 hikmvwIq
2 FeWos, 52-65 qm FeWo € 70,- bis 85,- (2 Pers.)
Neuerbaute, freistehende Häuser nur wenige Kilometer vor Oberstdorf im modernen AlpinStil stimmig und liebevoll mit viel Holz eingerichtet und sehr komfortabel ausgestattet.
3 separate Schlafzimmer, 2 Bäder und 1 Wohn-Esszimmer mit Küche bieten einer großen Familie ausreichend Platz für einen erholsamen Urlaub. Rad-/Wanderwege sowie die Loipen führen direkt am Haus vorbei. Gute Bahn- und Busverbindung.
2 Chalets, 100 qm, 3-7 Pers. Ferienhaus € 140,- bis 240,-








Gemütliches Landhaus mit Panoramablick auf die Alpen in freier, sonniger Lage. Sehr gepflegte und komfortabel ausgestattete FeWos im Allgäuer Landhausstil in unterschiedlichen Größen.
Jede Whg. verfügt über eine Terrasse mit Garten o. Balkon. Brötchen u. Getränkeservice, Fahrrad u. Schlittenverleih, Sauna. Ca. 7 Gehminuten ins Zentrum. Abschließbarer Raum für Fahrräder und Skier. Rad u. Wanderwege, Loipen, Kinderskilift und Skibushaltestelle in unmittelbarer Nähe. Seit Januar 2019 neu renoviert.
C2
29468
7 FeWos, 38-122 qm, 1-10 Pers. FeWo € 58,- bis 96,- (2 Pers.) je weitere Pers. € 10,- bis 18,-
Anita Denz
Im Wiesle 1 · 87538 Fischen Tel. 08326 641 · Fax 385491 info@haus-alpengluehen.de www.haus-alpengluehen.de
19727 jlmxwIq
6 gemütl. FeWos mit Traumblick in die Alpen, Loipe am Haus, vers. Sport mögl. in der Nähe. Hörnerbahnen MaiOkt. gratis. W-LAN inkl. 360 Grad Bilder finden Sie auf unserer Homepage. Renate Vogler
Maderhalm 24 · 87538 Fischen Tel. 08326 36240 · Fax 362412 info@ferienwohnungen-fischen.de www.ferienwohnungen-fischen.de
19872 1hilmxqI
6 FeWos, 38-51 qm, 2 Pers. FeWo € 65,- bis 75,Endreinigung inkl. / zzgl. Kurtaxe
Freier Bergblick, Lage im Grünen, 10 Gehmin. Ortszentrum. FeWo mit Balkon od. Terrasse. Komplett eingerichtet – Herzlichkeit & Wohlgefühl!
Familie Mayr
Weilerstraße 30 · 87538 Fischen Tel. 08326 8369 · Fax 7896 info@landhaus-andrea.de www.landhaus-andrea.de
19874 1hilmqxI
2 FeWos, 40-45 qm, 2 Pers. FeWo € 55,- bis 90,-
93 Fischen FERIENWOHNUNG
jlmwx478 19832 Haus „Am Anger“ B2
28977
B5
Im Sommer Hörnerbahnen kostenfrei!
23960
St. Florianstrasse 3: Neu erbautes Ferienhaus mit 4 Wohneinheiten für 2-4 Personen. 12 · 87538 Fischen Tel. 08326 7260 · Fax 366573
info@ferienwohnung-fischen.net www.ferienwohnung-fischen.net
1ilmoIr4
Haus Panoramablick
1 FeWo, 60 qm, 2-3 Pers. 2 sep. Schlafz. FeWo € 70,- bis 85,- zzgl. KT ab 14 Tage kein Zuschlag
Landhaus Andrea B2
Gemütlich eingerichtete Ferienwohnung in ruhiger Lage u. herrlicher Bergsicht. Bushaltestelle, Wanderwege und Loipen in direkter Nähe.
Markus Ankenbrand
Winkelstraße 4 87538 Fischen-Oberthalhofen Tel. 08326 615
ferien.ankenbrand@web.de
1Iilmwxq
1 FeWo, 38 qm, 2 Pers. FeWo € 48,- (2 Pers.) zzgl. KT
19733
Familiär geführtes Gästehaus mit herrlicher Bergsicht. Komfortabel und gemütlich ausgestattete Wohnungen mit Balkon. Direkt an der Loipe.
Birgit Paluka Aurikelweg 18 · 87538 Fischen Tel. 08326 1858 o. 0160 96678533 Fax 3844887 birgitpaluka@t-online.de www.fewo-anna.de
hilmsxIq
2 FeWos, 30-45 qm, 1-4 Pers. FeWo € 44,- bis 79,- (2 Pers.) Wir freuen uns über Ihre Anfrage!
19875
Ferienwohnung Anne
Atelierhaus C2
Landhaus Bader C3
Gemütl. Wohnung im EG mit Südterrasse, Bergblick, 2 getrennte Schlaf zi., zentrumsnahe und ruhige Lage, Wanderwege u. Loipen in der Nähe.
Anne Ratzki
Weilerstraße 24 87538 Fischen Tel. 08323 9861413 ferienwohnung-anne@gmx.de
hjlmwIqx
1 FeWo, 80 qm, 2-4 Pers. FeWo € 85,- (2 Pers.) je weitere Pers. € 12,-
Beim Schlossar B2
23986
Wohlfühlen in gemütlichen FeWos; mit großem Südbalkon, 2 Zi., sep. Schlafzi. und Bergblick. Parkplatz, Radhütte, Skilift am Haus. Zentrale Lage. Familiär geführt.
NR-Haus, ruhige, traumh. Westrandlage, herrliche Bergsicht. Gemütliche, gepflegte 2- und 3-Raum-FeWos mit Terrasse oder Balkon.Angeboteinder Nebensaison.

Rosl Spatschil Kapfstr. 12 · 87538 Fischen-Berg Tel. 08326 684 atelierhaus-fischen@t-online.de www.atelierhaus-fischen.de
19734 hilmjx1q
3 FeWos, 46-70 qm, 1-4 Pers. FeWo € 50,- bis 64,- (2 Pers.) je weitere Pers. € 15,- bis 20,-
Haus Bergsicht
Zwei gemütliche Ferienwohnungen mit sep. Schlafzimmer, Südbalkon mit traumhafter Aussicht. Wanderwege und Loipen in nächster Nähe. W-LAN. Parkplatz am Haus. Eva und Hans Bader Maderhalm 10 · 87538 Fischen Tel. 08326 1442
Landhaus-Bader@gmx.de www.maderhalm.de
1ilmwxIr
Ankommen & Wohlfühlen in gemütl., ruhigen FeWos mit großem Ost-Südbalkon, Bergblick, separatem Schlafzi. In zentraler Lage am Kurpark.
19659
C2
Ferienwohnungen Besler
C4
Liebevoll eingerichtete FeWos mit freiem Bergblick, z. T. 2 sep. Schlafzimmer. Garage u. W-LAN inklusive. 10 Gehminuten zum Ortskern.
Ruhige, sonnige Hanglage, Bergblick, Rad- u. Wanderwege, Loipe dir. am Haus, 3 großzügig, liebevoll u. komfortabel ausgestattete FeWos zum Erholen u. Wohlfühlen.
Hubert Müller
Am Anger 7 87538 Fischen Tel. 08326 1399
info-schlossar@mnet-mail.de
19705 hilmxrqI
Landhaus Bollwein B5
Komf. gemütl. 1-, 2- u. 3-Zi-FeWo mit Bergblick und Balkon. Abschließbarer Fahrradraum, Bus und Bahn in nächster Nähe, schöner Garten.
24019 nilmswtq
Michael Schmid
2 FeWos, 44 + 52 qm, 1-5 Pers. FeWo € 54,- bis € 64,- (2 Pers.) Angebote in Nebensaison



Haus Bergland C3
Gemütliche, gepflegte FeWos in ruhiger, sonniger Südlage. Alle FeWos mit sep. Schlafzimmer und Balkon mit traumhaftem Panoramablick.
Rosemarie Jocham
Maderhalm 21 · 87538 Fischen Tel. 08326 1475 mein@urlaubimbergland.de www.urlaubimbergland.de








19862 1imhwxIq
2 FeWos, 35-55 qm, 1-2 Pers. FeWo € 55,- bis 85,- (2 Pers.)
FeWo in ruhiger Lage. Südbalkon mit Panoramablick, gr. Wohnzimmer, sep. Schlafzimmer (getrennt schlafen möglich), Küche, Bad, sep. WC.
Anton Müller
Zum Tannacker 15 87538 Fischen Tel. 08326 1036 · Fax 385481 Haus.Bergsicht@hotmail.de
19835 lijmwxI5
6 FeWos, 50-64 qm, 2-6 Pers. FeWo € 48,- bis 110,- (2 Pers.) je weitere Pers. € 10,-
94 Fischen FERIENWOHNUNG
Familie Anton Besler
Sägestraße 17 · 87538 Fischen Tel. 08326 205 · Fax 7198 info@ferienwohnungen-besler.de www.ferienwohnungen-besler.de
19836 1hjlmxIq
3 FeWos, 64-120 qm, 2-6 Pers. FeWo € 70,- bis 90,- (2 Pers.) je weitere Pers. € 10,- bis 20,-
Sonja Schuster
Dorfstraße 17 · 87538 Fischen Tel. 08326 1604 · Fax 209620 landhausbollwein@gmail.com www.landhausbollwein.de
1ijsxIqz
4 FeWos, 40-78 qm, 1-6 Pers. FeWo € 50,- bis 70,- (2 Pers.) inkl. ER
19864
Hubert Brecheisen
Krokusweg 1 · 87538 Fischen Tel. 08326 7055 hubert.brecheisen@gmx.de
19663 hilmwxIq
1 FeWo, 50 qm, 2 Pers. FeWo € 50,- (2 Pers.)
A2
Haus Ankenbrand
Gästehaus Anna B2
Mühlenstraße 4 · 87538 Fischen Tel. 08326 7026 anfrage@fewo-schmid.de www.fewo-schmid.de Gästehaus Anneliese B3
2 FeWos, 50-60 qm, 2-4 Pers. FeWo € 44,- bis 46,- (2 Pers.) je weitere Pers. € 6,- bis 10,-
3 FeWos, 42-45 qm, 2-4 Pers. FeWo € 47,- bis 65,- (2 Pers.) je weitere Pers. € 8,- bis 10,-
Ferienwohnung Brecheisen B2
Moderne, komfortable FeWo in ruhiger, sonniger Ortsrandlage. Wohnung mit 2 Schlafzimmern und Südterrasse mit Garten, WLAN, Sat-TV im Zimmer.
Beate Eberle
Aurikelweg 8 · 87538 Fischen Tel. 0171 5375829 anfrage@ferienwohnung-dornroeschen.de www.haus-dornroeschen.de
hijlnrq7
1 FeWo, 50 qm, 2-4 Pers. FeWo € 90,- bis 130,- (2 Pers.) je weitere Pers. € 25,- bis 35,-
Ferienwohnung Häusler
Gemütlich eingerichtete FeWos, z.T. 2 sep. Schlafzi., mit Du/WC, Sat-TV, Bergblick, 10 Minuten zum Ortskern. Wanderwege und Loipe am Haus.
24318
Monika Lingemann
Illerstraße 5 · 87538 Fischen-Au Tel. 08326 7087 monika.lingemann@haus-freisl.de www.haus-freisl.de
2 FeWos, 45-80 qm, 1-4 Pers. FeWo € 47,- bis 72,- (1-4 Pers.)
B2
Luxuriöse FeWo, sonnige, ruhige Lage, Süd-/Westbalkon, freier Bergblick, moderne Küche, sep. Schlafzi., Sauna, Infrarotkabine, Parkplatz.
Gemütliche, liebevoll eingerichtete FeWos (2+3 Zi.), ruhige Lage u. freier Bergblick. Großer Garten mit Liegewiese, persönliche Betreuung. 6 Gehminuten zum Ortskern.
19675
Genießen Sie Ihren Urlaub in unseren liebevoll eingerichteten FeWos mit Balkon/Terrasse. Separate Schlafzi., Wohn-/Esszimmer, Küche, Du/WC.
Manuela Buchenberg
Grüntenstraße 3 · 87538 Fischen Tel. 08326 7325 gaisalpe@web.de www.gaestehaus-gaisalpe.jimdo.com










jilwxI4q
1 EZ · 8 FeWos, 29-70 qm, 1-4 Pers. ÜF € 30,- p. Pers. / FeWo € 40,- bis 90,(2 Pers.) / je w. Pers. € 10,- bis 15,-
Ferienwohnung Hilbrand
Ferienwohnungen Hartmann
B2
19843
9 komfortable FeWos im modernalpenländischen Stil mit Balkon oder Terrasse.1exklusiveFeWomitSauna.
Alois Hartmann Zum Tannacker 1 87538 Fischen-Berg Tel. 08326 411 · Fax 866922 info@pension-hartmann.de www.pension-hartmann.de
19880 1himvIbq
9 FeWos, 32-70 qm, 1-2 Pers. FeWo € 83,- bis 153,- (2 Pers.)
Haus Ideal B2

Ruhe u. Entspannung genießen. Liebevoll, gemütlich, ruhige u. zentrumsnahe FeWo mit Südbalkon und Bergblick. Wandern und Langlaufen ab Haus.
Ideale Lage zu tourist. Einrichtungen, vielen Restaurants und Geschäften. 2-R-FeWo mit Balkon und Bergsicht. 3-R-FeWo im EG mit kleinem Garten.
19766 hilwxIbq
Renate und Manfred Häusler Moosäckerweg 3 · 87538 Fischen Tel. 08326 213 · Fax 366972 fewo.haeusler@freenet.de www.ferienwohnung-haeusler.de
1 FeWo, 58 qm, 2 Pers. FeWo € 65,- bis 120,- (2 Pers.) je weitere Pers. € 15,-
3 gemütl. FeWos m. Balkon u. herrl. Bergsicht, in zentraler Lage u. mit 2 Schlafzimmern. Bad mit Dusche und WC, Sat-TV, Telefon, Brötchenservice, Nichtraucherhaus.
Hans-Peter Schmid
Bolgenstraße 8 · 87538 Fischen Tel. 08326 556 · Fax 381530 info@hans-peter-schmid.de www.hans-peter-schmid.de
ijlmnwIq
3 FeWos, 40-90 qm, 2-4 Pers. FeWo € 42,- bis 70,- (2 Pers.) je weitere Pers. € 15,-
19764
19865 1ilnxIrq
Zenzi Heinz Haldenweg 4 · 87538 Fischen-Berg Tel. 08326 7058 gaestehaus-heinz@maxi-allgaeu.de www.gaestehaus-heinz-fischen.de
2 FeWos, 45-85 qm, 1-4 Pers. FeWo € 59,- bis 70,- (2 Pers.) je weitere Pers. € 6,- bis 8,-
Ferienwohnungen Haus Katrin B2
Bei uns daheim! Ankommen und sich wohlfühlen in neu eingerichteten Ferienwohnungen. Seien Sie unser Gast. Kostenloses W-LAN.
Heidrun Mayr
Aurikelweg 2 · 87538 Fischen Tel. 08326 1285 · Fax 385079 info@hauskatrin-fischen.de www.hauskatrin-fischen.de
19774 hilmwxIq
FeWos, 28-43 qm, 1-2 Pers.
FeWo € 35,- bis 65,- (1-2 Pers.)
Agathe Hilbrand Aurikelweg 12 a · 87538 Fischen Tel. 08326 35012 ferienwohnung-hilbrand@web.de www.hilbrand-ferienwohnung.de
23876 ilmIwxq
1 FeWo, 55 qm, 2-3 Pers. FeWo € 51,- bis 57,- (2 Pers.) je weitere Pers. € 15,-
Gemütliche, gepflegte, ausgestattete FeWo mit getrennten Wohn- und Schlafzimmern in zentraler, ruhiger Lage mit Südbalkon und Bergsicht.
Familie Simon Bolgenstraße 10 1/2 · 87538 Fischen Tel. 08326 383968 anfrage@haus-keller-fischen.de www.haus-keller-fischen.de
ilmxIq
2 FeWos, ca. 36-45 qm, 2-4 Pers. FeWo € 45,- bis 50,- (2 Pers.) je weitere Pers. € 10,-
19776
28994 mswxIzrq
Weilerstraße 3 · 87538 Fischen Charivari Ferienwohnungen Tel. 08326 36000 info@charivari-ferienwohnungen.de www.charivari-ferienwohnungen.de

3 FeWos, 60-70 qm, 2-5 Pers. 2 x 2-Raum € 60,- bis 120,1 x 3-Raum € 80,- bis 155,-
3 gemütliche Ferienwohnungen (1-2 Pers.) mit einem herrlichem, freien Panoramablick in ruhiger Ortsrandlage von Fischen-Berg.
Peter Koros Gundelsberger Weg 17 87538 Fischen-Berg Tel. 08326 1214 · Fax 384060 info@gaestehaus-koros-fischen.de www.gaestehaus-koros-fischen.de
3 FeWos, 35-52 qm, 1-2 P. FeWos € 52,- bis 80,- (1-2 Pers.)
19779
Haus Dornröschen B2
1mxrqI7 Haus Freisl A2
Gästehaus Gaisalpe B2
C2
Gästehaus Heinz C2
Hans-Peter‘s Käshütte B2
Haus Keller B2
1ilmnwIq
95 Fischen FERIENWOHNUNG
Gästehaus Koros 1F BBBB / 2F n.k. C2
Ferienwohnung Lang B3
Gästehaus Lydia B2
Gemütl. FeWo in ruhiger, zentraler Lage. Bergblick, Balkon. Liegewiese am Bach, 2 Schlafzimmer, Küche, Wohnzimmer, Sat-TV, Tel., Du/WC.
NR-Haus mit gemütl. FeWos. Ruhige, zentr. Lage, separate Schlafzimmer, Wohnzi. mit Koch- und Essecke, z.T. separate Küche, Du/Bad z.T. separates WC, Süd-West-Balkon.
Willkommen auf der Sonnenseite Fischens. Wir bieten unseren Gästen gemütlich eingerichtete FeWos und Zimmer mit freier Bergsicht. Sat-TV, Aufenthaltsraum, Parkplatz am Haus.
Gemütl. Wohnzimmer, 2 getrennte Schlafzimmer, Küche, Terrasse mit Bergblick, Parkplatz am Haus, gute Bus- und Bahnanbindung.
Sigrid Lang
Mühlenstraße 29 · 87538 Fischen Tel. 08326 8245 · Fax 384166 lang-fewo@web.de www.ferienwohnung-lang.de
19780 hijlmnxI
1 FeWo, 80 qm, 2-6 Pers. FeWo € 50,- bis 60,- (2 Pers.) je weitere Pers. € 10,-
Ferienwohnungen
Nicole B2
Komfortable Nichtraucher-FeWos nur wenige Gehminuten zum Zentrum für 1 5 Personen mit Balkon oder Terrasse und SATTV.
Kurt und Beate Mayer GbR
Aurikelweg 6 · 87538 Fischen Tel. 08326 3857880 fewos-nicole@t-online.de www.fewo-nicole.com
28941 hijlswxI
3 FeWos, 40-68 qm, 2-5 Pers. FeWo € 78,- bis 98,- (2 Pers.) je weitere Pers. € 15,-
Ferienwohnung Schöll
B2
Gemütlich eingerichtete FeWos mit Südbalkon und Bergblick. Zentrumsnah, direkt am Kurpark. Bettwäsche und Handtücher inklusive.
Georg Besler
Am Anger 13 87538 Fischen Tel. 08321 89482 georg.besler@web.de
hilmnwxI
1 FeWo, 40-50 qm, 2 Pers. FeWo € 60,- (2 Pers.) je weitere Pers. € 12,50 / KT inkl.
24026
Antonie Schmidt Weilerstraße 13 87538 Fischen Tel. 08326 562
Antonia.schmidt1@gmx.net
19785 hilmxq5
1 DZ · 4 FeWos (2 Pers.)
ÜF € 27,- p. Pers. / FeWo € 49,(2 Pers.) / je weitere Pers. € 12,-
Ferienwohnung Ruppaner
C2
Meßmang Hans Altstädter Straße 3 87538 Fischen-Unterthalhofen Tel. 08326 572 Fax 209032
1hijklmo
2 DZ, 1 MBZ · 3 FeWos, 36-80 qm, 2-6 P. ÜF € 20,- / FeWo € 38,bis 60,- / je weitere Pers. € 7,-
Ferienwohnungen Sauter
B2
19850
Angelika Mock · Zur Reite 1 87538 Fischen-Langenwang Tel. 0221 9473554 angelika.mock@gmx.de www.ferienwohnung-mock.de
hijklxIz
1 FeWo, 80 qm, 2-4 Pers. FeWo € 49,- (2 Pers.) je weitere Pers. € 10,-
Ferienwohnung
Regina Schmid B2
23946
Gemütl. gepfl. Whg. in ruhiger Lage. Herrli. Bergsicht. Direkt an der Loipe. Ost- u. Westbalkon. Nichtraucherhaus. Keine Tiere.
Gemütlich eingerichtete 2-ZimmerFeWos in zentraler, ruhiger Lage. Küche, Du/WC, Durchwahltelefon, Fernseher, Südbalkon, Parkplatz.
2 gemütl. FeWos für 2-4 Pers., bestehend aus Wohn-/Schlafzimmer, sep. Schlafzimmer, Küchenzeile, Dusche/ WC, Farb-TV, Westbalkon. Nebensaisonpreise.
Hannelore Ruppaner
Achweg 12 · 87538 Fischen Tel. 08326 7878 · Fax 3849850 hermannruppaner@mnet-online.de
23996 hilmIxq
1 FeWo, 55-60 qm, 2 Pers. FeWo € 50,- bis 55,- (2 Pers.)
Ferienwohnung Schratt B2
2gemütl.FeWos,sep.Schlafzi.,kompl. ausgest. Küche mit Spülm. u. Essecke, Kabel-TV, Ost-Südbalkon m. Bergblick. Bettwäsche u. Handtücher inkl. 5 Min. ins Zentrum.
Hermine Schratt Moosäckerweg 2 87538 Fischen Tel. 08326 7848 · Fax 7848 kschratt@gmx.de
hilmwqIx
2 FeWos, 45-55 qm, 2-4 Pers. FeWo € 46,- bis 48,- (2 Pers.) je weitere Pers. € 12,-
19711
Martin Sauter
Sonnenkopfweg 6 · 87538 Fischen Tel. 08326 592 · Fax 9579 info@sauter-fischen.de www.sauter-fischen.de
24000 hilmxq7
3 FeWos, 50-60 qm, 1-2 Pers. FeWo € 46,- bis 55,- (2 Pers.)
C2
Gemütl., familiäre Pension mit einmaligem Bergblick. 5 FeWos mit sep. Schlafzimmern, Wohnküche, Balkon, TV, Komfortbetten, Liegewiese.












Florian Schratt Haldenweg 2 · 87538 Fischen-Berg Tel. 08326 1885 · Fax 381875 landhaus-schratt@freenet.de www.landhausschratt.de
hilnvxqI
5 FeWos, 36-70 qm, 2-5 Pers. FeWo € 36,- bis 44,- (2 Pers.) je weitere Pers. € 5,- bis 8,-
19712
Regina Schmid
Bergerweg 1a · 87538 Fischen Tel. 08326 38117 · Fax 38118 info@ferienwohnung-regina-schmid.de
19707 hilmwxIq
2 FeWos, 35-43 qm, 2-4 Pers. FeWo € 49,- (2 Pers.) je weitere Pers. € 10,-
Ferienwohnungen Schroth C1
Genießen Sie Ihren Urlaub in gepflegten FeWos in ruhiger Lage. Süd- und Ostbalkon mit Bergblick. Nähe Loipe, Rad- und Wanderwege.
Sieglinde Schroth
Weiler 11 · 87538 Fischen-Weiler Tel. 08326 9074 Fewo-schroth@t-online.de www.ferienwohnungen-schroth.de
19812 1ijmswIq
2 FeWos, 45-60 qm, 2-4 Pers. FeWo € 47,- bis 52,- (2 Pers.) je weitere Pers. € 10,-
Ferienhof Meßmang A1
Mock B5
Ferienwohnung
Landhaus Schratt
96 Fischen FERIENWOHNUNG
Schönes Landhaus in Fischen-Langenwang mit 3 FeWos. Herrlicher Blick auf die Berge von Oberstdorf. Ab Haus schöne Wander- u. Radwege.




Magdalena Schwarz
Sägestraße 2 · 87538 Langenwang Tel. 08326 1685 post@landhaus-schwarz.info www.landhaus-schwarz.info
1hiklmsx
3 FeWos, 38-60 qm, 2-4 Pers. FeWo € 42,- bis 52,- (2 Pers.) je weitere Pers. € 10,-
Gästehaus Vogler B5
24036
Exklusive FeWo im OG, Panoramabergsicht, großer Südbalkon/Markise, Kachelofen und Komfort-FeWo mit sichtbarem Holzgebälk im DG. Ruhiges NR-Haus.
Hans Steinbrenner
Zum Tannacker 4e · 87538 Fischen Tel. 08326 602 o. 07144 6586 haus_sonnenbergle@web.de www.steinbrenner-fewo.de




hilmxIrq
2 FeWos, 46-60 qm, 2 Pers. FeWo € 75,- bis 90,- (2 Pers.)
23864
Ferienwohnung Speigl
Sonnige, ruhige und zentrale Lage, Bergblick, Gartenhausterrasse. Nähe Bushaltestelle/Bahnhof & LL-Loipe. Getränkeservice. NEU: W-LAN
Liebevoll, hell eingerichtete FeWo in sonniger, ruhiger Lage. Südbalkon, freier Berg- und Wiesenblick. Loipe/ Rad-/Wanderwege in direkter Nähe.
Liebevolle Komfort-FeWo mit Bergblick. Wander- und Radwege sowie Langlaufloipe in direkter Nähe. 10 Minuten zu Fuß ins Ortszentrum.
Florian Speigl
Gerberstraße 11 · 87538 Fischen-Au Tel. 08326 384800 info@speigl.de www.speigl.de
hikmwIq
1 FeWo, 36 qm, 2 Pers. FeWo € 54,- bis 62,- (2 Pers.)
19818
Trettachblick
Wirbieteneine lichtdurchflutete 60 qm große FeWo mit großem Südbalkon, m.BlickaufdieAllgäuerAlpen.KinderSchlafsofa im Wohnbereich.
Rita Damaschun
29504 hilmwIqx
1 FeWo, 60 qm, 2-4 Pers. FeWo € 80,- (2 Pers.) jede weitere Pers. € 15,- ab 6 Jahre
Martina Vogler
Dorfstraße 11 87538 Fischen-Langenwang Tel. 08326 9782 · Fax 384265 www.voglerlangenwang.de
19685 1hjknsw4
Marianne und Toni Vogler
Am Burgstall 8 · 87538 Fischen-Au Tel. 08326 9046 info@toni-vogler.de www.toni-vogler.de
19718 hilmxqI
Tagungen, Seminare, Hochzeiten, Events
Perfekt arrangiert im Premiumpanorama 1500 qm Ausstellungsfläche, ein Festsaal mit professionell ausgestatteter Bühne und konzerttauglicher Akustik, ein Musikpavillon im Park. Die Räume können flexibel verbunden, die Technik individuell erweitert, und die Bestuhlung angepasst werden. www.fischen.de Kurhaus Fiskina
97 Fischen FERIENWOHNUNG
Landhaus Schwarz
B5
Haus Sonnenbergle C2
A2
Maderhalm 12 · 87538 Fischen Tel. 08326 3089997 h.damaschun@web.de www.hoernerdoerfer.de/ TrettachblickFischen C3
2 FeWos, 36-90 qm, 2-7 Pers. FeWo € 32,- bis 76,-
1 FeWo, 60 qm, 2 Pers. FeWo € 52,- bis 56,- (2 Pers.)
FeWo Marianne & Toni Vogler A2
Ofterschwang HörnerDörfer
Urlaub in Ofterschwang verwöhnt mit Ausblicken und unvergesslichen Gipfelerlebnissen, denen man mit dem Weltcup-Express bequem näherkommt und mit Einblicken in die Geschichte des Dorfes, welche im urigen Bauernhaus „Busche Berta“ entdeckt werden kann. Eine Schnapsbrennerei, ein Käse- und Schinkenkeller sowie eine Töpferei sorgen für handwerklichen Genuss.
Zwischen Berg und Tal sorgen Wander- und Radwege für reichlich Bewegungsspielraum und Hütten und Alpen für eine ausgiebige Stärkung, die dank des Qualitätsversprechens „Gutes vom Dorf“ ein echtes Geschmackserlebnis ist.

Als Alternative zum Wandern bieten sich ein klassischer 18-Loch Golfplatz oder Frizbee-Golf am Berg, eine Fahrt mit dem Downhill-Roller oder eine Sennereiführung an.

Im Sommer punktet Ofterschwang mit dem einzigartigen Eisladen in der Dorfmitte, im Winter mit seiner FIS-Weltcup-Abfahrt, einem Kinderland an der Bergstation, Loipen für jedes Niveau und einer erlebnisreichen Rodelpiste
Zudem findet hier alle zwei Jahre der Damen-Weltcup im Slalom statt.
98
im WeltcupDorfGenussvoll








Weltcup-Express Genusswanderung Bauernhaus
Berta“ Winter-Schneespaß Weltcup-Piste Gutes vom Dorf 99
„Busche
Für Kfz gegen Gebühr Für Kfz gesperrt
Kindergarten Schule Post
Feuerwehr Gaststätte ganzjährig Gaststätte zeitweise Highlight
Kirche Kapelle Aussichtspunkt 0 500250
Kartengrundlage outdooractive Kartografie Geoinformationen © Outdooractive © GeoBasis-DE / BKG 2020
Hauskoordinaten; Wiedergabe mit Genehmigung des Landesamt für Vermessung und Geoinformation Bayern, Nr. O 1419 VM A-1945/09.
24 24 22 22a
E t t er
1/2 Reitstall
Reitstall Kneippanlage Spielplatz siehe Detailausschnitt rzo hs
Wittelsbacherrunde 100
ief

ORTSPLAN OFTERSCHWANG Ofterschwang Muderbolz Schweineb Bettenried Hüttenberg Oberzollbrü Gunzesried Wielenberg Vorderer Hüttenberg Salzhalde ImLoch ImWinkel e tt Klausebuckel-Hütte Kuckucksnest e O be r ge ißrü ck e n to bel Wiesholztobel Bachtobel 1406 1015 1 Birkenbichl-Hütte Hellmann-Hütte Alpe Eck Oberegg-Alpe Buchenschwand-Alpe Horn-Alpe Mautstraße 1170 Dietrichs Sigiswang Si 1527 Tiefenberger Moos Hüttenberger Eck Sigiswanger Horn rn Ofterschwanger Horn Reichenbach Lußbach K r e b s b ach Haslachbach E t t e r s b a c h Ettersbach E t t ersb ach Mühlbach Riedbach Leitenbach Ga ißkop fbach Hornbach 20 21 22 23 26 27 29 30 33 35 3 4 5 6 7 8 9 17 13a 15 16 10 9 11 13 14 16 1 22 3 4 6 2 4 11 14 15 16 19 1 20 32 1 2 4 5 6 7 7 8 1 10 11 12 13 14 15 17 18 19 1 2 20 21 22 23 24 24 25 26 26 28 29 2 30 33 35 39 3a3 40 42 43 25 2 34 13 22 22a 32 41 8 4 7 9 28a 44 16 32 1 1 2 3 645 7 8 37 31 5 4 1314 15 16 33 5 10 13 5a 4 5 27 64 17 10 45 46 47 48 49 50 51 52 53 54 55 56 57 58 59 5 5a 61 62 63 6 6a 9 9 1211 2 2a 3 4 6 7 8 Restaurant Waldhaus Golfplatz 18 Loch 1/2 1/2 1/2 1/2 1/2 1/2 1/2 Hotel Allgäuer Berghof (1206 m) 25a Reitstall Disc-Golf Parcours 22a 17 26a Ofterschwanger Haus Leitenbach Hütte Alpe-Eck-Lift Ossi-Reichert-Bahn Schlitte Hütte Bergbahn Ofterschwang Festplatz Bergbauernsennerei Hüttenberg Bauhof Wertstoffhof Vollwert Bäckerei Kornblume Wittelsbacherrunde H o c hwiesweg runde Hochbichl Hütte 1200 m Weltcuphütte 1320 m Sommer-Weltcup-Express und Winterbetrieb Gipfel-6er Ofterschwanger Horn Rundweg Panoramaweg Panoramaweg Fahngehren-Alpe N a t u r l eh r pf ad Bergwiesenrundweg Hörner-Panorama-Tour Richtung Bolsterlang Wurzelhütte Berghaus Blässe Kahlrücken-Alpe Schwinggund-Alpe Dorfladen Oftersc hwang e r Do r f r u n d e Landhotel Alphorn Skischule und -verleih Pizzeria Cortina Ossi-Reichert-Bahn Busche Berta Stuimän dleweg 1 AB C D ABCD 2 3 4 5 6
Gästeamt Golf Parkplatz
Einkaufen Bushaltestelle Hundetoilette chw




S 734 Sigishofen Tiefenberg Seewendel 74 ImMoos Schießstand Schießs t AllgäuSchwimmhalle Gede Le Am alten Berg Krebsbachto be l Westerhofen chweineberg rzollbrücke 882 734 Illersiedlung Altstädter Mühle d hs iefenberger Moos Wittelsbacher Höhe M ü h l b a c h K r eb sb a ch E t t ersb ach I l l er Giesenbach G i e ß b a c h Sonthofen 2826 2 30 10 11 12 13 14 15 17 20 21 22 23 25 26 27 28 29 2 30 31 35 36 37 37 38 39 3 40 41 43 43a 44 46 47 48 49 4 51 53 53a 55 56 57 58 59 5 5a 60 61 62 63 63a 66 67 68 6 6a 70 7 7a 9a 1 10 11 11a 12 13 14 15 16 18 31 32 33 34 36 37 38 39 4 5 66a 7 8 9 11 12 13 17 20 21 22 23 24 26 27 28 2 30 3 4 6 7 8 9 10 11a 12 13 13 14 14 15 16 18 20 21 22 23 25 26 27 28 29 2 31 32 32a/b 3333a 34 34a/b 37 38 39 3 4 41 42 43 44 45 4 5 6 6a 7 8 9 9a 1 1819 1 20 21 23 24 25 25 26 27 2828a 29 2 31 32 32 334 35 36 37 38 3 4 4040a 50 50a 51 51a 52 52a 41 42 44 45 46 494847 4 5 53 54 55 5 6 7 8 9 24 39 32 36 22a 19 56 35 15 29 8d 30 14 9 57 9 1 46474849 50 1 40 31 8 27 24 24a 19 33 42 42a 30 39 55a 8a 11a 16 33 52 24 5 11 8b 18 19 1 25 32 5a 35 53 13a 10 11 12 13 14 15 16 17 18 19 1 20 21 22 23 24 25 B19 B19 8c Hotel Sonnenalp 1/2 1/2 1/2 1/2 1/2 1/2 1/2 1/2 1/2 1/2 1/2 Inizio 3 3 58 64 70 69 666768 65 63 6261 60 55 57 51 54 56 34 71 60 61 25a 6b 6c 13a 1a Bauhof Wertstoffhof Vollwert Bäckerei Kornblume Schlachthaus Sonthofen Illerstadion Schießstand Bergkäs Sennerei Schweineberg Wittelsbacherrunde Moosrundweg Ski- und Langlaufverleih Holzalpe Freistil Silberdistel E F EF 1 2 3 4 5 6 Ofterschwang 22b 24 24a 25 25a 26 2 3 3a 3b 4 5 6 3a 8 9 1 2 3 4 5 6 7 10 11 12 13 14 15 15a 16 17 18 19 21 4 5 6 7 8 9 1 2 33a/b 5 5a/b 7 7a/b 1 2 3 5 1 2 5 7 9 10a10 1111a 12 13a 14 11a 2 3 4 4a 5 6 6a 7 8 8a 1 3 4 6 1 2 2a 3 1 2 10 11 11a 12 13 15 16a 17 18 18a 1 20 22a 13 2 3 20a 4 14a14 1 24b 6 2 16 1a OA5 OA 5 Dor fs t ra ße Dor fs t r a ße AufderSteig Am Luß Leitenweg P a n o r amaweg Am To be l Panoramaweg Enggasse 25 4 3 2 1 19 21 23 22d 6a 5a5b Bergbahn Ofterschwang Ofterschwanger Haus Dorfladen Gästeinformation Ofterschwang Kriegerdenkmal zur Hausnummer 15 Schlitte Hütte Leitenbach Hütte Festplatz Kirchgasse O i bweg Landhotel Alphorn A m F a h n e n Skischule und -verleih Pizzeria Cortina H ö r n e r w e g Busche Berta Kirchgasse oMosw e g
101
Bauerngasthof Café Mayr
Familie Michael Schmid
Dorfstraße 5 · 87527 Ofterschwang Tel. 08321 3536 · Fax 6189930 info@pension-hoernerblick.de www.pension-hoernerblick.de

Haus mit zwölf liebevoll eingerichteten Zimmern und zwei Familien-Appartements. Alle ausgestattet mit Balkon oder Terrasse, TV, W-LAN, Tiefgarage u.v.m. NEU seit 2020 vier komfortable Ferienwohnungen und großer Spielplatz. Moderne Sauna-Landschaft auf über 100 m2 mit 60°, 90° und Infrarot. Halbpension mit reichhaltigem Frühstücksbuffet und 4-GangMenüamAbend,sowieGrill-und Hüttenabenden während der Sommermonate.
10 DZ, 19-26 qm, 2-3 Pers.
2 DZ-App., 33 qm, 2-4 Pers.
2 Fam.-App., 47-55 qm, 2-6 Pers.
4 FeWos, 62-78 qm, 2-6 Pers.
Zimmer mit HP: € 86,- bis 116,- pro Pers. Fewo:

€ 145,- bis 210,- pro Wohnung
Pension zum Engel C4
C4
Familie Pöschl / Bernd und Jörg Pöschl GbR Kirchgasse 18 · 87527 Ofterschwang Tel. +49 (0)8321 6634-0 · Fax 6634-59 info@landhotel-alphorn.de · www.landhotel-alphorn.de
Das Hotel mit Weitblick. Der unverbaute Rundumblick ist über die Grenzen sehr bekannt. Gemütlich und komfortabel sind die Zimmer im persönlich geführten und ruhig gelegenen Landhotel. Fast alle glänzen mit einem Balkon, Terrasse oder Wintergarten. In rustikalen Gaststuben im Restaurant verwöhnt die frische, heimische Küche. Außer Haus Gäste auf Anmeldung. Die Sonnenterrasse mit Duft-Kräutergarten und unser Service ist der Hit! Direkt vor unserer Haustüre liegt das 45-Loch Golfresort Oberallgäu. In 8 Gehmin. sind Sie an der Bergbahn des 2-Täler Ski- u. Wandergebietes! Herrlich ausgebautes Wanderwegnetz, Nordic-Walking-Wege und Loipen direkt ab Haus! Machen Sie mit dem Wirt und Alphorn eine Bergtour oder einen Alphorn-Lern-Kurs
Gästehaus Alpenrose




Klaus Finkel Tiefenberg 7 87527 Ofterschwang Tel. 08321 4220
he1imnvq
Haus Haberstock C4

Schöne Zimmer u. Appartements, alle Du/WC/KÜCHE/TV/W-LAN, größtenteils Balkon mit freier Bergsicht, Wohnecke. Gast- und Seminarräume.
Thomas Tröbelsperger Dorfstr. 8 + 10 87527 Ofterschwang Tel. 08321 2592 pensionengel@t-online.de www.pensionzumengel.de
22716 chmvIbq6
1EZ,4DZ,3MBZ,7FeWos,28-75qm,2-8P.
ÜF € 28,- bis 66,- / FeWo € 42,- bis 119,(2 Pers.) / je w. Pers. € 11,- bis 16,-
Familiär – Urlaub wie Zuhause. Genießen Sie unsere gemütliche FeWo und unsere Zimmer im Landhausstil. Im Herzen von Ofterschwang!
Alois Haberstock Kirchgasse 2 87527 Ofterschwang Tel. 08321 1278
eiklxq
1 DZ, 1 FeWo, 58 qm, 2-4 Pers.
ÜF € 34,- / FeWo € 35,- (2 Pers.) je weitere Pers. € 5,-
24101
Moderne Zimmer und Appartements (2-4 Pers.) sowie FeWo (2-5 Pers.). Neu: Außergewöhnlich schöner Frühstücksraum.MehraufunsererWebsite.
Albert Barth · Westerhofen 27 87527 Ofterschwang Tel. 08321 2507 · Fax 724149 info@haus-kanstein.de www.haus-kanstein.de
cijlmxIq
2 DZ · 3 App., 35-40 qm · FeWo, 85 qm ÜF € 32,- bis 45,FeWo € 70,- bis 90,- (2 Pers.)
22734
Familiäres Gästehaus mit Bergblick, Frühstücksbuffet. Neue, große, komfortable FeWo mit zwei Schlaf- und Duschräumen buchbar.

Herbert Socher mit Familie Tiefenberg 30 · 87527 Ofterschwang Tel. 08321 3759 socher-ofterschwang@t-online.de www.elfriede-ofterschwang.de
22713 cijlmvIq
€ 120,- bis 160,-
Neu renovierte gemütl. FeWos u. DZ, mit Dusche und WC, z.T. Balkon, gr. Garten, Liegewiese, Kinderspielpl., Freibad, Sauna, ruhige Lage.

Cornelia Pohl Sigiswang 20 · 87527 Ofterschwang Tel. 08321 82855 cornelia.pohl@ferienhaus-ammuehlbach.de www.ferienhaus-am-muehlbach.de
1 DZ, 6 FeWos, 36-50 qm, 2-4 Pers. FeWo € 64,- bis 96,- (2 Pers.)
22743
102
HOTEL · PENSION/GÄSTEHAUS/FERIENZIMMER
Ofterschwang
Landhotel Alphorn aaaSuperior
vwb37I 2 EZ, 15 DZ, 1 Junior Suite, 1 Apartment ÜF € 75,- bis 140,HP € 85,- bis 150,zzgl. Gästeabgabe Angebotswochen anfragen! 22699 C4 cnowxIb5
chmnos
22731 Gästehaus-Pension Hörnerblick
1 EZ, 2 DZ, 1 FeWo ÜF € 28,- bis € 32,FeWo € 50,- bis € 56,-
Ruhig und gemütlich und doch mittendrin. Reichhaltiges Frühstück, Südbalkon und das Tiefenberger Moor ganz in der Nähe.
24134
1 EZ, 3 DZ, 1 MBZ, 1 FeWo,
ÜF EZ € 48,- bis 63,- / ÜF
42,-
57,-
/
E5
80-110 qm
DZ €
bis
(p. Pers.)
FeWo
Gästehaus Elfriede E5
Gästehaus Kanstein E2
1ilmIrbq
Ferienhaus am Mühlbach C6
Gemäß dem Motto „draußen herrlich – drinnen herzlich!“ freut sich unsere Familie, Sie begrüßen zu dürfen. Wir sind mit Leib & Seele Gastgeber! Gudrun Frey-Wechs und Cornelia Wechs-Schenker GbR Muderbolz 11 · 87527 Ofterschwang Tel. 08321 81940 gaestehaus.wechs@gmail.com www.wechs-ofterschwang.de
1hijmsrq
1 App, 2 FeWos, 15-85 qm, 2-4 Pers. Single App € 45,FeWo € 70,- (ab 2 Pers.)
Ferienwohnung Fröhlich
1F BBBB E2
22758
Neubau-FeWo, großer Wohn-Essbereich mit Kaminofen und kompletter Küche. Du/WC mit Sauna, Südbalkon. 3 Gehminuten zur Bergbahn/Skilift.
1F BBBB / 1F n.k. C4
Ferienwohnungen
Am Fahnen 2F BBBB C4
Sehr komfortable und geräumige FeWo mit zwei separaten Schlafzimmern in ruhiger, westlicher Lage für maximal 4 Personen.
Rainer Fröhlich Westerhofen 55 a 87527 Ofterschwang Tel. 003138 4532932 info@frohlich.nl www.allgaeu-fewo-froehlich.de
26065 mz5l4wIj
1 FeWo, 80 qm, 2-4 Pers. FeWo € 80,- bis 100,- (2 Pers.) je weitere Pers. € 10,-
Ferienhof Auffinger
Carola Sowa
Hörnerweg 6 a · 87527 Ofterschwang Tel. 08321 83289 · Fax 83289 bergblick-lodge@gmx.de www.bergblick-lodge.de










26068 jlmwxIbq
1 FeWo, 80 qm, 2-4 Pers. FeWo € 130,- bis 180,(2-4 Pers.)
2 traumhaft schöne FeWos direkt an der Weltcup-Bahn. Mit Sauna, Kamin, im Allgäuer Stil hochwertig eingerichtet. Jedes Schlafzi. mit eigenem Bad. Alexander Prey Panoramaweg 6 87527 Ofterschwang Tel. 0151 68015026 casamontana-allgaeu@web.de www.casamontana-allgäu.de
28788 himwIbq5
2 FeWos, 80-140 qm, 2-6 Pers. Preis je nach Saison, siehe Website
Großzügig und komfortabel. Toplage, 2 Gehminuten von Bergbahn/Skilift. Traumhafte Bergsicht von S-Terrasse & Balkon. Exklusive Ausstattung.
Wir bieten Ihnen Erholung & Urlaubsgenuss in unseren 3/4-Sterne FeWos mit einmaliger Aussicht vom Südbalkon/-terrasse in die Allgäuer Bergwelt.
voll bewirtschafteter Bauernhof mit Kühen und Kleintieren und viel Platz zum Spielen.
22745 qjlnsIz
Josef Müller Tiefenberg 10 · 87527 Ofterschwang Tel. 08321 86764 · Fax 65233 info@landhausmueller.de www.landhausmueller.de
4 FeWos, 65 qm, 2-4 Pers. FeWo € 80,- bis 120,- (2 Pers.) je weitere Pers. € 10,-
Eberle Sieglinde Muderbolz 2 · 87527 Ofterschwang Tel. 08321 82395 info@ferienhof-ofterschwang.de www.ferienhof-ofterschwang.de
24148 hilmnosw
1 DZ · 1 FeWo, 56 qm, 2-4 P. ÜF € 29,- (p. Pers.) FeWo € 90,-
Ludwig Auffinger
Heike und Thomas Schneider
Am Fahnen 4 · 87527 Ofterschwang Tel. 08321 787462 · Fax 88958 info@fewo-am-fahnen.de www.fewo-am-fahnen.de
28792 hjlmwIz5
2 FeWos, 120 qm, 2-4 Pers. FeWo € 170,- bis 190,- (2 Pers.) je weitere Pers. € 10,-
Hof in ruhiger Ortsrandlage, große Liegewiese, Spielplatz, Grill- u. Wandermöglichkeiten. FeWo mit Du/WC, W-LAN, Küchenzeile mit Wohnraum.
Herbert Mayr mit Familie Hüttenberg 22 · 87527 Ofterschwang Tel. 08321 71724 · Fax 6076021 info@mayrhof.de www.mayrhof.de
22739 1hijlmsI
1 FeWo, 64 qm, 2-5 Pers. FeWo € 70,- bis 100,- (2 Pers.) je w. Pers. € 10,- / inkl. ER & KT
Hüttenberg 5 · 87527 Ofterschwang Tel. 08321 22673 · Fax 618727 info@ferienhof-auffinger.de · www.ferienhof-auffinger.de
Unser Bergbauernhof mit separatem Gästehaus liegt in Alleinlage auf einem ruhigen, sonnigen Plateau auf über 800 Metern. Hier sind die Allgäuer Gipfel zum Greifen nah und die Aussicht ist herrlich, es sind nur wenige Minuten zu zahlreichen Ausflugzielen, Skigebieten und den schönsten Gipfeln der Allgäuer Berge. Das Ofterschwanger Horn mit seiner Bergbahn und dem Skigebiet ist nur 2 km von unserer Haustür entfernt.
103 Ofterschwang PENSION/GÄSTEHAUS/FERIENZIMMER · FERIENWOHNUNG
Gästehaus Wechs
D5
Bergblick Lodge
1F BBBB C4
Casa Montana
Landhaus Müller 3F BBBB / 1F BBB E5
Familienfreundlicher,ruhiggelegener,
Ferienhof Eberle 1F BBB C5
Mayrhof 1F BBB D2
1jlmno swIq 3 FeWos, 48-70 qm, 2-5 Pers. FeWo € 60,- bis 70,- (2 Pers.) je weitere Pers. € 10,- bis 15,inkl. Kurtaxe 22700 D2
Ofterschwang
Ferienwohnung Kim
Ansprechpartner: Karin Müller
Inhaberin: Iris Roscher
Kirchgasse 6 87527 Ofterschwang Tel. 08321 9630
hijlmwx5
Ferienwohnungen Blick in die Berge
Modern ausgestattete 3 Zi. FeWo mit traumhaftem Bergblick. Großes, familienfreundliches Skigebiet 8 Gehmin, entfernt (18 variantenreiche Pisten km mit modernen Sessel- & Kabinenbahnen). Wander- u. Loipenwege direkt vor dem Haus, sowie Touristeninfo u. Bushaltestelle in Sichtweite. Sommer-Geheimtipp mit Spaßgarantie: Bergroller mieten! Zur Whg.: 2 Bäder (Wanne u. bodengl. Du.), 2 Schlafzi. mit Doppelbetten, TV, vollaugstattete Küche u. Terrasse mit angrendzendem Garten. BittebringenSielediglichIhreeigenen Handtücher mit.
1 FeWo, 85 qm, 2-5 Pers. FeWo € 65,- (2 Pers.) jede weitere Pers. € 10,Kinder: bis 6 J. frei, 7 - 17 J. € 8,-
Chalet F C4
Ferienwohnungen mit herrlichem Alpenrundblick. 3 Wohnungen, komplett eingerichtet, mit Balkon. Liegewiese, große Terrasse u. ruhige Lage.
Ferienhof
E2
Zwei stilvoll eingerichtete FeWos mit Balkon und traumhaftem Bergblick. Hochwertige Ausstattung. Perfekte Lage für Sommer- und Winterurlaub. Matthias Christoffel Westerhofen 41 & 45 87527 Ofterschwang Tel. 0172 6111728 kontakt@blickindieberge.de www.blickindieberge.de









hilmxIz5
Ferienwohnung
Horizont E5
28831
Luxus-Ferienwohnung mit herrlichem Bergblick. 3 Schlafzimmer, 2 Bäder, großer Wohn- und Essbereich, offene Küche. Großer Balkon mit Esstisch, exklusiver Sauna- u. Fitnessbereich. K. u. F. Fässler · Panoramaweg 21 87527 Ofterschwang Tel. 08321 6185862 info@chalet-f.de www.chalet-f.de
lmwxIzb5
1 FeWo, 190 qm, 2-6 Pers. Detaillierte Preise auf Anfrage oder im Internet
Intas Ferienwohnungen C4
29141
Modern u. komfortabel ausgest. FeWo mit traumh. Rundum-Bergblick, gr. Terrasse, Außenpool u. PanoramaSauna. Toplage für Freizeitaktivitäten.
Komfortable FeWo mit Balkon, prächtiger Blick in die Berge, ruhige Lage, nahe Welt-Cup-Sessellift, Parkplatz, Küche, Telefon, Internet, TV.
Ruhig gelegener Bauernhof in Ortsrandlage. Große Wohnküche, Wohnschlafraum & sep. Schlafraum. FeWo ab 4 Nächten buchbar.
22708 imnxIqh
Margit Deschler mit Familie Hüttenberg 15 · 87527 Ofterschwang Tel. 08321 4146 · Fax 619725 Bergblick-Huettenberg@t-online.de www.Bergblick-Huettenberg.de
3 FeWos, 45-70 qm, 2-4 Pers. FeWo € 49,- bis 68,- (2 Pers.) je weitere Pers. € 12,-
Landhaus Edelweiß C6
24141 hilmnosI
2 FeWos, 62 qm, 2-4 Pers FeWo € 43,- (2 Pers.) je weitere Pers. € 6,-
Ferienwohnung
Hartl B5
Alpen-Panoramaaussicht, ruhige Lage, FeWos mit Backofen, Spülm., Terrassen, großer Garten, Planschbecken, Tischtennis, Grill, rustikaler Aufenthaltsraum, Sauna. Caroline Schwarz Sigiswang 29 · 87527 Ofterschwang Tel. 08321 7805741 · Fax 22167 info@berg-urlaub.de www.berg-urlaub.de
22712 1noswxIr
Landhaus Kogel D2
Ruhige Lage oberhalb des Dorfes. Freier Blick auf die Berge. Geräumige, gemütlich eingerichtete Ferienwohnung für 2 Personen.
Haus in ruhiger Lage, 2 FeWos, max. 4/6 Pers., Schlafzi. m. Bad, Wohnzimmer, Küche, Bettwäsche u. Handtücher. Terrasse, Garten und Grill.

22724 hilmxqI
Anita u. Alfons Hartl Sigiswang 35 87527 Ofterschwang Tel. 08321 85775 hartl.fewo@web.de
Kräuterhof Bächle-Waibel D2
Neuer Bauernhof in Top-Lage mit viel Begeisterung für Kräuter & Tiere. FeWos mit 2 getrennten Schlafzimmern und großzügiger Wohnküche. W-LAN, Parkplatz am Haus.
Silke Busch
Tiefenberg 1a 87527 Ofterschwang Tel. 08321 7807739 fewo.horizont@freenet.de

29929 swxIrabq
Josef Fröhlich · Panoramaweg 6a 87527 Ofterschwang Tel. 08321 87580 · Fax 786550 intas-ferienwohnungen@gmx.de www.intas-ferienwohnungen.de
14361 hilmxIq
1 FeWo, 86 qm, 2-4 Pers. FeWo € 80,- bis 86,- (2 Pers.), je weitere Pers. € 10,-
Dr. Karin & Dirk-Alexander Kogel Hüttenberg 29 · 87527 Ofterschwang Tel. 08321 6764275 Post@Landhaus-Kogel.de www.Landhaus-Kogel.de
29589 himnswIq
2 FeWos, 60-110 qm, 2-6 Pers. FeWo EG € 84,- bis 92,- / DG € 128,bis 148,- (2 Pers.) / je w. Pers. € 10,-
Waltraud Bächle-Waibel
Bettenried 4 · 87527 Ofterschwang Tel. 08321 800322 bergbauernhaus-baechle@web.de kraeuterhof-baechle-waibel.de 1jlmoswq
2 FeWos, 65 qm, 1-5 Pers. FeWos € 67,- (2 Pers.) je weitere Pers. € 8,- / inkl. Kurtaxe
104
FERIENWOHNUNG
C4
D2
Bergblick
Herbert Bietsch Westerhofen 3 87527 Ofterschwang Tel. 08321 82546 · Fax 609324 ferienhof-bietsch@mnet-mail.de www.ferienhof-bietsch.de Bietsch E2
2 FeWos, 50-65 qm, 2-4 Pers. FeWo € 60,- bis 75,- (2 Pers.) je weitere Pers. ab 11 Jahren € 5,-
5 FeWos, 50-66 qm, 2-5 Pers. FeWo € 60,- bis 95,- (2 Pers.) je weitere Pers. € 10,- / zzgl. Kurtaxe
1 FeWo, 55 qm, 2 Pers. FeWo € 59,- bis 62,- (2 Pers.) Inkl. ER & KT
1 FeWo, 62 qm, 2-3 Pers. FeWo € 120,- bis € 140,- (2 Pers.) je weitere Pers. € 18,-
24936
Kuckucksnest
Haus Mooswiese
Illertal. 1 FeWo im renovierten Altbau und 1 FeWo im Neubau.

24152 sbqnwrlj
Ferienwohnung Talblick D2
Gästehaus mit herrlichem Bergblick. Sehr gemütl. u. großzügige FeWos m. Balkon od. Terrasse. Ganz in d. Nähe: Wanderwege, Skilift u. Gastronomie. Parkplatz am Haus m. E-Tankstelle. Familie Gisela und Anton Greif Dorfstr. 24 a · 87527 Ofterschwang Tel. 08321 667213 · Fax 667214 info@gisela-greif.de www.fewo-ofterschwang.de C5

Schmid´s Ferienwohnungen C4
Ferienhof Schneider
D1
Andrea Socher-Brutscher Hüttenberg 13 1/2 87527 Ofterschwang Tel. 08321 677018 ferienwohnung-talblick@t-online.de www.ferienwohnung-talblick-allgäu.de


28800 1jmwxq
Andreas Schmid
Panoramaweg 5 87527 Ofterschwang Tel. 08321 7862640 · Fax 7862641 info@S-Fewo.de · www.S-Fewo.de
29142 51jmosIb

4 FeWos, 106-120 qm, 4 Pers. FeWo € 170,- bis 225,-






Andreas Schneider Hüttenberg 64 · 87527 Ofterschwang Tel. 08321 71728 rosi.schneider@gmx.de www.schneider-ferienhof.de
1ijmowIq
2 FeWos, 62 qm, 2-4 Pers. FeWo € 63,- (2 Pers.) / je w. Pers. € 12,- Kinder bis 1 J. frei / inkl. aller NK
26071
Die Erzeugung von Heumilch ist die ursprünglichste Form der Milchproduktion. Die Heumilch für unseren Bergkäse wurde mit dem EU-Gütesiegel g.t.S. - garantiert traditionelle Spezialität ausgezeichnet. DahinterstehtunserTeamderLandwirte,die täglichdiefrischeHeumilchinunsereSennerei liefern. Dort entsteht aus besten Rohstoffen ein herzhafter Käsegenuss.

SCHWEINEBERG
Schweineberg 18 D-87527 Ofterschwang Tel. (08321) 3363 www.allgaeuer-bergkaese.de
SENNEREI
Käsereiführung: Jeden Dienstag, 10.30 Uhr oder nach Vereinbarung Öffnungszeiten: Mo-Do von 8 bis 11.30 Uhr und von 17.30 bis 19 Uhr Fr/Sa von 8 bis 11.30 Uhr und von 16 bis 19 Uhr So/Feiertag von 16 bis 19 Uhr Ofterschwang WIR MACHEN KÄSE. Heumilch Und zwar guten! Neu: Mit dem neuen Automaten gibt‘s Käse rund um die Uhr! Pistenspaß auf der Weltcup-Abfahrt www.hoernerdoerfer.de Skigebiet Ofterschwang 105 Ofterschwang FERIENWOHNUNG 2 FeWos, 130 qm, 5-8 Pers. FeWo € 1.000,- bis 1.500,-/Wo (4-5 Pers.) je weitere Pers. € 100,-/Wo
gr. FeWos in ehem.
herrlicher Aussichtslage über
Zwei
Berghaus in
dem
Dr. Ute Weiglein-Gillitzer Hüttenberg 40 87527 Ofterschwang Tel. 08321 1202 uwgundrg@web.de www.kuckucksnest-allgaeu.de C1
5 FeWos, 40-85 qm, 2-6 Pers. FeWo € 80,- bis € 150,- zzgl. Kurbeitrag, je nach Saison/Personen
22742 hjlswxIb
Wohlfühlatmosphäre wie Zuhause. Appartement in ruhiger Lage mit traumhaftem Bergblick, geschmackvoller Einrichtung und privater Sauna.
Schöner Bauernhof mit traumhafter Aussicht in die Berge u. ruhiger Lage. Die FeWos sind großzügig, gemütlich und komfortabel, mit komplett eingerichteter Küche.
1 FeWo, 78 qm, 2-4 Pers. FeWo € 62,- bis 68,- (2 Pers.) je weitere Pers. € 10,- bis 15,- / ER
In unserer großzügigen FeWo können Sie sich auf zwei Balkonen bei großartigem Tal- und Bergblick vom Stress des Alltags erholen!















WOW!! UnserPLATZ AN DER SONNE 1 POW! MEHRFACH AUSGEZEICHNETE SKIGEBIETE Vielseitige Wandergebiete – von leicht bis anspruchsvoll • herrlicher Panoramablick • Deutschlands schönste Blumenberge • zün ige Berggaststätten / Alpen • Erlebnisweg • Naturpark Nagelfluhkette • Bogenschießen Disc-Golf • Downhill-Roller • Mountaincarts • Gleitschirmschulen • Tandemflüge • Stuimändleweg • Steinzeitdorf Auf diePiste, Im Winter Im Sommer fertig, 34 Pistenkilometer • 29 Abfahrten (von der leichten Familienabfahrt bis zur anspruchsvollen Weltcup-Strecke) modernste Kabinen- und Sesselbahnen • top Beschneiungsanlagen • Kinderland • Snow-Funpark • Rodelstrecke Loipen • Panorama-Winterwanderwege • zün ige Einkehrhütten • gratis Pendelbus zwischen den Skigebieten www.go-o erschwang.de Infotel. 0 83 21 . 67 03 33 www.hoernerbahn.de Infotel. 0 83 26 . 90 93 BERGE VOLL SPASS BERGBAHNEN OFTERSCHWANG-GUNZESRIED & BOLSTERLANG LOS! © Werbe Blank GEWERBE 106 Ofterschwang
Ski Snowboard Nordic Schneeschuhwandern Einzelcoaching Onlinebucher-Rabatt 5 Tage zum Preis von 4 WE-Kurse inkl. Ausrüstung



Anmeldung im Skischulbüro und Skiverleih in Ofterschwang in der Weltcup-Express-Talstation: Telefon 08321/7882933 und 0171/3080660 www.skischule-ofterschwang.de
Unsere Highlights
Spezialangebot „SchneeSpaßWochen“: 5 Tage Ski leihen und/oder Kurs belegen zum Preis von 4 Tagen.
Online buchen und sparen: Auf alle Online-Buchungen für Skiausrüstung bis 5 Tage vor Verleihtermin, erhalten Sie 3% Rabatt.
Wochenendkurse inkl. Ausrüstung!
Privatcoaching und Familiencoaching

Unser Skiverleih...
...bietet eine große Auswahl perfekt präparierter Sportgeräte, täglich desinfizierte, trockene Schuhe und ein Gratisdepot für gemietete Ausrüstung. ...Ski- & Sportbrillen, Helme & Mützen, Ski-Handschuhe & Ski-Underwear, Protektoren für Kinder sowie Piz Buin-Sonnenschutz.
In unserer Boutique finden Sie...
Hier kommen die Kleinen ganz groß raus!
BOBO‘s
steht für Kreativität, kinderpsychologisch geschultes Personal und jede Menge Spaß. Das Skifahren lernen die Kinder ganz nebenbei.
Sterneklassifizierung der Betriebe
DEUTSCHE HOTELKLASSIFIZIERUNG (DEHOGA)
Die aufgeführten Sterne sind das Ergebnis einer freiwilligen Klassifizierung nach internationalem Standard. Die Klassifizierung erfolgt nach den Richtlinien des Deutschen Hotel und Gaststättenverbandes und entspricht dem Zeitpunkt der Drucklegung.
A Tourist
Superior (S)
Für die Spitzenbetriebe innerhalb der einzelnen Kategorien wurde der Begriff „Superior“ eingeführt.
G-KLASSIFIZIERUNG
(DEHOGA)
Die deutsche Klassifizierung für Gästehäuser, Gasthöfe und Pensionen (von 9 Gästebetten bis maximal 20 Gästezimmern) ist freiwillig und erfolgt nach den Richtlinien des Deutschen Hotel- und Gaststättenverbandes und entspricht dem Zeitpunkt der Drucklegung.
G A
Unterkünfte für einfache Ansprüche
G AA
Unterkünfte für mittlere Ansprüche
G AAA Unterkünfte für gehobene Ansprüche
G AAAA
Unterkünfte für hohe Ansprüche
G AAAAA
Unterkünfte für höchste Ansprüche
DTVKLASSIFIZIERUNG
(Deutscher Tourismusverband)
Die freiwillige Klassifizierung von Ferienwohnungen und Ferienzimmern nach nationalem Standard erfolgt nach den Richtlinien des Deutschen Tourismusverbandes e.V. (DTV) und entspricht dem Zeitpunkt der Drucklegung.
F B / FZ B
Einfache und zweckmäßige Gesamtausstattung mit einfachem Komfort
F BB / FZ BB Zweckmäßige und gute Gesamtausstattung mit mittlerem Komfort
F BBB / FZ BBB
Wohnliche Gesamtausstattung mit gutem Komfort
F BBBB / FZ BBBB Höherwertige Gesamtausstattung mit gehobenem Komfort
F BBBBB / FZ BBBBB Erstklassige Gesamtausstattung mit exklusivem Komfort
Beherbergungsbetriebe ohne Sterne haben an der freiwilligen Klassifizierung nicht teilgenommen. Ein Rückschluss auf ihren Standard ist damit jedoch nicht verbunden. Weitere Informationen unter www.klassifizierung.de
GEWERBE
AA Standard AAA Komfort
AAAA First Class
AAAAA Luxus
107 Ofterschwang
Obermaiselstein HörnerDörfer
Auf Tuchfühlung mit der Natur – in Obermaiselstein ist das ein schmeichelndes Gefühl. Um den Luftkurort erheben sich der „Besler“ und die Silhouette der Hörnerkette und umrahmen schützend die duftenden Wiesen. Deren Kräuterreichtum schmeckt man im handgemachten Bergkäse der Sennalpen
Für eindrucksvolle Urlaubserlebnisse gibt es hier keine Altersbeschränkung: Familien finden spannende und Verliebte finden lauschige Plätzchen. Der Sagenweg führt im Fackelschein zu Drachen, Wilden Fräulein und der Sturmannshöhle Die Pferdekutsche fährt geradewegs in den romantischen Sonnenuntergang.

Mal strahlen die Berge im Pink der Alpenrosen, mal die Gesichter der Gewinner im Spiel!Golf-Park. Und das Ende des Alpsommers krönt einer der größten Viehscheide der Region.
Wird die Welt weiß, amüsieren sich Familien am Idealhanglift und die Ambitionierten fahren mit dem Gratis-Skibus auf die nahen Pisten Grasgehrens. Urlaubszeit in Obermaiselstein ist einfach Huimat uf Zit – eine Heimat auf Zeit.

108








Sturmannshöhle Schneeschuhwandern Premiumwanderweg „Beslerrunde“ Zahlreiche bewirtschaftete Alpen Minigolf Berg-Naturerlebnis Grasgehren 109
HeimatDorf Traditionell
im




































































































































































ORTSPLAN OBERMAISELSTEIN 110
Rie










































































































































































111
Wohlfühl-Hotel Berwanger Hof aaaa C5
Der Berwanger Hof, traumhaft gelegen, mitten im Oberallgäu. Die Kombination von Alt u. Neu, Struktur u. Herzlichkeit, Gefühl fürs Detail u. für die Bedürfnisse derGästezeichnenunserfamiliär geführtes Haus aus.
Gästehaus Christine Hotel garni
Wohlfühl-Hotel Berwanger Hof GmbH Niederdorf 11 87538 Obermaiselstein Tel. 08326 36330 · Fax 363336 info@berwangerhof.de www.berwangerhof.de
mnwIab25
Gästehaus Adelinde B3
Freuen Sie sich auf: - Verwöhnpension - AlpenSpa mit Panoramaschwimmbad, Sauna- u. Wellnessbereich - große Sonnenterrasse, windgeschützt, mit Bergblick - à-la-carte-Restaurant Bis bald im Berwanger Hof!
2 EZ, 35 DZ, 5 App./Suiten HP € 92,- bis 159,- (p. Pers.) je nach Kategorie u. Saison
Pension Alpenrose B3
Claudia Schneider
Am Herrenberg 18 87538 Obermaiselstein Tel. 08326 7089 · Fax 385270 info@gaestehaus-christine.eu www.gaestehaus-christine.eu
cmsvwIab
Gästehaus Bergblick B3
Das Haus liegt am oberen westlichen Dorfrand mit freiem Blick auf die Allgäuer Alpen. Unsere Zimmer sind mit Gesundheitsbetten ausgestattet. Auf Wunsch servieren wir Kuchen u. Kaffee, sowie abends kalte/warme Speisen. Ein Schwimmbad (27 °C) mit Jet-Stream-Anlage und eine Sauna befinden sich im Haus. Ein besonderer Service für unsere Gäste ist unser Schuhheizsystem! Das Rauchen ist nur im Freien gestattet. Ausreichend Parkmöglichkeiten am Haus. Die Schneider´s freuen sich auf Sie!
2 EZ, 6 DZ, 3 MBZ ÜF € 42,- bis
In unseren gemütlichen Ferienwohnungen sowie Zimmern finden Sie Ruhe und Erholung. Zum Frühstück erwartet Sie ein reichhaltiges Buffet.
Franziska Wagner Weidachstr. 1 87538 Obermaiselstein Tel. 08326 7983 · Fax 38310 info@adelinde.de www.adelinde.de
c1hmxIq5
1 EZ, 6 DZ, 4 FeWos, 2-4 Pers. ÜF € 32,- bis 40,- / FeWo € 46,- bis 64,- (2 Pers.) / je weitere Pers. € 10,-
Gästehaus Koch B5
11386
Herrliches Bergpanorama, helle Balkonzimmer, abwechslungsreiches Frühstück, große Sonnenterrasse. ... gemütlich von Natur aus!
Silvia Feldengut Burgschrofenweg 16 87538 Obermaiselstein Tel. 08326 203 info@pensionalpenrose.de www.pensionalpenrose.de
cehmvxIq
2 EZ, 5 DZ, 1 FeWo, 40 qm, 2 Pers. ÜF € 35,- bis 53,- (p. Pers.) FeWo € 64,- bis 74,- (2 Pers.)
Gästehaus Marion Kuhn Appartements & FeWos B3
14470
Genießen Sie Ihren Urlaub in unserem gemütlichen Holzhaus im Allgäuer Stil in ruhiger Aussichtslage. Ihr Tag startet mit einem reichhaltigen Frühstück!
Anneliese & Ludwig Brutscher Am Herrenberg 2 87538 Obermaiselstein Tel. 08326 38299 · Fax 38216 info@bergblick.org www.bergblick.org
hmvwxIq
1 EZ, 3 DZ ÜF € 36,- bis 39,-
Gästehaus Schmid
Gemütl. Familienpension a. ruhigen Ortsrand.ZumTeilneurenov.Zimmer und Gasträume. Reichhaltiges Frühstücksbuffet u. regionale Küche.
20596
Günther Hafner Am Goldbach 35 87538 Obermaiselstein Tel. 08326 208 info@ferienpension-forelle.de www.ferienpension-forelle.de
3 EZ, 12 DZ, 4 MBZ ÜF € 39,- bis 57,HP € 52,- bis 70,-
17633
B3
B3
Herrliche Lage am Ortsrand. Kinderfreundliches Haus mit Spielplatz. Wir bieten ein reichhaltiges Frühstück mit regionalen Produkten.
Anne Koch · Niederdorf 5 87538 Obermaiselstein Tel. 08326 7123 · Fax 366240 info@gaestehaus-kochobermaiselstein.de www.gaestehaus-koch.de
20581 chmvIrq
2 EZ, 8 DZ, 1 MBZ ÜF € 35,- bis 50,-
Gepflegtes, liebevoll eingerichtetes Gästehaus. Appartements und großzügige Ferienwohnungen. Parkplätze am Haus. Skibushaltestelle 4 Min. Marion & Adolf Kuhn Burgschrofenweg 9 87538 Obermaiselstein Tel. 08326 552 · Fax 1392 info@gaestehaus-kuhn.de www.gaestehaus-kuhn.de
q1jlmnwI
4 FeWos, 60-70 qm, 2-3 Pers.
2 App., 30 qm, 1-2 Pers. FeWo, App. € 60,- bis 140,- (2-4 Pers.)
28846
Gemütlich – freundlich – familiär! Frühstücksbuffet, Thermium: Sauna u. Kräuterdampfbad mit Infrarotwärme, (Ski-)Bushaltestelle in der Nähe.

Rosel Schmid Hoistaig 3 87538 Obermaiselstein Tel. 08326 7165 post@gaestehaus-schmid.info www.gaestehaus-schmid.info








20627 cmnwxIbq
4 DZ, 1 EZ ÜF € 40,- bis 60,-
„Ein Ort für besondere Zeiten“. Klarer Komfort. Beste Lage. Echtes Holz. 3 FeWos mit Balkon zum Genießen der Urlaubs-Auszeit. Sauna inkl. Martin Maier
Am Herrenberg 6 87538 Obermaiselstein Tel. 08326 209610
28850 1jmswxIb HOTEL · PENSION/GÄSTEHAUS/FERIENZIMMER · FERIENWOHNUNG
3 FeWos, 52-84 qm, 2-4 Pers. 1. Tag € 135,- bis 205,ab 2. Tag € 85,- bis 135,- (2 Pers.)

Obermaiselstein
28841
10630
B3
58,-
chmnxIq5
Pension Forelle C5
Auszeit Ferienwohnungen 2F BBBBB / 1F BBBB
info@auszeit-ferienwohnungen.de www.auszeit-ferienwohnungen.de 112
Ingo Wolf · Burgschrofenweg 21 87538 Obermaiselstein Tel. 08326 7086 · Fax 8306
info@ferienwohnungen-obermaiselstein.de www.ferienwohnungen-obermaiselstein.de
,Ô1qsIrm
Herrliche, ruhige, sonnige Lage mit Blick auf die Bergwelt. Zimmer mit Du/WC, Balkon, Sat-TV. FeWos mit Balkon/Terrasse, alle mit separatem Schlafzimmer. Frühstück auf Anfrage. Großer Garten, Liegewiese mit Liegestühlen, Kinderspielecke. Aufenthaltsraum m. Kachelofen. Abstellraum für Fahrräder und Ski, Infrarot-Kabine. Kostenloser Abholservice für Bahnreisende. Wir haben unser Haus mit dem „Grander-Wasser-System“ bereichert.
1 DZ, 9 FeWos, 30-60 qm, 2-6 Pers.
ÜF € 29,- bis 45,FeWo € 53,- bis 129,- (2 Pers.) je weitere Pers. € 9,-
Sehr ruhiges Nichtraucherhaus mit herrlichem Bergblick. Für Gäste, die ein hochwertiges Ambiente lieben und Wert auf Gemütlichkeit legen. Ulrich Heidekorn Am Goldbach 31 87538 Obermaiselstein Tel. 08326 384766 od. 3152725 fewo.alpina@bayern-mail.de www.alpina-ferienhaus.de




20639 jimxqbzI
3 FeWos, 43-90 qm, 2-4 Pers. FeWo € 65,- bis 108,- (2 Pers.) je weitere Pers. € 8,- bis € 10,-
Ferienwohnung Stöhr
1F BBBB C4
Moderne „Wohlfühl-Wohnung“ für 2-4 Personen, 2 Schlafzimmer, EG, Südterrasse, Küche, Bus und Loipe 5 Min., Mai – Okt. Hörnerbahnen gratis.
Familie Carola u. Rainer Konietzke Am Goldbach 1 87538 Obermaiselstein Tel. 08326 3841125 o. 0175 4145884 info@fewo-goldbach.de www.fewo-goldbach.de
28859 sjlmIwz5
1 FeWo, 54 qm, 2-4 Pers. FeWo € 64,- bis 94,- (2 Pers.) je weitere Pers. ab 12 J. € 10,-
Alpen-Glühen
Willkommen im
Schmid in Ried am Hirschsprung. Behaglich WohneninkomfortablenFeWos.Ortsmitte 1,5 km, Restaurant ca. 500 m. Skibus-/Bushaltestelle beim Haus.
Schmid · Wiedemann Ried 3 · 87538 Obermaiselstein Tel. 08326 7950 o. 381555 info@obermaiselstein-ferienwohnung.de www.obermaiselstein-ferienwohnung.de
1hijklqm
7 FeWos, 35-85 qm, 2-6 Pers. FeWo € 46,- bis 68,- (2 Pers.) je weitere Pers. € 7,-
17778
Zwei gemütliche 3-Raum-Ferienwohnungen zum sich erholen und wohlfühlen. Große S/W-Balkone mit herrlichem Blick in die Berge.
Michael Stetter Weidachstr. 8 87538 Obermaiselstein Tel. 08326 7095 · Fax 384543 mail@petra-stetter.de www.petra-stetter.de
20651 ijlIswxq
2 FeWos, 65-92 qm, 2-5 Pers. FeWo 1 € 65,- bis 89,FeWo 2 € 89,- bis 120,-
Ferienhüttle Romantik pur
Herzlichwillkommeninunserem Ferienhüttle „Romantik pur!“ Sie finden uns in ruhiger, sonniger Hanglage, nur wenige Gehminuten vom Ortszentrum entfernt. Das Hüttle ist gemütlich und komfortabel ausgestattet und bietet Ihnen alles, was Sie von einem schönen Urlaub erwarten, u. a. zwei getrennte Schlafzimmer, Sat-TV, W-LAN, TerrasseundBalkon,Liegewiese, Sonnenschirm und bequeme Gartenmöbel. Carport auf Wunsch gegen Aufpreis. Für mehr Details besuchen Sie uns auf unserer Homepage oder unter www.hoernerdoerfer.de.
Gemütliche Ferienwohnung, Am Goldbach 8c, Obermaiselstein, mit 2 Schlafmöglichkeiten.Ruhigundzentral gelegen. Wäscheausstattung inklusive. Achim und Birgit Stöhr Schillerstr. 12 · 34260 Kaufungen Tel. 0151 58533478 fw.stoehr-obermaiselstein@web.de www.stoehr-ferienwohnungobermaiselstein.de
28863 hilmwxIr
1 FeWo, 56 qm, 2 Pers. FeWo € 65,- bis 95,- (2 Pers.)
Gemütliche FeWos mit Balkon und herrlichem Bergblick, in ruhiger, sonniger Lage. Bushaltestelle, Loipe und hauseigener Skilift in nächster Nähe.
1 FeHaus, 55 qm, 1-4 Pers. FeHaus € 67,- bis 112,-




Rosmarie Berwanger Niederdorf 1 · 87538 Obermaiselstein Tel. 08326 366808 info@alpen-gluehen.de www.alpen-gluehen.de

28848 1ijlIxrq
3 FeWos, 43-80 qm, 1 App., 32 qm FeWos € 45,- bis 130,- (2-7 Pers.) App. € 38,- bis 48,- (2-3 Pers.)
Ihre Ferien liegen uns am Herzen! Sie finden uns in ruhigerOrtsrandlageu.trotzdem zentrumsnah. Wir laden ein, in drei geschmackvoll, gemütlich ausgestattete FeWos im Landhausstil, für 2-4 Personen, mit herrlichem, unverbautem Blick auf die Allgäuer Bergwelt, Balkon oder Terrasse zur Südseite, Liegewiese.
DieWohnungenbestehenauseinem separaten Schlafzimmer, Wohnzimmer, komplett eingerichteter Küche, Du/WC. Parkplätze am Haus. Ermäßigung in der Vor- u. Nachsaison.
3 FeWos, 42-51 qm, 2-4 Pers. FeWo € 45,- bis 55,- (2 Pers.) je weitere Pers. € 10,-
Obermaiselstein
Gästehaus Caser 1F BBBB / 7F BBB / 1F n.k. B3
Haus Alpina
2F BBBB / 1F BBB C4
Ferienwohnung Maringga 1F BBBB C4
Landhaus
Landhaus Schmid 1F BBBB / 6F BBB D4
Haus Stetter
1F
BBBB / 1F BBB B3
Ferienwohnungen B5 Ijlnswxrq
20614
B3
u. Hans-Joachim Kümmerle Burgschrofenweg 5 87538 Obermaiselstein Tel./Fax 08326 35247 hauskuemmerle@t-online.de www.hauskümmerle.de ilmwxIrq
Susanne
11321
Haus Rubihornblick B4
Helmut Eller
Bichelweg 1 · 87538 Obermaiselstein
113 FERIENWOHNUNG
Tel. 08326 7472 Mobil 0151 56818463 rubihornblick@web.de www.haus-rubihornblick.de
Obermaiselstein
Ferienwohnung
Barbara C4
Ferienwohnung Beccara B3
Die FeWo verfügt über 3 Schlafzimmer, 1 Bad/WC, 1 Du/WC, 1 kompl. einger. Küche, Wohnzimmer mit Essecke. Kinderbett + Hochstuhl vorhanden.
Kerstin Knabenbauer
Am Goldbach 6 87538 Obermaiselstein Tel. 0173 3594144







info@barbara-obermaiselstein.de www.barbara-obermaiselstein.de
jlmIzabq
1 FeWo, 130 qm, 2-6 Pers. FeWo € 800,-/Woche (4 Pers.) je weitere Pers. € 10,-/Nacht
Ferienwohnungen
Dornach B3
28851
Sehr ruhig gelegene, komfortable 2-Raum-FeWo im EG, Südterrasse, Wohnraum m. Schlafcouch, Küche m. Essplatz, Bad/WC, Schlafraum, Radio/ Sat-TV, W-LAN.
Geräumige, komfortable Wohnungen für 2-4 Pers., mit Sat-TV, Radio, Kaffeemaschine, komplette Wäsche, WLAN inkl. ruhige, sonnige Lage, Bergblick.
Ferienwohnung
FeWozumWohlfühleninruhigerOrtsrandlage über gesamte obere Etage mit West- und Ostbalkon. 2 Schlafzi., Spülmaschine, 1 Min. zum Ski-/ÖPNVBus bzw. Loipe.
Gepfl., ruh. geleg. FeWos, sep. Küche m. Spülmasch. u. Backofen. Sep. Schlafzi., Bad/WC, sep. WC. LCD-TV, Stereoanl., Safe, Balkon, Carport.
Manfred Dornach Burgschrofenweg 20 87538 Obermaiselstein Tel. 08326 1402
info@ferienwohnungen-dornach.de www.ferienwohnungen-dornach.de
20640 nswxIz5
3 FeWos, 30-70 qm, 1-4 Pers. FeWo € 45,- bis 70,- (2 Pers.) je weitere Pers. € 10,-
Gabriele Beccara
Am Herrenberg 8 87538 Obermaiselstein Tel. 08326 1426
Gabriele.Beccara@web.de
20594 ilmwxr5I
FeWo, ab 50 qm, 2-4 Pers. FeWo € 58,- bis 62,- (2 Pers.) je weitere Pers. € 10,-
Haus Gamseck –Familie Jordan
Centa Buhl Oberdorf 15 · 87538 Obermaiselstein Tel. 08326 7994 · Fax 35304 info@landhaus-buhl.de www.landhaus-buhl.de
ijklmsz
5 FeWos, 42-74 qm, 2-4 Pers. FeWo € 42,- bis 55,- (2 Pers.) je weitere Pers. € 12,-
20598
dennoch
20602 nsIrbqx
Ruhige Ortsrandlage. Komfortabel u. ländlich einger. FeWo. Sep. Wohn- u. Schlafzimmer. Küche, Südbalkon, Du/ WC, Radio u. Sat-TV. W-LAN.
Marietta Geg Am Goldbach 22 87538 Obermaiselstein Tel. 08326 38038 · Fax 38037 info@gegs-ferienwohnungen.de www.gegs-ferienwohnungen.de
20641 ilmqIx
3 FeWos, 35-50 qm, 2-4 Pers. FeWo € 75,- bis 85,- (2 Pers.) je weitere Pers. € 10,-
Stefan Buhmann · Am Goldbach 15 87538 Obermaiselstein Tel. 08324 9539153 stefan.buhmann@t-online.de www.ferienwohnung-buhmann.de
20599 1ijmnswI
1 FeWo, 65 qm, 2-4 Pers. FeWo € 84,- bis 113,- (2-4 Pers.) / je w. P. € 7,50 / bis 6 J. frei / bis 8 J. € 4,-
Ferienhaus Geg B4 Ferienwohnungen Gerling

Gemütliche 3-Raum-Komfort-FeWos mitWLAN,TV,S/W-Balkon,Schwimmbad + Sauna laden Sie ein. Genießen Sie einen unverbauten Bergblick!
28853 ilmwaIbq
3 FeWos, je 50 qm, teilw. bis 5 Pers. FeWo € 60,- bis 70,- (2 Pers.) je weitere Pers. € 5,-
Die einzig begehbare Spalthöhle des Allgäus ist eine mystische Gefühlswelt für Groß und Klein, bei konstanten 8 Grad Celsius. Informationen zu Öffnungszeiten und Buchung der Führungen unter www.sturmannshoehle.de Sturmannshöhle
D4 114 FERIENWOHNUNG Freier Eintritt mit Hörnerdörfer Card
 Landhaus Buhl B5
Landhaus Buhl B5
Buhmann B4
Tilly Gerling Am Goldbach 4 87538 Obermaiselstein Tel. 0173 4199045 · Fax 0211 593560 tilly.gerling@congresse.de www.ferienwohnung-gerling.de C4
Sturmannshöhle Obermaiselstein
2 FeWos, 40-50 qm, 1-4 Pers. FeWo € 40,- bis 50,- (2 Pers.) je weitere Pers. € 10,-
Bus
in der Nähe.
Sehr ruhig gelegen,
zentral zum Ort. Herrliches Panorama, Liegewiese mit Liegestühlen, Terrasse,
direkt
Hans-Christian & Sylvia Jordan
Ried 12 · 87538 Obermaiselstein Tel. 08326 209007 anfrage@haus-gamseck.de www.haus-gamseck.de
Ferienwohnungen Hartmann B3
Ferienwohnungen mit Balkon und mit herrlichem Ausblick auf die Berge. Sauna, Liegewiese, Grill- und Spielplatz.
Tanja Reisacher Burgschrofenweg 17 87538 Obermaiselstein Tel. 08326 2419903 info@fewohartmann.de www.fewohartmann.de
1moIrbjq
3 FeWos, 50-72 qm, 2-6 Pers. FeWo € 62,- bis 70,- (2 Pers.) je weitere Pers. € 10,- / Kind € 5,-
12809
Gemütliches Haus in sonniger und ruhiger Lage mit herrlichem Bergblick. 4 gepflegte Ferienwohnungen mit Balkon oder Südterrasse.
Emil Haselberger
Freundl. Betreuung, attr. Lage, Balkon oder Terrasse, Parken am Haus, Bettwäsche/Handtücher inkl., Spülmasch., allergikerfr. Böden, kostenl. W-LAN. Irmgard Rain
Ruhige Lage mit Bergblick. Gemütl., gepflegte FeWo, Liegewiese m. Grillmögl., Bergwanderungen und Radtouren ab Haus möglich. Nur kleine Hunde auf Anfrage.
Neu renovierte FeWos in Ortsrandlage, alle mit Balkon/Terrasse. Loipe am Haus, ca. 5 Gehminuten zur Ortsmitte. Wir freuen uns auf SIE!
Alexander Steiner
Aumühle 3 · 87538 Obermaiselstein Tel. 08326 3868140 · Fax 38139 steiner.ax@web.de www.urlaub-im-allgaeu.org
jwilmnxI
5 FeWos, 32-80 qm, 1-6 Pers. FeWo € 49,- bis 110,- (2 Pers.) je w. Pers. € 10,- bis 15,- / zzgl. ER
23912
20604 1hjiklmq
Am Goldbach 10 87538 Obermaiselstein Tel. 08326 7483 · Fax 366443 haus.haselberger@web.de www.haus-haselberger.de
4 FeWos, 30-70 qm, 2-5 Pers. FeWo € 45,- bis 65,- (2 Pers.)
Die kleine Pension B/C4
Am Goldbach 16 87538 Obermaiselstein Tel. 09163 996930 Fax 996939 Landhaus-Irmgard@web.de www.landhaus-irmgard.de

hjlIswxr
3 FeWos, 62 qm, 2-5 Pers. FeWo 3 R. € 64,- bis 100,- (2-5 Pers.) Kinder bis 1 J. frei, bis 5 J. ermäßigt
Urlaubshof Kling D4
20608
Georg u. Gabi Jordan
Ried 12 1/2 · 87538 Obermaiselstein Tel. 08326 7962 · Fax 0384567 gaestehaus-jordan@web.de www.gaestehaus-jordan.de
1ijlmsx5
2 FeWos, 60-65 qm, 1-5 Pers. FeWo € 55,- bis 70,- (1-2 Pers.) je weitere Pers. € 8,- / exkl. ER
20579
Stilvolle FeWos mit herrlichem Bergblick, familiäre ruhige Atmosphäre, allergikerfreundlich, Brötchenservice, Schlittenverleih, Spülm./Mikrowelle.
Michaela Pinn
Am Goldbach 14 87538 Obermaiselstein Tel. 08326 596 · Fax 384892 info@diekleinepension.de www.diekleinepension.de







1jlmswxI
2 FeWo, 55-65 qm, 2-4 Pers. FeWo € 70,- bis 75,- (2 Pers.) jede weitere Pers. € 8,-
Premiumweg Beslerrunde
20624
Abseits vom Straßenverkehr ist unser Bergbauernhof ein idealer Ausgangspunkt für zahlreiche Wanderungen u. Spaziergänge. Alle Wohnungen sind m. Südbalkon u. WLAN ausgestattet. Armin Kling Ried 10 · 87538 Obermaiselstein Tel. 08326 3857026 urlaubshof-kling@web.de www.urlaubshof-kling.de
1kmsx@rq
3 FeWos, 25-54 qm, 2-4 Pers. FeWo € 35,- bis 75,- (2-4 Pers.)
20646
Familiäres Landhaus in traumhafter Alleinlage, 700 m zum Ort. Gepflegte, großzügige, sehr gut ausgestattete FeWos für 2-6 Pers. Christine Bietsch Haubenegg 2 87538 Obermaiselstein Tel. 08326 9497 od. 0160 96747992 landhauskoebie@freenet.de www.landhauskoebie.de

20647 1hijlmrI
3 FeWos, 55-80 qm, 2-6 Pers. FeWo € 55,- bis 115,- (2 Pers.), jede weitere Pers. € 15,-
Der etwas andere Berg im Naturpark Nagelfluhkette. Von Schratten und Karren und Gemsen, all dies hat die Wanderung auf den Besler über das imposante Kalkplateau zu bieten. Anspruchsvolle Pflanzen, wie der Blaue Eisenhut, Europas giftigste Pflanze bis hin zum gelben Großblütigen Gemswurz, der von seinen Namensvettern tatsächlich gerne gefressen wird. Auch die pelzigen und äußerst bergaffinen Tiere selbst können entdeckt werden. Beslerrunde
Obermaiselstein
Haus Haselberger C4
Landhaus Irmgard B4
L6
Haus Jordan
Landhaus Kennerknecht A4
Landhaus Köberle-Bietsch D3
115 FERIENWOHNUNG
Ferienwohnung
Xaver Maier B4
Gepflegte Komfort-Ferienwohnungen für 2-3 Pers. in ruhiger Lage. Geräumige Wohnräume mit Küche, sep. Schlafzimmer, Du/WC, TV u. Balkon.
Xaver Maier
Am Goldbach 23 87538 Obermaiselstein Tel. 08326 7996 kontakt-maier@t-online.de www.fewo-obermaiselstein.de
ikmwxIq
2 FeWos, 42-45 qm, 2-3 Pers. FeWo € 57,- bis 67,- (2 Pers.) je weitere Pers. € 13,-
Sonnenstrahl B3
20617
Behagliche, moderne FeWos mit grandioser Aussicht auf die umliegenden Berge. Wanderwege, Loipe, Restaurants in unmittelbarer Nähe.
Anton Cop Oberdorf 22 87538 Obermaiselstein Tel. 08326 385440 jutta.toni@t-online.de www.landhaus-milena.de
1ilmwxIq
3 FeWos, 50-60 qm, 1-3 Pers. FeWo € 50,- bis 75,- (2 Pers.) je weitere Pers. € 10,- bis 20,-
20653
Herzlich willkommen in unseren liebevoll einger. FeWos. Genießen Sie auf unserem S-Balkon die Aussicht. Bushaltestelle, Loipe in nächster Nähe.
Thomas Natterer · Aumühle 4a Anfr. an Burgschrofenweg 15 87538 Obermaiselstein Tel. 08326 1326 · Fax 3867825 monikanatterer@gmx.de
hilmIxq
2 FeWos, 27-50 qm, 1-4 Pers. FeWo € 36,- bis 52,- (2 Pers.) je weitere Pers. € 10,- / bis 15 J. € 8,-
Landhaus Ücker

Obermaiselstein
Idyllisch am Hang gelegen, bietet unsere frisch renovierte, liebevoll eingerichtete und ruhig gelegene Ferienwohnung alles, was das Herz begehrt, inkl. 2 Sonnenbalkone mit Bergblick. Annegret Sperl · Am Herrenberg 1 87538 Obermaiselstein Tel. 07303 952574 ferienwohnung-sonnenstrahl@web.de www.ferienwohnung-sonnenstrahl.de

30163 milwxIqh
1 FeWo, 63 qm, 1-4 Pers. FeWo € 71,- bis 102,- (2 Pers.) je w. Pers. € 15,- / Kinder ab € 7,50
Lenzenberghütte
1F BBBB / 1F BBB / 37F n.k. B3
Neu renovierte Selbstversorgerhütte in traumhaft, sonniger Alleinlage mit einfacher Ausstattung, gr. Terrasse & grandiosem Blick in die Berge.

Wir haben die passende FeWo! Haus Obermaiselstein und Haus Alpenland mit Hallenbad. Haus Sonnenhof. Sommer wie Winter, Erholung garantiert!


Tanja Schneider · Hoistaig 5-9 87538 Obermaiselstein Tel. 08326 38346 · Fax 38347 info@ferienwohnungen-steinweg.de www.ferienwohnungen-steinweg.de
6 x 1 Zi. Apartments, 30 - 35 qm 23 x 2 Zi. Apartments, 35 - 70 qm 7 x 3 Zi. Apartments, 56 - 90 qm 1 x 5 Zi. Apartment, 103 qm FeWo € 50,- bis 90,-/Tag
Berghof Schwarzenberg Alpenwildpark D2
11377
Herrl. sonnige Alleinlage, Panoramasonnenterrasse, Schmankerl i. Berghofstüble, Führungen mit Fütterung i. Alpenwildpark, Festlichkeiten j. Art.
Klaus Lohmüller
B5
20622
Renoviertes Haus, sonnig und ruhig. 2 neue Komfort-FeWos, sep. Schlafzi., Balkon und traumhafter Bergblick. Loipen und Bushaltestelle nahe Haus.
Stephan Pechlaner
20623 ijlmwIq
2 FeWos, 48-81 qm, 2-5 Pers. FeWo € 68,- bis 120,-
Haus Walk A3
Inruhiger,sonnigerLagemitherrlicher Bergsicht bieten wir Ihnen geräumige undvoll ausgestattete 1- bis 3-RaumFeWos mit Balkon und Sat-TV.
Unsere gepflegte Ferienwohnung bietet Raum für 1-3 Personen. Die Wohnung liegt im 1. Stock, ist 35 qm groß und hat einen großen Balkon.
20635 1jlmnswq
Andrea & Walter Ücker Oberdorf 18 87538 Obermaiselstein Tel. 08326 7711 www.landhaus-ücker.de



1 App., 3 FeWos, 22-80 qm, 1-6 Pers. App. € 31,- bis 41,- (1-2 P.) / FeWo € 56,- bis 82,- (2 P.) / je w. P. € 12,-
Elmar Walk Eschenweg 15 87538 Obermaiselstein Tel. 08326 209272 · Fax 209273 hauswalk@elmar-walk.de www.elmar-walk.de
20590 hilmwxIq
1 FeWo, 35 qm, 1-3 Pers. FeWo € 38,- bis 48,- (1-3 Pers.) unter 4 Nächten Preis auf Anfrage
Stephan Sachs
87538 Obermaiselstein
Tel. 07392 913060 · Fax 913062 info@lenzenberghuette-sachs.de www.lenzenberghuette-sachs.de
hlmnv
28927
Königsweg 4 87538 Obermaiselstein Tel. 08326 8163 · Fax 384726 info@alpenwildpark.de www.alpenwildpark.de 116


1 DZ, 2 FeWos, 42-60 qm, 2-10 Pers. ÜF € 33,- bis 39,-/Erw., FeWo € 46,- bis 52,- (2 P.) / HP + VP mögl.
 Landhaus Milena B5
Haus Natterer A4
Landhaus Milena B5
Haus Natterer A4
Am Goldbach 11 87538 Obermaiselstein Tel. 08326 527 info@gaestehaus-pechlaner.de www.gaestehaus-pechlaner.de Gästehaus Pechlaner C4
Ferienwohnungen Steinweg
5 MBZ, 10-30 Pers. Preise auf Anfrage
28709 cilmIrgq FERIENWOHNUNG · HÜTTEN
Wir lieben Mode. Wir leben Regionalität, Nachhaltigkeit und Tradition. Gewusst wo´s herkommt, gewusst wo & wie produziert wird und wer die Köpfe unserer Labels sind. Unser einzigartiger Mix aus Mode, Tracht und Sport. Echt, anders und ganz viel bader.





































































AM SCHEID 12 · 87538 OBERMAISELSTEIN · TEL. 0 83 26-16 16 · 24/7 ONLINE-SHOP: WWW. BADER-OBERMAISELSTEIN.DE EINZIGARTIG.
BADER | OUTLET | LADEN | ONLINESHOP
MODE & TRACHT
gricht! 117
Oardele
Bolsterlang HörnerDörfer

Postkartenidylle – in Bolsterlang ist das keine Übertreibung. Klein, familiär, weit weg vom Trubel der Welt. Bolsterlang entspannt wirksam und anhaltend. Entweder bei Aktivitäten im Freien, wie Wandern, Radfahren, Golf in Groß und Mini und dem Bogenschießen auf Übungsplatz, Tal- und Bergparcours.
Aber auch gemütlich bei einer Hütteneinkehr oder einem Bierbraukurs. Ein Besuch auf dem Hausgipfel, dem Bolsterlanger Horn, empfiehlt sich für den Kunst- und Besinnungsweg und den Panorama-Höhenwanderweg, der auch für Winterspaziergänge bestens präpariert ist. Die Höhenmeter bis zu den Startpunkten darf man einfach der Hörnerbahn überlassen. Die Auffahrt in den sonnengelben Gondeln bietet einen großartigen Blick auf die Silhouetten der Allgäuer und Oberstdorfer Alpen und ist im Winter eine von 6 Liftanlagen für 17 Pistenkilometer. Auf Schneeaktive warten zudem reichlich Möglichkeiten für Langlauf und Winterwanderungen, die durch Verbindungen zu anderen Hörnerdörfern schier endlos ausgedehnt werden können.

118
im BergDorf Zielsicher
Hinauf auf den Gipfel mit der Hörnerbahn


Winterwandern Tradition hautnah erleben






119
Langlauf Bogenschießen für Anfänger & Fortgeschrittene Familienskigebiet
































































































































RangiswangerHorn Wannenkopf Weiherkopf Horn Bolsterlanger Hö r ne r p ano ram aweg InteraktiverKunstundBesinnungsweg SonderdorferKreuz Berg-Erlebnis-Weg 3D-Bogenparcours Sennaple Ornach s’Mibbadin Zunkleiten-Alpe HörnerbahnBergstation Hörnis Nest AlpeHinteregg HörnerbahnMittelstation BuchloerHütte SigiswangerHorn-Alpe Hörner-Haus Ober-Älple UntereKierwanger-Alpe ObereKierwanger-Alpe Rangiswanger-Alpe Steinhöbel-Alpe Bolgenach Bolgenach Mühlbach Seichebach Rittingerbach Stuibenbach Wiesbach Sulzbach Burgstallbach Weiherkopflift Hörnerbahn2 Stuibeneckbahn Hörnerbahn 1 1712 1586 1665 1616 (1385) (1290) (1145) (1450) (1170) (1387) (1151) (1399) (1516) (1312) 1086 1246 1174 1560 Alpentobel B o l g e n t a l K B 16 25 1 2 3 ABC D AB CD 4 5 6 N W S O K a p e l e n w e g Dorfstraße S t iu b e ns tra ße Dorfstraß e Weiherkopfweg Bo lgenstra ße Kapellenweg G ol d b a c h w e g Hörnerstraße Am Bächle Flurstraße Goldbachweg Goldbachweg Hochwiesweg Rathausweg Z um H as e n a ck e r Gbdlo a ch w eg G ol d b achwe g Fußweg Hörnerbahn Kurpark Bogenübungsplatz Musikpavillon Festsaal Kitzebichl 1 2 3 Bolsterlang 1 1 1 1 1 1 1 1 1 1a 1b 2 2 2 2 2 2 2 2 2 2 2a 2b 3 3 3 3 3 3 3 3 3 3 4 4 4 4 4 4 4 4 4 4a 5 5 5 5 5 5 5 5 5 6 6 6 6 6 6 6 6 6 7 7 7 7 7 7 7 8 8 8 8 8 8 8 9 9 9 9 9 10 10 10 10 10 10 11 11 11 11 11 11a 12 12 12 12 12 13 13 13 14 14 14 14 14 15 15 16 16 16 16 16 16 17 17 17 18 18 19 19 19 20 20 21 21 21 22 22 23 23 23a 24 27 28 29 30 32 33 34 36 37 38 46 48 50 18 35 44 40 31 O r t sst r aß e Angerweg Be r gweg Ortsstraße Bergweg Ortsstraße Bergweg Wiesenweg Am Sti e g Bauhof 904 Kierwang 2 2 3 4 4 4 4 5 5 6 6 6 7 8 9 9 10 10 11 12 12 13 14 14 15 16 16 17 17 18 18 18a 19 19 19 20 20 20a 21 21 22 23 23a 23b 24 25 26 27 28 30 32 25b Gästeamt Golf Telefonzelle Skischule Parkplatz Gaststätte ganzjährig Alpen/Gaststätten zeitweise Kapelle Aussichtspunkt 050025 Minigolf Hunde-WC Bogenschießen 0 Kartengrundlage outdooractive Kartografie: Geoinformationen © Outdooractive Geoinformationen © Bayerische Vermessungsverwaltung (www.geodaten.bayern.de) Hauskoordinaten; Wiedergabe mit Genehmigung des Landesamt für Vermessung und Geoinformation Bayern, Nr. O 1419 VM A-1945/09. Einbahnstraße Wanderweg Loipen Für Kfz gesperrt Spielplatz Einkaufen Briefkasten Wertstoffinsel Geldautomat urs nge hn ) ORTSPLAN BOLSTERLANG 120






























































































































HörnisRastplatz urs Bogenübungsplatz GolfplatzOberallgäu 3D-Bogenparcours St. Sebastian, Rochus und Sylvester Kurpark Talhütte FestsaalKitzebichl Seehaus Golfrestaurant Waldhäusle nger-Alpe Rohrabach Krebsbach Stuibenbach Speicherteich kein Badesee WeilerAch WeilerAch OA5 OA5 OA9 Dorflift2 Hörnis Lift Hörni Tellerlift Dorflift 1 4 7 (893) (849) 886 803 870 876 912 846 858 821 904 858 Aumühle Gundelsberg Riedle Bauhof Hageberg Hirtenstein Obermühlegg Dietrichs Oberdorf Sonderdorf Kierwang Untermühlegg Obermaiselstein Bolsterlang nach Ofterschwang nach Fischen nach Fischen nach Balderschwang 1 2 3 4 5 5 6 7 7 8 9 12 13 14 1 1a 2 3 4 5 1 2 3 5 6 7 8 9 10 11 12 13 1514 1 2 3 1 8 8 10 11 13 14 15 16 29 31 1 2 3 4 5 6 7 7a 1 2 3 4 5 9 28 1 2 3 3a 4 5 6 7 8 9 10 10 11 12 13 14 14a 16 18 19 21 22 23 24 EFGH EFG H 1 2 3 4 5 6 5 6 Dorflift Hörnis Lift Basislager Dorflift 2 Hörnli Tellerlift Sonderdorf 1 2 3 4 5 6 7 8 10 11 12 13 14 15 16 17 18 19 20 21 22 23 24 25 26 27 30 31 32 33 34 35 36 37 38 39 40 41 42 121
Bolsterlang
Vintage-Hotel Charivari mit Restaurant Wintergarten
Dorfstraße 15 · 87538 Bolsterlang · Tel. 08326 366157 Charivari Ferienwohnungen · Berger Steige 1 · 87538 Fischen Tel. 08326 36000 · info@charivari-ferienwohnungen.de www.charivari-ferienwohnungen.de
Im Sommer Hörnerbahnen kostenlos nutzen!
Im Ortskern, nahe an vielen touristischen Einrichtungen, finden Sie unser kleines Hotel, das liebevoll im Vintage-Stil eingerichtet ist. Die Zimmer sind ganz unterschiedlich im Retro-Look ausgestattet. Auch Familien mit Kindern sind bei uns gut aufgehoben, denn in 3 Zimmern gibt es eine Schlafgalerie für Kinder des Weiteren 1 Suite. Alle haben moderne Bäder und fast alle einen Balkon mit Aussicht. Morgens verwöhnen wir Sie mit einem reichhalt. Frühstücksbuffet. In unserem Restaurant Wintergarten, mit neuer, vergrößerter Sonnenterrasse bieten wir Ihnen Allgäuer Schmankerl, Klassiker aus der deutschen Küche, italienische Gerichte, sowie leckere Pizza aus dem Steinbackofen an.
Pension Gästehaus Schönblick

Timo Zebisch
Flurstraße 1 + 12 87538 Bolsterlang Tel. 08326 38003 · Fax 384180
info@ferienhotel-silberdistel.de www.ferienhotel-silberdistel.de
Beliebtes, familienfreundliches Ferienhotel. 2 Häuser in ruhiger und dennoch zentraler Lage mit Hotelzimmern verschiedener Kategorien, Appartements mit optionalem Hotelservice sowie Ferienwohnungen. Starten Sie in den Tag mit unserem Allgäuer Frühstücksbuffet. Entspannung finden Sie in unserem Saunabereich mit gemütlichem Ruheraum oder unserem großen Garten mit Spielund Liegewiese. Gratis Internet über W-LAN. Ganzjährig interessante Angebote.
2 EZ, 6 DZ, 4 MBZ ,10 App. FeWos, 30-60 qm, 1-5 Pers. ÜF € 40,- bis 80,- (pro Pers.) App./FeWo € 45,- bis 150,(pro Nacht)
Gästehaus
Hornblick
Friedrich Ebert
Dietrichs 1 · 87538 Bolsterlang
Tel. 08326 385420 oder 7521 Fax 385421 cafeschoenblick@aol.com www.landgasthof-schoenblick.de
c1novwIrq
Die Lage unseres Hauses ist ein echter Glücksfall! Sie finden bei uns einen sonnigen, ruhigen Logenplatz inmitten der Natur mit der gesamten Oberallgäuer Bergkulisse vor Augen. Herrliche Wanderwege beginnen direkt am Haus und im Winter starten Sie direkt vor der Haustüre auf die Loipe. Zwei Sonnenterrassen, Liegewiese und ein Spielplatz gehören auch zum Haus. Unser Restaurant bietet für unsere Hausgäste gutbürgerliche Küche.
Wir freuen uns auf Sie!
1 EZ, 7 DZ
5 FeWos, 45-60 qm, 2-4 Pers. ÜF € 28,- bis 33,50 FeWo € 52,- bis 75,(2-4 Pers.)
Liebevoll renoviertes Haus – jedes Zimmer eine Überraschung! Familiäre Atmosphäre, hochwertiges, reichhaltiges Frühstücksbuffet & herrliche Naturlage.
Manuela & Alfons Schaidnagl
Ortsstraße 5 · 87538 Bolsterlang
21686 chmvxIq7 E2
2 EZ, 4 DZ, 1 MBZ
2 FeWos, 35-42 qm, 2-4 Pers.
ÜF € 35,- bis 95,- / FeWo € 58,- bis 68,-
Top Lage, DZ und EZ mit Du/WC, Balkon, Frühstücksbuffet. FeWo, 2 Schlafzimmer, Wohnküche und Wohnzimmer, Balkon, Frühstück auf Wunsch, W-LAN.
21743 ce1jmxIq Gästehaus Panorama
ÜF € 37,- bis 51,- pro Pers. / FeWo € 82,- bis 110,- (2 Pers.) / inkl. KT
Manfred Engelbart
Bolgenstraße 9 und 16 87538 Bolsterlang
Tel. 08326 7677 · Fax 1377
E4 himwxIrb
122 HOTEL · HOTEL GARNI · PENSION/GÄSTEHAUS/FERIENZIMMER · FEWOS







Gönnen Sie sich Ihre Erholung! Verbringen Sie die schönsten Wochen des Jahres in unseren modernenFeWosmithochwertiger Ausstattung im alpenländischen Stil. Genießen Sie von Ihrer Terrasse oder Ihrem Balkon den herrlichen freien Blick auf das traumhafte Bergpanorama der Allgäuer Alpen. Wander- und Skigebiete direkt vor unserer Haustür. Neue Grillanlage. Gerne sind wir Ihre Gastgeber und wünschen uns, dass Sie sich wohlfühlen. Wir freuen uns auf Ihren Besuch. Unser Bestreben ist Ihre vollkommene Zufriedenheit!
FeWo € 57,- bis 124,- (2 Pers.) je weitere Pers. € 15,Kinder 4-6 Jahren € 9,Kinder 7-12 Jahren € 12,-

chmwxI r4q79 12 Komfortzimmer, ÜF p. P., 18 - 40 qm 1 EZ € 40,- bis 70,5 DZ € 40,- bis 60,5 MBZ € 50,- bis 70,1 Suite € 60,- bis 80, 28675 F4 c1Isxbq
Ferienhotel Silberdistel F4
21751
G1
Tel. 08326 464 · Fax 381752 hornblick@t-online.de www.hornblick.de
2 EZ, 2 DZ · 2 FeWos, 68-80 qm, 2-4 Pers.
Exquisit 1F BBBBB / 6F BBBB / 6F BBB E5
Christine u. Lorenz Weber Hochwiesweg 3 · 87538 Bolsterlang Tel. 08326 645 · Fax 385844 info@gh-panorama-weber.de www.gh-panorama-weber.de
21662 Landhaus
13 FeWos, 40-100 qm, 2-4 Pers.
info@landhaus-exquisit.de www.landhaus-exquisit.de
Gemütl. FeWos, stilvoll u. freundlich eingerichtet. 5 Gehmin. vom Skilift. Vollbiologisches, neues Holzhaus mit Bergblick. Ruhige Lage. Parkplätze. Fitnessraum.IdealfürFamilien.W-LAN.

Erika Seider · Flurstraße 18 87538 Bolsterlang Tel. 08326 36410· Fax 08326 8176 landhaus.alpenflora@gmail.com www.landhaus-alpenflora-bolsterlang.de
jlmwI3q
3 FeWos, 39-130 qm, 1-6 Pers. FeWo € 65,- bis 240,- (2 Pers.) Unter 7 ÜN pro Pers. einmalig + € 20,-
Dreimädelhaus
2F
5 liebevoll eingerichtete, komfortable FeWos am Ortsrand – eigene Zufahrt. Große, gepflegte Gartenanlage. Freie Fahrt m. Allgäuer Hörnerbahnen.
Siegfried Feldengut
Am Bächle 3 · 87538 Bolsterlang Tel. 0151 12757360 · Fax 38217 info@feldengut-dreimaedelhaus.de www.feldengut-dreimaedelhaus.de
1imnwxIq
5 FeWos, 30-50 qm, 1-2 Pers. FeWo € 55,- bis 85,zzgl. Kurtaxe
21670
29069
Alleinstehendes Haus mit FeWos für 2-4 Pers. Brötchenservice, Ideal für Familien, Wanderer, Radfahrer. Wintersport und Erholung.



Markus Mühlegg Untermühlegg 14 · 87538 Bolsterlang Tel. 08326 366934 · Fax 383927 bachtelmuehle@t-online.de www.bachtelmuehle.de
1xijmIbq
9 FeWos, 33-82 qm, 2-4 Pers. FeWo € 54,- bis 95,- (2 Pers.) je weitere Pers. € 7,- bis 12,-

Landhaus Exclusiv


21663
Ankommen-Wohlfühlen-Entspannen in ruhigen, gemütlichen und komfortablen FeWos am Ortsrand. Jede FeWo mit Bergblick & Südbalkon. Marie-Luise Kaserer Goldbachweg 34 87538 Bolsterlang Tel. 08326 7077 info@haus-alpensonne.com www.haus-alpensonne.com
1ilmwxIq
3 FeWos (2-Raum), 35-50 qm FeWo € 55,- bis 80,- (max. 2 Pers.)
23139
Sonnige Balkone, herrlicher Bergblick, helle Wohnungen in ruhiger Lage und familiärer Atmosphäre. Grillhütte, Spielzimmer, Rad-/Skiraum.
Martina und Albert Burger
Untermühlegg 9 · 87538 Bolsterlang Tel. 08326 384658 info@biohof-burger.de www.biohof-burger.de
1jmowIrq
3 FeWos, 44-78 qm, 1-4 Pers. FeWo € 55,- bis 150,- (2 Pers.) je weitere Pers. € 11,- bis 15,-
21714
Ankommen & Wohlfühlen. Das Allgäu genießen in unserem familiär geführten Landhaus mit Wellnessbereich, einem Parkplatz vor dem Haus und freiem Bergblick.
Friederike Sauter Goldbachweg 7 · 87538 Bolsterlang Tel. 08326 9055 info@landhaus-exclusiv.de www.landhaus-exclusiv.de
1mwxIgbq
6 FeWos, 45-50 qm, 2-4 Pers. FeWo € 65,- bis 95,- (2 Pers.) je w. Pers. € 10,- bis 15,- zzgl. Kurtaxe
21671
Gästehaus Sonnenberg
Gästehaus Martin


Flurstr. 8 1F BBB
Komf. FeWo mit Ost-Südbalkon m. Bergblick, ruhige Lage. Wohnzi., sep. Schlafzi., Küche, Du/WC, LCD-TV, Stereoanlage, Wecker, Safe, Mikrowelle.
21673 1jmwIr3q
Richard Seider Dietrichs Nr. 6 · 87538 Bolsterlang Tel. 08326 36410 · Fax 8176 info@gaestehaus-sonnenberg.de www.gaestehaus-sonnenberg.de
2 FeWos, 46-82 qm, 2-4 Pers. FeWo € 70,- bis 140,(2 Pers.)
28998 qiImswx F4
1 FeWo, 57 qm, 1-3 Pers. FeWo € 60,- bis 75,- (2 Pers.) je weitere Pers. € 10,-
Bolsterlang
Landhaus Alpenflora Bolsterlang 1F BBBBB / 2F BBBB F4
Landhaus Bachtelmühle
BBBBB / 3F BBBB / 3F n.k. H2
Haus Alpensonne
1F BBBB / 2F BBB F4
3F
G2
Biohof Burger
BBBB
5F BBBB F5
5F BBBB / 1F BBB F4
Ruhige Waldrandlage, traumhafter Rundum-Blick auf die Allgäuer Berge und das Oberallgäuer-Golf-Resort mit gemütlichen FeWos inkl. Küche.
1F BBBB / 2F BBB G1
Ruth Dornach Burgschrofenweg 20 87538 Obermaiselstein Tel. 08326 1402 info@ferienwohnungen-dornach.de www.ferienwohnungen-dornach.de
Anmut und Eleganz beim langsamen Spannen der Sehne, ruhiges, konzentriertes Fixieren des Ziels und die sich entfaltende Dynamik des Pfeils beim Öffnen der Finger - Faszination, Bogenschießen. Zielsicher am Bogenübungsplatz, 3D Talparcours oder 3D Alpenparcours am Berg auf 1.340m. 123 FERIENWOHNUNG
Zielen - Spannen - Treffen
Bolsterlang
10 FeWos, 1-7 Pers.
4 x 1-Raum, 25-30 qm, € 40,- bis 80,-

4 x 2-Raum, 35-60 qm, € 60,- bis 120,-
1 x 3-Raum, 65 qm, € 80,- bis 160,-
1 x 4-Raum, 80 qm, € 100,- bis 200,-


Landhaus Goldener Apfel
j1lmsw Irbdqz
Charivari Landhaus · Goldbachweg 6 · 87538 Bolsterlang Charivari Ferienwohnungen · Berger Steige 1 · 87538 Fischen Tel. 08326 36000 · info@charivari-ferienwohnungen.de www.charivari-ferienwohnungen.de
Im Sommer freie Fahrt mit den Hörnerbahnen!
Unser Landhaus befindet sich in bevorzugter, ruhiger Ortsrandlage, von dem aus die touristischen Einrichtungen zu Fuß erreichbar sind. Vom romantischen Apartment mit Himmelbett bis zur 3- und 4-RaumWohnung mit 2 Bädern finden Familien jeder Größe eine passende Unterkunft für einen gelungenen Urlaub in den Bergen.

Für Gruppen steht ein komfortabler Aufenthaltsraum zur Verfügung. Die Wohnungen sind gemütlich im Landhausstil eingerichtet und mit Echtholzparkett ausgestattet. Jede mit abgeschlossenem Balkon und herrlicher Aussicht auf die Berge. Kleiner Wellnessbereich mit Sauna, Infrarotkabine, Solarium und Liegeraum. Frühstück zubuchbar (ca. 300 entfernt).
Christa Korte
Dorfstraße 21 · 87538 Bolsterlang Tel. 08326 3856085 o. 0170 7836315
info@landhaus-bolsterlang.de · www.landhaus-bolsterlang.de
Familiengeführtes Tradtionsgästehaus mit viel Service!
Günstig am südlichen Ortsrand von Bolsterlang gelegen, ist das Landhaus Goldener Apfel der gemütliche Ausgangspunkt für Ihren Urlaub in den Hörnerdörfern. Genießen Sie das reichhaltige Frühstücksbuffet im gemütlichen Gastraum und starten Ihre Rad- oder Wandertour, den Ausflug in die Umgebung oder den Skitag direkt von unserem Haus aus (ca. 5 Min. zu Fuß zum Lift und 1 Min. zum Loipeneinstieg). Auf Wunsch verwöhnen wir Sie mit Halbpension sowie Kaffee und Kuchen.

Alle Zimmer und die großzügige Ferienwohnung verfügen über Balkon oder Terrasse mit Bergblick. Die Doppelzimmer bestehen überwiegend aus 2 Räumen.
Ferienwohnungen Bergidyll
Im Sommer Hörnerbahnen kostenfrei nutzen!
Mitten im Dorf, dennoch ruhig liegt unser kleines Ferienhaus in einem eingezäunten Garten. Einer Großfamilie oder Gruppe bieten 5 Schlafzimmer, 3 Bäder, ein gemütl. Wohnzimmer sowie eine vollausgestattete Küche mit großem Esstisch genügend Platz für einen erholsamen Urlaub in den Bergen. Im Sommer stehen Kinderspielgeräte u. ein Grill zur Verfügung. Kostenfrei nutzbare Sauna, Fahrradgarage u. ausreichend Parkplätze.
1
Kapellenweg 2, 2a, 2b
87538 Bolsterlang
Charivari Ferienwohnungen
Tel. 08326 36000
info@charivari-ferienwohnungen.de www.charivari-ferienwohnungen.de
Im Sommer Hörnerbahnen kostenfrei!
Die aus 3 Häusern besteh. Fewoanlage liegt ideal am Ortsrand. Minigolf, Kinderspiel- u. Bogenübungsplatz befinden sich in Sichtweite. Der Dorfladen, einige Restaurants sowie Dorflift mit Skischulen u. Loipen sind zu Fuß erreichbar. Wir bieten familienfreundliche u. komfortabel ausgestattete Fewos mit 1 oder 2 Schlafräumen, einige mit Kaminofen. Jede hat einen Balkon o. Terrasse mit schöner Aussicht auf die Berge. Freies W-LAN.
6 FeWos, 2-7 Pers.
1 x 2-Raum, 50 qm, € 60,- bis 110,-
5 x 3-Raum, 65-80 qm, € 80,- bis 160,-
 Charivari Landhaus
Charivari Landhaus
21664 F4
6 DZ, 1 FeWo, 70 qm, 1-6 Pers. ÜF € 60,- bis 100,- / HP € 80,- bis 120,FeWo € 120,- bis 160,- (2 Pers.) je weitere Pers. € 20,-
F4 mqnIzrbs 29050
Almliesel
ce1hjm nwxIq7
29741
Ferienhaus
F4
FH, 140 qm, 5-12 Pers. € 160,- bis 320,-
Goldbachweg 14 · 87538 Bolsterlang Charivari Ferienwohnungen Berger Steige 1 · 87538
36000
jmswIr5z 21669
Fischen Tel. 08326
info@charivari-ferienwohnungen.de www.charivari-ferienwohnungen.de
F4
124 FERIENWOHNUNG
Ferienhaus Himmelswies Ferienwohnung Gamswinkel
Im Sommer Hörnerbahnen kostenfrei nutzen!
Die Häuser befinden sich im idyllischen Kierwang, nur 1 km von der Hörnerbergbahn entfernt.
Das bezaubernde Haus Himmelswies liegt in einem eingezäunten Garten u. besteht aus 2 gr. FeWos im EG u. DG. Im UG befinden sich Sauna u. Infrarotkabine (kostenfrei).
29042
Ortsstraße 19 u. 19a
87538 Bolsterlang-Kierwang Charivari Ferienwohnungen Tel. 08326 36000 info@charivari-ferienwohnungen.de www.charivari-ferienwohnungen.de
jmwIzrbq
FeWo Bergkristall, Rathausweg 2 F4
FeWo Gamswinkel erstreckt sich über das gesamte DG u. bietet 8 Pers. viel Platz für einen erholsamen Urlaub in den Bergen. Haustiere willkommen.
4 DZ mit Du/WC, teils SAT-TV, reichhaltiges regionales Frühstück und 2 FeWos, alle mit Südbalkon. Loipe und Hörnerbahn in direkter Nähe.
Christof Endreß Stuibenstraße 3 87538 Bolsterlang Tel. 08326 672 · Fax 8130 info@hausalpina.de www.hausalpina.de
e1Invwxq
21676
3 FeWos, 100 qm, 2-8 Pers. 3 x 4-Raum, € 110,- bis 230,-



Ferienhaus Brigitte − Ferienwohnungen

G3
4 DZ, 2 FeWos ÜF € 22,50 bis 33,FeWo € 37,- bis 76,50
Gästehaus Eberle E4
Liebevoll eingerichtete 65 qm FeWo mit Spülmaschine, Mikro, Backofen, Flachbildschirm. Zentrale Lage, Lifte, Loipe & Bushaltestelle in der Nähe.
Unser Haus liegt in herrlicher AussichtslageimGundelsbergerDorfNr.3. Mit freiem Bergblick auf die Oberallgäuer Berge.
Genießen Sie Ihren Urlaub in unseren gemütl. FeWos mit Südbalkon od. Terrasse und Bergblick. Wanderwege, Loipen, Skilift in unmittelbarer Nähe.
29057 hilmswxq
Jörg Vogel Rathausweg 2 87538 Bolsterlang Tel. 0173 2732345 kontakt@bergkristall-allgaeu.de







1 FeWo, 65 qm, 2 Pers. FeWo € 50,- bis 80,- (2 Pers.) je weitere Pers. € 10,-
Ferienwohnung Gänseliesl
Ferienwohnung Gänseliesl: Liebevoll einger. FeWo „zum Wohlfühlen“ (allergikerfreundlich). Küche, herrlicher Balkon mit Bergsicht & zentrale Lage.
Maximilian Renn Hörnerstraße 1 87538 Bolsterlang Tel. 08326 7909 · Fax 366795 fewo-gaenseliesl@web.de
29005 hinswxIq
1 FeWo, 48 qm, 1-4 Pers.
FeWo € 50,- bis 80,(1-4 Pers.)
Brigitte Papst Gundelsberg 3 87538 Bolsterlang Tel. 08326 7196 · Fax 7196 ferienhausbrigitte@web.de
21709 1hijlmxI
2 FeWos, 35-70 qm, 2-4 Pers. FeWo € 38,- bis 68,- (2-4 Pers.)
„Beim Hansbader“
FeWo „Familie Mohn“: 50 qm, 2 sep. Schlafzimmer, 1-3 Personen FeWo „rote Gerbera“: 35 qm, 1 sep. Schlafzimmer, 1-2 Personen
Franz und Sabine Natterer Sonderdorf 25 · 87538 Bolsterlang Tel. 08326 35122 · Fax 3859218 info@ferienwohnung-natterer.de www.ferienwohnung-natterer.de
29034 hijmxIq
2 FeWos, 35-50 qm, 1-3 Pers.
FeWo € 50,- bis 70,- (2 Pers.) je w. Pers. € 7,50 inkl. KT
Bernhard Eberle Stuibenstraße 1 87538 Bolsterlang Tel. 08326 1600 gaestehaus-eberle@t-online.de
21717 1hilmoxI
3 FeWos, 45-60 qm, 2-5 Pers. FeWo € 57,- bis 64,- (2 Pers.) je weitere Pers. € 10,- bis 12,-
Ferienwohnungen Hartmann
Ruhiges,gemütliches,familienfreundl. Haus mit herrlichem Blick auf die Allgäuer Bergwelt. Ferienwohnungen für 2-5 Personen. Loipe am Haus.
Waltraud Hartmann
Ortsstraße 23 a 87538 Bolsterlang-Kierwang Tel. 08326 7763 hartmann.kierwang@gmx.de
29025 iklsxq7
2 FeWos, 25 und 50 qm, 2-5 Pers.
1 FeWo € 25,- bis 30,- (2 Pers.) 1 FeWo € 30,- bis 50,- (2-5 Pers.)
Ruhige, gemütl., Fewos im modernen LandhausstilmitSüdterrasse,am südl. Ortsrand, Nähe Skilift/Loipe/Wanderwege,günstigeVor-/Nachsaisonpreise. Günter Müller & Birgit Müller-Salathé Bolgenstr. 14a · 87538 Bolsterlang Tel. 06325 7820 · Fax 988912 Mobil 0170 7004842 post@haus-arnika-bolsterlang.de www.haus-arnika-bolsterlang.de
hilmwxqI
2 FeWos, 28-40 qm, 2-4 Pers. FeWo € 41,- bis 52,- (2 Pers.) je weitere Pers. € 6,- bis 8,-
21702
Unser Haus mit 2- und 3-Raum-Wohnungen liegt in ruhiger, sonniger Ortsrandlage. Alle Wohnungen verfügen über Südbalkon mit Bergblick.
Wolfgang Kaecke Weiherkopfweg 1 87538 Bolsterlang Tel. 08326 385190 · Fax 385188 info@haus-ferienglueck.com www.haus-ferienglueck.com
21721 ijmwxIq
1 FeWo, 50 qm, 2-3 Pers., 3 FeWos, 60-75 qm, 2-4 Pers. FeWo € 42,- bis 53,- ( 2 Pers.)
Haus am Bächle F5 FERIENWOHNUNG
Ruhige, sonnige Lage mit herrlichem Bergblick. Eine großzügige FeWo mit 2 Schlafzimmern. Loipe und Lift am Haus.
Manfred Vachenauer
1 FeWo, 50-75 qm, 2-4 Pers. FeWo € 50,- (2 Pers.) je weitere Pers. € 15,-
21700 ijlmwxq5 125
Bolsterlang
E2
Haus Alpina E4
E4
Haus Arnika
Haus Ferienglück E4
E4
E5
E2
Goldbachweg 4 · 87538 Bolsterlang Tel. 08326 1748 o. 0160 97042869 manfred.vachenauer@gmx.de www.ferienwohnung-bolsterlang.com
Bolsterlang
Ferienwohnung Kapellenblick
In der luxuriösen 3-Raum-Wohnung mit Bergblick auf Nebelhorn und Alpensilhouette fühlt man sich sofort wohl. Nah zu den Liftstationen gelegen.
Steffi Hartmann · Flurstr. 6 87538 Bolsterlang Tel. 08326 381734 hartmann-bolsterlang@t-online.de www.kapellenblick-fewo.de
hjlmsIr5
1 FeWos, 70 qm, 2-4 Pers. Preis auf Anfrage
Ferienwohnung
Nehring E4
29060
In ruhiger, sonniger Ortsrandlage liegt unser Haus. Wir bieten Ihnen komf. Fewos mit herrlicher Bergsicht und direkter Verbindung zum Skilift.
Ludwig Lacher
Hochwiesweg 22 · 87538 Bolsterlang Tel. 08326 8140 oder 0160 92533426 · Fax 38050 info@landhaus-lacher.de www.landhaus-lacher.de


1ilmnwxI
5 FeWos, 36-48 qm, 2-4 Pers. FeWo € 55,- bis € 80,- (2 Pers.) Allgäuer Hörnerbahnen gratis




Ferienwohnung Neuhauser
Ruhig gelegen ist unser Landhaus am südlichen Ortsrand mit freiem Blick auf Wiesen und Berge. Zwei gemütl. eingerichtete FeWos mit Südbalkon.
21688
Willi Martin
Zum Hasenacker 2 87538 Bolsterlang Tel. 08326 8263 · Fax 8265 landhaus-martin@maxi-allgaeu.de

hilmsxI
2 FeWos, 40 qm, 2-4 Pers. FeWo € 38,- bis 41,- (2 Pers.) je weitere Pers. € 8,-
Landhaus Rapp E3
21738
Unser familiär geführtes Bauernhaus liegt in ruhiger Lage von Sonderdorf. Skilifte, Loipen und Wanderwege liegen in unmittelbarer Nähe vom Haus.

Hans-Peter Natterer Sonderdorf 3 · 87538 Bolsterlang Tel. 08326 384525 info@landhaus-natterer.de

hilmwxIq
2 FeWos, 50-60 qm, 2-3 Pers. FeWo € 56,- bis € 62,- (2 Pers.) je weitere Pers. € 7,- bis 10,-
F4
Ruhige Bestlage am Skigebiet, traumhafterPanoramablickausderWohnung, 1 Wohn-Schlafzi., zusätzl. Schlafzi. Du/ WC, Küche, Balkon, Sat-TV, Parkplatz.

Christian Nehring Hochwiesweg 20 · 87538 Bolsterlang Tel. 08341 991722 o. 0171 6909474
Gemütlich einger. FeWo für 2-3 Personen im DG mit Ost- und Südbalkon. Schlafraum, Wohn-Schlafraum und separate Küche. Inkl. Kurtaxe.
2 herrl. gelegene FeWos mit einmal. Bergblick in ruhiger Lage, großer Liegewiese und Parkplätze. FeWos mit Balkon, Brötchen- u. Getränkeservice.

Unser wunderschön gelegenes Haus finden Sie in ruhiger, sonniger Lage am südlichen Ortsrand mit unverbautem Blick auf die Allgäuer Bergwelt.
29030
Fax 68140 · ch.nehring@t-online.de http://home.ferienwohnungen.de/ ferienwohnung-nehring
29119 hijlIwxq
1 FeWo, 41 qm, 2-4 Pers. FeWo € 60,- bis 75,- (2 Pers.) je weitere Pers. € 10,- / mind. 3 Nächte
Gasthof Riedbergerhorn
Das Haus mit Tradition! NEUE FeWos. Familiärer Gasthof. Ruhige Lage. Schöner Bergblick. Entspannende Sauna.
Gasthof Riedbergerhorn GmbH & Co. KG
Sonderdorf 8 · 87538 Bolsterlang Tel. 08326 8349 · Fax 8230 info@riedbergerhorn.de www.riedbergerhorn.de
21666 ilmwxIbq
4 FeWos, 43-98 qm, 2-4 Pers.
1. Tag € 140,- bis 325,ab 2. Tag € 80,- bis 225,- (2 Pers.)
Claudia Neuhauser Goldbachweg 8 · 87538 Bolsterlang Tel. 08326 9682 f.neuhauser@t-online.de www.ferienwohnung-neuhauser.de
25054 hilmwxIq
1 FeWo, 51 qm, 2-3 Pers. FeWo € 58,- bis 64,- (2 Pers) je weitere Pers. € 10,-
Ferienwohnungen Schmid F4
Christa Rapp Angerweg 8 87538 Bolsterlang-Kierwang Tel. 08326 1078 Landhausrapp@gmx.de
1ilmnxrq
2 FeWos, 40 qm, 1-4 Pers. FeWo € 45,- bis 55,- (2 Pers.) je weitere Pers. € 10,-
Ferienhof Schmidt
G2
21742
Angelika Renn Hochwiesweg 21 87538 Bolsterlang Tel. 08326 1480 · Fax 3849796 info@haus-renn.de www.haus-renn.de
21745 1ilmnwIq
3 FeWos, 50 qm, 2-4 Pers. FeWo € 65,- bis 72,- (2 Pers.) je weitere Pers. € 10,- bis 15,-
Haus Schöll
UnserHausliegtamOrtsrandineinem liebevoll gepflegten Blumengarten. Hier finden Sie die idealen Voraussetzungen für erholsame Ferientage.
Karlheinz Schmid
Zum Hasenacker 1 87538 Bolsterlang Tel. 08326 36170 · Fax 361711 info@ferienwohnungen-schmid.com www.ferienwohnungen-schmid.com
hijlmnIs
2 FeWos, 50-70 qm, bis 4 Pers. FeWo € 47,- bis 67,- (2 Pers.) je weitere Pers. € 6,- / inkl. ER
21692
Freistehendes Ferienhaus u. eine FeWo in ruhiger Lage im alpenländischen Stil mit Küche, Dusche/WC und Balkon. Kinderfreundlich.

Sehr ruhige Lage mit traumhaftem Bergblick. 3 FeWos mit 1 separatem Schlafzimmer,1FeWomit2separaten Schlafzimmern.
Christoph Schmidt
Untermühlegg 12 87538 Bolsterlang Tel. 08326 3849949 schmidt-bolsterlang@t-online.de
29037 joswIql
1 FH, 1-4 Pers. / 1 FeWo 1-2 Pers. € 65,- bis 74,- (2 Pers.) je weitere Pers. € 10,- bis 20,-
Gebhard Schöll
Sonderdorf 2 · 87538 Bolsterlang Tel. 08326 1873 · Fax 385038 fewoschoell@gmx.de www.ferienwohnungen-schoell.de
hijlmxIq
4 FeWos, 48-70 qm, 2-4 Pers. FeWo € 59,- bis 82,- (2 Pers.)
21748
Landhaus Lacher E5
Landhaus Martin E5
Landhaus Natterer E5
Haus Renn E5
E5
126 FERIENWOHNUNG
E5
Lassen Sie sich verzaubern vom unverbauten Rundumblick unseres Hauses in d. Allgäuer Bergwelt. Gemütl. komfortabel einger. FeWos m. Balkon.

Monika Sichler
Untermühlegg 18 · 87538 Bolsterlang Tel. 08326 8398 mgsichler@t-online.de www.ferienwohnungen-sichler.de


1hijmwrq
2 FeWos, 45-80 qm, 2-6 Pers. FeWo € 50,- bis 85,- (2 Pers.) Aufpreis j. n. Saison u. Aufenthaltsdauer
Ferienwohnung
Unser alleinstehendes Haus mit freiem Blick in die Berge, befindet sich in einmalig ruhiger u. sonniger Lage. Gemütl. und komfortable FeWos mit Balkon.
21755
Elfriede Tannheimer
Obermühlegg 4 · 87538 Bolsterlang Tel. 08326 7767 info@haus-tannheimer.de www.haus-tannheimer.de
1Iilmnsx
3 FeWos, 30-53 qm, 2-4 Pers. FeWo € 45,- bis 60,- (2 Pers.) je weitere Pers. € 10,-
21693
Herzlich Willkommen auf unserem kinderfreundlichen Bauernhof. Unser Haus befindet sich in traumhafter Lage mit Blick in die Allgäuer Berge.

Bianca Vogler Bauhof 1 87538 Bolsterlang-Kierwang Tel. 08326 486 vogler-maximilian@web.de
1ijlmosq
3 FeWos, 45-80 qm, 2-6 Pers. FeWo € 45,- bis 50,- (2 Pers.) je weitere Pers. € 5,-
29018
Familiär geführter Bauernhof. Es erwarten Sie 2 liebevoll eingerichtete FeWos mit Ostbalkon und Blick in die Berge. Wir freuen uns auf Sie!
Rudolf u. Brigitte Vogler
Untermühlegg 6 · 87538 Bolsterlang Tel. 08326 7865 · Fax 384031 Ferienhof.Vogler@t-online.de www.ferienhof-vogler.de
1ijlmwI
2 FeWos, 40-50 qm, 2-4 Pers. FeWo € 75,- (2 Pers.) bis 110,- (4 Pers.) / inkl. ER
• Steinzeit Memo. An der Mittelstation der Hörnerbahn Bolsterlang. Im Sommer täglich geöffnet. Mehr Informationen: www.hoernerdoerfer.de/steinzeitdorf Steinzeitdorf
29038
Unser gepflegtes Haus bietet Ihnen eine gemütliche, komfortable FeWo mit Süd- und Westbalkon für 2-5 Pers. mit herrlichem Bergblick.
Josef Wucherer Sonderdorf 30 a 87538 Bolsterlang Tel. 08326 8329 · Fax 381585 a-j.wucherer@t-online.de www.ferienwohnung-wucherer.de
23146 1hijlsxI
1 FeWo, 60 qm, 2-5 Pers. FeWo € 65,- (2 Pers.) je weitere Pers. € 10,-
IMPRESSUM
Herausgeber: Tourismus Hörnerdörfer GmbH Am Anger 15 | 87538 Fischen i. Allgäu Tel. 08326 36460 | www.hoernerdoerfer.de

Gesamtkonzeption, Gestaltung und Anzeigenverwaltung: Tanner Werbung GmbH | Tel. 08361 9207-0 | info@tanner-werbung.com Stand der Anzeigen: August 2022
Druck:
Konradin Druck GmbH
Gesamtauflage: 30.000 Änderungen vorbehalten! Alle Angaben ohne Gewähr. Gültig ab Dezember 2022.
Bildquellen/Fotografie:
Tourismus Hörnerdörfer, Allgäu GmbH, Allgäu Lichtbild, Allgäuer Salzgrotte, Alpsee Bergwelt, Braun R., Bruckmeier S., Eichholzer G., Frizbee.at, Gesundes Bayern, Gretler T., Gschwender J., Hubertus Mountain Refugio Allgäu, Kappest K.-P., Kjer F., Larsch G., Lübke R., Monschau W., Mühlegg N., Naturpark Nagelfluhkette, Neumann-grafik, ProVisionMedia, Retzlaff R., Roth D., Sennerei Hüttenberg, Schöllhorn R., Schrott B., Stache C., Outdoor, Schwabe G., Skywalk Allgäu, Wonnemar Sonthofen, www.berge.at, www.tanner-werbung.com

fotolia: go (Loden), monticellllo, Friedberg pixabay: congerdesign (Ostereier)
Adobe Stock: airmel, Alexandr-Bakanov, Aleksandra-Smirnova, alhontess, artefacti, Bitter, CNuisin, Danussa, doublebubble_rus, dwph, endstern, Hein-Nouwens, Hetizia, istry, IvanBaranov, Kate-Macate, Johannes Netzer, Joerg-Mikus, kuco, lilkin, lo0kus, LovelyLittlr, Maren Winter, Marina, margostock, Maria-Epine, Morphart, mozart3737, MOSTOVJI, natality, Natalya-Levish, Oleksandr-Babich, Olena, onkachura, ONYX-prj, oxinox, Pawel, Pashabo, Perysty, PikePicture, Pracownie-art, Roman-Bykhalov, Sad, sandipruel, Sergejs-Katkovskis, Scanrail, teploleta, Travel-Drawn, vasyamazyra, vectortatu, Vlada-Young, vladischern, WATCHARAPONG-THAWAORNWICHIAN, Wiktoria-Matynia,
Kartenmaterial: sitour Werbe GmbH, Outdooractive GmbH, Oberbacher
Bolsterlang
 Haus Sichler
H2
Haus Tannheimer G3
Landhaus Vogler E2
Haus Sichler
H2
Haus Tannheimer G3
Landhaus Vogler E2
G2
Ferienhof Vogler
•
•
•
•
127 FERIENWOHNUNG
Wucherer E5 Steinzeitdorf Bolsterlang Steinzeitbohrer
Abenteuerweg
Ausgrabungsstätte
Gerbstation
Klanghölzer
Balderschwang
 HörnerDörfer
HörnerDörfer
Wer vom Riedberger Horn auf 1.787 Metern Höhe hinunterschaut ins Balderschwanger Hochtal, gerät ins Träumen: Dunkler Bergwald und sonnige Alpwiesen flankiert vom Siplingerkopf auf der einen und dem Piesenkopf auf der anderen Seite, darin ein Dorf, das echte Allgäuer Beschaulichkeit ausstrahlt.
Balderschwang ist klein – oder vielmehr: konzentriert. Denn hier finden High-Class Wellness, stille Wanderwege oder familiäres Schneevergnügen zusammen.
Rundum erstreckt sich der Naturpark Nagelfluhkette und seine einzigartige Vielfalt zeigt sich im Sommer auf dem „sich Zit long“- Themenweg ebenso wie beim Besuch der Sennalpen, beim Kirchweihfest Bergkilbe, dem Viehscheid oder wenn bei der Alphorniade die traditionsreichen Hörner erklingen. Das schneesichere Tal bietet im Winter rund 40 Pistenkilometer und ein 40 Kilometer Loipennetz, das direkt an das der Vorarlberger Nachbarn angeschlossen ist. Und Angebote wie Skikindergarten, Schneeschuhtouren oder Kutschfahrten sorgen für entspannte Tage auf und abseits der Piste.

128
im AlpDorfIdyllisch








129
Naturgenuss mit Ausblick Wandern im Naturpark Tradition im AlpDorf Wintersport auf der Grenzland-Loipe Geführte Schneeschuhtouren Winter erleben



130



131
Bio-Berghotel Ifenblick aaaSuperior B3

Kienle - das Kräuterhotel
BerghoteI Ifenblick
Bianca Schießl e. K. · Gschwend 49 87538 Balderschwang Tel. 08328 92470 · Fax 9247200
info@berghotel-ifenblick.de www.berghotel-ifenblick.de
cmnIabq2
Das Hotel (1.100 m) liegt idyl lisch u. abseits von Lärm u. Hek tik. Es bietet in den Bereichen Natur, Ernährung, Bewegung u. Selfness einen erstklassigen Rahmen, Sie nehmen sich den Rest. Frische Luft, grüne Wiesen, kraftvolle Berge – intakte Natur u. gesundes Klima erwarten Sie. 2019 wurden alle Zimmer neu renoviert. Eine natürliche, gesun de Küche aus regionalen Produkten in zertifizierter BioQualität bietet Ihnen sowohl eine ausgewogene als auch individuelle Ernährung. Zubereitung in der offenen Küche.
10 EZ, 31 DZ davon 18 MBZ
VP € 132,- bis 176,-

HUBERTUS Mountain Refugio Allgäu
Familie Konrad Kienle
Dorfplatz 3 · 87538 Balderschwang Tel. 08328 924920 · Fax 92492325 info@hotel-kienle.de www.hotel-kienle.de
cmowrgbf
den Frühling spüren. den Sommer genießen. den Herbst entdecken. den Winter erleben.
Seit über 200 Jahren leben wir Gasthaustraditionen.
Im Schnee das Winterparadies vor der Haustür und in unserem Kräutergarten mit 5.000 qm den Sommer kennenlernen. Genießen Sie Ihren Urlaub im Herzen der Berge und lassen Sie uns zu Ihrem Urlaubszuhause werden.
3 EZ, 25 DZ, 4 Suiten, 5 FeWos HP € 60,- bis 152,FeWo im Gästehaus € 60,- bis 140,ÜF Jagdhütte € 25,- bis 60,-
Gebr. Traubel GmbH Dorf 5 · 87538 Balderschwang Tel. 08328 9200 · Fax 920100 info@hotel-hubertus.de · www.hotel-hubertus.de
Es gibt ORTE. Die uns tief berühren. Die etwas in uns auslösen. Und uns für immer verändern. MAGISCHE ORTE
Das HUBERTUS Mountain Refugio ist so ein Ort. Denn hier verbindet sich der Mensch und die NATUR auf eine Weise, die berührt. Neue IMPULSE werden wach. Und begleiten einen. Weit über den Urlaub hinaus. Unser neuer Mountain Spring Spa trägt dazu bei. Mit viel Raum und Zeit für Menschen & Bedürfnisse. Außergewöhnliche Treatments von behutsamen Händen, Naturbadesee, Infinity-Pool, Rooftop mit Onsen, Saunabereich, Yogaplattformen u.v.m. laden ein. Zu Sinnlichem & Schönen. Zu Gesundheit & Fitness. Zu Erholung & Erfrischung. Und auf eine Reise. Zum Ich.


Torgheleʼs Wald & Fluh
Klopf, Klopf. Gestatten: Wald und Fluh. Ob Winter oder Sommer – hier wohnt Ihr Aktiv- und Wellnessurlaub. Mit neuem Konzept und und gewohnter Herzlichkeit bietet Torgheleʼs Wald und Fluh nun noch mehr Komfort und Urlaubsgenuss im malerischen Allgäu. Erleben Sie Ihr persönliches Urlaubsglück mit allen Sinnen, spüren Sie den Inbegriff der Nachhaltigkeit und die unberührte Natur. Torgheleʼs Land ist wahrlich ein Ort zum Entdecken.
Unser Familienhotel in Balderschwang ist ein Erlebnis für die ganze Familie, aber auch für Ihre Vierbeiner.

Na, neugierig geworden? Das sind wir. Wald und Fluh. Torgheleʼs eben.

Balderschwang
28580
B4
cmnswx rIb24f 5 EZ, 13-20 qm, 37 DZ, 17 Junior
26-40 qm 7
47-60 qm EZ & DZ VP € 160,- bis 270,Junior Suite & Suite VP € 200,- bis 330,21627 B4
Suiten,
Suiten,
Torgheleʼs Wald & Fluh GmbH Schlipfhalden
Balderschwang Tel.
cnosIr gab24f 3 EZ, 42 DZ, 14 MBZ 4 FeWos, 26-75 qm, 2-5 Pers. Preis auf Anfrage 21626 E2 132 HOTEL
31 · 87538
08328 1052 · Fax 381 info@torgheles-hotelerei.com · www.torgheles-hotelerei.com
Balderschwang
FeWo-Neubau nach neuesten ökologischen Standards, ruhige Südhanglage, alle m. Südbalkon/Terrasse, Fitnessraum, Panoramasauna, Lift im Haus.
Peter Fischer
Oberberg 13 · 87538 Balderschwang Tel. 02328 9247520 obenamberg@web.de www.obenamberg.de






29910 1swIb4qf
6 FeWos, 43-91 qm, 2-6 Pers. FeWo € 70,- bis 210,- (bei 2-4 Pers.) je weitere Pers. € 15,-
Haus Waldeck B4
Baubiologisches, wohngesundes Holzhaus im alpenländischen Stil. In sonniger Lage am Waldrand. Loipe, Lifte, Wanderwege ohne Auto erreichbar. W-LAN in den Wohnungen.

Peter Kienle
Dorf 3 1/2 · 87538 Balderschwang Tel. 08328 258 kontakt@haus-waldeck.info www.haus-waldeck.info

21641 jmnswxq5
3 FeWos, 50-61 qm, 1-5 Pers. FeWo € 70,- bis 130,- (2 Pers.)
134 FERIENWOHNUNG
Rosa-Maria Lang
Drei gemütl. FeWos mit Wohnküche, Du/WC, TV, sonnigem Balkon, in ruhiger Lage, Getränke-/Brötchenservice. Großer Bauernhof, Skilift und Loipe direkt in der Nähe. 21655
Au 19 · 87538 Balderschwang Tel. 08328 1086 o. 0160 92460367 o. 0151 54049073 Fax 924055
1ilmnxIq
3 FeWos, 38-44 qm, 2-4 Pers. FeWo € 35,- bis 70,- (2 Pers.) je weitere Pers. € 10,-
Haus im Wäldle B5
In unserem modernen Holzhaus erwarten Sie 2 gemütl. eingerichtete FeWos mit Sonnenterrasse, direkt an Loipe und Wanderwegen, Liftnähe.
Christine und Andreas Martin Wäldle 87 · 87538 Balderschwang Tel. 08328 924037 info@landhaus-schwarzenberg.de www.landhaus-schwarzenberg.de
1ilmoxIr
2 FeWos, 35-40 qm, 1-4 Pers. FeWo € 49,- bis 69,- (2 Pers.) je weitere Pers. € 5,-
28808
Ein Zuhause auf Zeit, ein Rückzugsort. Sechs Suiten und fünf FeWos. Echt alpin, stilvoll und natürlich.
29936 e1mxIzbq
5 FeWos, 6 Suiten, 35-60 qm, 1-4 Pers. ÜF € 50,- bis 99,FeWo € 60,- bis 170,- (2 Pers.)
So muss Urlaub sein! Bei uns wohnen Sie in geschmackvoll eingerichteten FeWos direkt an der Loipe und in Skiliftnähe. Nichtraucherhaus.

Heidi Martin Wäldle 91 · 87538 Balderschwang Tel. 08328 924744 · Fax 924746 info@haus-im-waeldle.de www.haus-im-waeldle.de
1ijlwIbs
28809
FeWo m. sep. Wohn- u. Schlafzimmer, kompl. ausgestatt. Küche (o. Spülm.), Südbalkon, TG-Stellplatz. Direkt an der Loipe, Lift zu Fuß erreichbar.
Karl-Ludwig Weber Gschwend 26 87538 Balderschwang Tel. 04242 5746400 Mobil 0151 70166751 kawesy@freenet.de
28810 ilmxz5I
Winterfest „Feuer & Eis“der perfekte Aprés-Skiabend
Genießen Sie in heimeliger Atmosphäre einen schönen Winterabend in Balderschwang. Für das leibliche Wohl mit Glühwein, Punsch und vielen leckeren Köstlichkeiten wird gesorgt. Die richtige Musik darf an einem solchen Abend natürlich nicht fehlen. www.hoernerdoerfer.de Winterfest
Gästehaus Oben am Berg B5
Haus am Rauhbach B6
Landhaus Schwarzenberg B5
Siplinger Suites 9F n.k. 1F BBBBB / 1F BBBB
Holzmann Gastgeber GmbH Oberberg 3+6 87538 Balderschwang Tel. 08328 329 · Fax 375 info@siplinger-suites.de www.siplinger-suites.de B5
2 FeWos, 50-65 qm, 2-6 Pers. FeWo € 70,- bis 125,- (2 Pers.) / je weit. Pers. € 15,- / Kind bis 6 J. frei
1 FeWo, 1-4 Pers. FeWo € 55,- bis 85,- (1-4 Pers.) je weitere Pers. € 5,-
Ferienwohnung Weber B3




Balderschwang bundesweit im Digitalradio Tel: +49 8328 921-110 135 GEWERBE
Gastaufnahme- und Vermittlungsbedingungen
Sehr geehrter Gast, wir freuen uns über Ihr Interesse an der Buchung einer Unterkunft bei einem Gastgeber in den Allgäuer Hörnerdörfern. Im Falle des Zustandekommens eines Gastaufnahmevertrages werden der Gastgeber und (Hörnerdörfer Tourismus GmbH) – nachstehend „THG“ abgekürzt - ihre ganze Kraft und Erfahrung einsetzen, um Ihren Aufenthalt so angenehm wie möglich zu gestalten. Hierzu tragen auch klare rechtliche Vereinbarungen über Ihre Rechte und Pflichten als Gast und die Rechte und Pflichten Ihres Gastgebers bei, die mit Ihnen in Form der nachfolgenden Gastaufnahmebedingungen getroffen werden sollen. Diese Gastaufnahmebedingungen werden, soweit wirksam vereinbart, Inhalt des im Buchungsfall zwischen Ihnen und Ihrem Gastgeber zu Stande kommenden Gastaufnahmevertrages. Bitte lesen Sie diese Gastaufnahmebedingungen daher vor Ihrer Buchung sorgfältig durch.
1. Vertragsschluss
1.1. Für alle Buchungsarten gilt:
1.1.1. Grundlage des Angebots des Gastgebers und der Buchung des Gastes sind die Beschreibung der Unterkunft und die ergänzenden Informationen in der Buchungsgrundlage (z.B. Klassifizierungserläuterungen) soweit diese dem Gast bei der Buchung vorliegen.
1.1.2. Entsprechend den gesetzlichen Verpflichtungen wird der Gast darauf hingewiesen, dass nach den gesetzlichen Vorschriften (§ 312g Abs. 2 Satz 1 Ziff. 9 BGB) bei Gastaufnahmeverträgen, die im Fernabsatz (Briefe, Kataloge, Telefonanrufe, Telekopien, E-Mails, über Mobilfunkdienst versendete Nachrichten (SMS) sowie Rundfunk und Telemedien) abgeschlossen wurden, kein Widerrufsrecht besteht sondern lediglich die gesetzlichen Regelungen über die Nichtinanspruchnahme von Mietleistungen (§ 537 BGB) gelten (siehe hierzu auch Ziff. 4 dieser Gastaufnahmebedingungen). Ein Widerrufsrecht besteht jedoch, wenn der Gastaufnahmevertrag außerhalb von Geschäftsräumen geschlossen worden ist, es sei denn, die mündlichen Verhandlungen, auf denen der Vertragsschluss beruht, sind auf vorhergehende Bestellung von Ihnen als Verbraucher geführt worden; im letztgenannten Fall besteht ein Widerrufsrecht ebenfalls nicht.
1.2. Für die Buchung, die mündlich, telefonisch, schriftlich, per E-Mail oder per Telefax erfolgt, gilt:
1.2.1. Mit der Buchung bietet der Gast dem Gastgeber den Abschluss des Gastaufnahmevertrages verbindlich an.
1.2.2. Der Vertrag kommt mit dem Zugang der Annahmeerklärung des Gastgebers (Buchungsbestätigung) beim Gast zustande. Sie bedarf keiner Form, so dass auch mündliche und telefonische Bestätigungen für den Gast und den Gastgeber rechtsverbindlich sind. Im Regelfall wird der Gastgeber dem Gast bei mündlich oder telefonisch erfolgten Buchungsbestätigungen zusätzlich eine schriftliche Ausfertigung der Buchungsbestätigung übermitteln. Mündliche oder telefonische Buchungen durch den Gast führen bei entsprechender verbindlicher mündlicher oder telefonischer Bestätigung durch den Gastgeber jedoch auch dann zum verbindlichen Vertragsabschluss, wenn dem Gast die entsprechende schriftliche zusätzliche Ausfertigung der Buchungsbestätigung nicht zugeht. 1.2.3. Unterbreitet der Gastgeber dem Gast auf dessen Wunsch hin ein spezielles Angebot, so liegt darin, abweichend von den vorstehenden Regelungen, ein verbindliches Vertragsangebot des Gastgebers an den Gast, soweit es sich hierbei nicht um eine unverbindliche Auskunft über verfügbare Unterkünfte und Preise handelt. In diesen Fällen kommt der Vertrag, ohne dass es einer entsprechenden Rückbestätigung durch den Gastgeber bedarf, zu Stande, wenn der Gast dieses Angebot innerhalb einer im Angebot gegebenenfalls genannten Frist ohne Einschränkungen, Änderungen oder Erweiterungen durch ausdrückliche Erklärung, Anzahlung, Restzahlung oder Inanspruchnahme der Unterkunft annimmt.
1.3. Bei Buchungen, die im Internet erfolgen, gilt für den Vertragsabschluss: 1.3.1. Mit Betätigung des Buttons (der Schaltfläche) „zahlungspflichtig buchen“ bietet der Gast dem Gastgeber den Abschluss des Gastaufnahmevertrages verbindlich an. Dem Gast wird der Eingang seiner Buchung unverzüglich auf elektronischem Weg bestätigt.

1.3.2. Die Übermittlung des Vertragsangebots durch Betätigung des Buttons „zahlungspflichtig buchen“ begründet keinen Anspruch des Gastes auf das Zustandekommen eines Gastaufnahmevertrages entsprechend seiner Buchungsangaben. Der Gastgeberist vielmehr frei in seiner Entscheidung das Vertragsangebot des Gastes anzunehmen oder nicht.
1.3.3. Der Vertrag kommt durch den Zugang der Buchungsbestätigung beim Gast zu Stande.
1.4. Erfolgt die Buchungsbestätigung sofort nach Vornahme der Buchung des Gastes durch Betätigung des Buttons „zahlungspflichtig buchen“ durch entsprechende Darstellung der Buchungsbestätigung am Bildschirm (Buchung in Echtzeit), so kommt der Gastaufnahmevertrag mit Zugang und Darstellung dieser Buchungsbestätigung beim Gast zu Stande. In diesem Fall wird dem Gast die Möglichkeit zur
Speicherung und zum Ausdruck der Buchungsbestätigung angeboten. Die Verbindlichkeit des Gastaufnahmevertrages ist jedoch nicht davon abhängig, dass der Gast diese Möglichkeiten zur Speicherung oder zum Ausdruck nutzt. Im Regelfall erhält der Gast zusätzlich eine Ausfertigung der Buchungsbestätigung per , E-Mail-Anhang, Post oder Fax übermittelt. Der Zugang einer solchen zusätzlich übermittelten Buchungsbestätigung ist jedoch nicht Voraussetzung .
2. Preise und Leistungen
2.1. Die in der Buchungsgrundlage (Gastgeberverzeichnis, Angebot des Gastgebers, Internet) angegebenen Preise sind Endpreise und schließen die gesetzliche Mehrwertsteuer und alle Nebenkosten ein, soweit bezüglich der Nebenkosten nichts anders angegeben ist. Gesondert anfallen und ausgewiesen sein können Kurbeitrag/Kurtaxe sowie Entgelte für verbrauchsabhängig abgerechnete Leistungen (z.B. Strom, Gas, Wasser, Kaminholz) und für Wahl- und Zusatzleistungen, die erst vor Ort gebucht oder in Anspruch genommen werden.
2.2. Die vom Gastgeber geschuldeten Leistungen ergeben sich ausschließlich aus dem Inhalt der Buchungsbestätigung, den Angaben zur Unterkunft und den Leistungen des Gastgebers in der Buchungsgrundlage sowie aus etwa ergänzend mit Ihnen ausdrücklich getroffenen Vereinbarungen.
3. Zahlung
3.1. Die Fälligkeit von Anzahlung und Restzahlung richtet sich nach der zwischen dem Gast und dem Gastgeber getroffenen und in der Buchungsbestätigung vermerkten Vereinbarung. Ist eine besondere Vereinbarung nicht getroffen worden, so ist der gesamte Unterkunftspreis einschließlich der Entgelte für Nebenkosten und Zusatzleistungen zum Aufenthaltsende zahlungsfällig und an den Gastgeber zu bezahlen.
3.2. Der Gastgeber kann nach Vertragsabschluss eine Anzahlung von bis zu 20% des Gesamtpreises der Unterkunftsleistungen und gebuchter Zusatzleistungen verlangen, soweit im Einzelfall zur Höhe der Anzahlung nichts anderes vereinbart ist.
3.3. Der Gastgeber kann bei Aufenthalten von mehr als 1 Woche nach deren Ablauf die Vergütung für zurückliegende Aufenthaltstage sowie für Zusatzleistungen (z.B. im Unterkunftspreis nicht enthaltene Verpflegungsleistungen, Entnahmen aus der Minibar) abrechnen und zahlungsfällig stellen.
3.4. Zahlungen in Fremdwährungen sind nicht möglich. Kreditkartenzahlungen sind nur möglich, wenn dies vereinbart oder vom Gastgeber allgemein durch Aushang angeboten wird. Zahlungen am Aufenthaltsende sind nicht durch Überweisung möglich.
3.5. Leistet der Gast eine vereinbarte Anzahlung und / oder die Restzahlung trotz einer Mahnung des Gastgebers mit angemessener Fristsetzung nicht oder nicht vollständig innerhalb der angegebenen Frist, obwohl der Gastgeber zur ordnungsgemäßen Erbringung der vertraglichen Leistungen bereit und in der Lage ist, kein gesetzliches oder vertragliches Aufrechnungs- oder Zurückbehaltungsrecht des Gastes besteht und hat der Gast den Zahlungsverzug zu vertreten, so ist der Gastgeber berechtigt, nach Mahnung mit Fristsetzung und nach Ablauf der Frist vom Vertrag mit dem Gast zurückzutreten und von ihm Rücktrittskosten gemäß Ziff. 4 dieser Bedingungen zu fordern.
4. Rücktritt und Nichtanreise
4.1. Im Falle eines Rücktritts oder der Nichtanreise des Gastes bleibt der Anspruch des Gastgebers auf Bezahlung des vereinbarten Aufenthaltspreises einschließlich des Verpflegungsanteils und der Entgelte für Zusatzleistungen, bestehen.
4.2. Der Gastgeber hat sich im Rahmen seines gewöhnlichen Geschäftsbetriebes, ohne Verpflichtung zu besonderen Anstrengungen und unter Berücksichtigung des besonderen Charakters der gebuchten Unterkunft (z.B. Nichtraucherzimmer, Familienzimmer) um eine anderweitige Verwendung der Unterkunft zu bemühen.
136
4.3. Soweit dem Gastgeber für den vom Gast gebuchten Zeitraum eine anderweitige Belegung möglich ist, wird er sich auf seinen Anspruch nach Ziffer 4.1. die Einnahmen aus einer solchen anderweitigen Belegung, soweit eine solche nicht möglich ist, ersparte Aufwendungen anrechnen lassen.
4.4. Nach den von der Rechtsprechung anerkannten Prozentsätzen für die Bemessung ersparter Aufwendungen, ist der Gast verpflichtet, unter Berücksichtigung gegebenenfalls nach Ziffer 4.3. anzurechnender Beträge an den Gastgeber die folgenden Beträge zu bezahlen, jeweils bezogen auf den gesamten Preis der Unterkunftsleistungen (einschließlich aller Nebenkosten), jedoch ohne Berücksichtigung von Kurbeiträgen:
• Bei Ferienwohnungen/Unterkünften ohne Verpflegung 90%
• Bei Übernachtung/Frühstück 80%
• Bei Halbpension 70%
• Bei Vollpension 60%
4.5. Es bleibt dem Gast ausdrücklich vorbehalten, dem Gastgeber nachzuweisen, dass die ersparten Aufwendungen wesentlich höher sind, als die vorstehend berücksichtigten Abzüge, bzw. dass eine anderweitige Verwendung der Unterkunftsleistungen oder sonstigen Leistungen stattgefunden hat. Im Falle eines solchen Nachweises ist der Gast nur verpflichtet, den entsprechend geringeren Betrag zu bezahlen.
4.6. Dem Gast wird der Abschluss einer Reiserücktrittskostenversicherung dringend empfohlen.
4.7. Die Rücktrittserklärung ist bei allen Buchungen direkt an den Gastgeber zu richten und sollte im Interesse des Gastes in Textform erfolgen.
5.
An- und Abreise
5.1. Die Anreise des Gastes hat zum vereinbarten Zeitpunkt, ohne besondere Vereinbarung spätestens bis 18:00 Uhr zu erfolgen.
5.2. Für spätere Anreisen gilt:
5.2.1. Der Gast ist verpflichtet, dem Gastgeber spätestens bis zum vereinbarten Anreisezeitpunkt Mitteilung zu machen, falls er verspätet anreist oder die gebuchte Unterkunft bei mehrtägigen Aufenthalten erst an einem Folgetag beziehen will.

5.2.2. Erfolgt eine fristgerechte Mitteilung nicht, ist der Gastgeber berechtigt, die Unterkunft anderweitig zu belegen. Für die Zeit der Nichtbelegung gelten die Bestimmungen in Ziff. 4 entsprechend.
5.2.3. Teilt der Gast eine spätere Ankunft mit, hat er die vereinbarte Vergütung, abzüglich ersparter Aufwendungen des Gastgebers nach Ziff. 4.4 und 4.5 auch für die nicht in Anspruch genommene Belegungszeit zu bezahlen, es sei denn, der Gastgeber hat vertraglich oder gesetzlich für die Gründe der späteren Belegung einzustehen.
5.3. Die Freimachung der Unterkunft des Gastes hat zum vereinbarten Zeitpunkt, ohne besondere Vereinbarung spätestens bis 11:00 Uhr des Abreisetages zu erfolgen. Bei nicht fristgemäßer Räumung der Unterkunft kann der Gastgeber eine entsprechende Mehrvergütung verlangen. Die Geltendmachung eines weitergehenden Schadens bleibt dem Gastgeber vorbehalten.
6. Pflichten des Gastes; Kündigung durch den Gast oder den Gastgeber 6.1. Der Gast ist verpflichtet, die Unterkunft und ihre Einrichtungen sowie alle Einrichtungen des Gastgebers nur bestimmungsgemäß, soweit (wie z.B. bei Schwimmbad und Sauna) vorhanden nach den Benutzungsordnungen und insgesamt pfleglich zu behandeln.
6.2. Der Gast ist verpflichtet, eine Hausordnung oder Hofordnung, die ihm bekannt gegeben wurde oder für die aufgrund entsprechender Hinweise eine zumutbare Möglichkeit der Kenntnisnahme bestand, zu beachten.
6.3. Der Gast ist verpflichtet, die Unterkunft und deren Einrichtungen beim Bezug zu überprüfen und feststellbare Mängel oder Schäden dem Gastgeber unverzüglich mitzuteilen.
6.4. Der Gast ist verpflichtet, dem Gastgeber auftretende Mängel und Störungen unverzüglich anzuzeigen und Abhilfe zu verlangen. Unterbleibt diese Mängelanzeige des Gastes schuldhaft, können Ansprüche des Gastes an den Gastgeber ganz oder teilweise entfallen.
6.5. Der Gast kann den Vertrag nur bei erheblichen Mängeln oder Störungen kündigen. Der Gast hat dem Gastgeber zuvor im Rahmen der Mängelanzeige eine angemessene Frist zur Abhilfe zu setzen, es sei denn, dass die Abhilfe unmöglich ist, vom Gastgeber verweigert wird oder die sofortige Kündigung durch
ein besonderes, dem Gastgeber erkennbares Interesse des Gastes sachlich gerechtfertigt ist oder dem Gast aus solchen Gründen die Fortsetzung des Aufenthalts objektiv unzumutbar ist.
7. Haftungsbeschränkung
7.1. Der Gastgeber haftet unbeschränkt, soweit
• der Schaden aus der Verletzung einer wesentlichen Pflicht resultiert, deren Erfüllung die ordnungsgemäße Durchführung des Vertrages überhaupt erst ermöglicht oder deren Verletzung die Erreichung des Vertragszwecks gefährdet
• der Schaden aus der Verletzung des Lebens, des Körpers oder der Gesundheit resultiert. Im Übrigen ist die Haftung des Gastgebers beschränkt auf Schäden, die durch den Gastgeber oder dessen Erfüllungsgehilfen vorsätzlich oder grob fahrlässig verursacht wurden.
7.2. Die eventuelle Gastwirtshaftung des Gastgebers für eingebrachte Sachen gemäß §§ 701 ff. BGB bleibt durch diese Regelung unberührt.
7.3. Der Gastgeber haftet nicht für Leistungsstörungen im Zusammenhang mit Leistungen, die während des Aufenthalts für den Gast erkennbar als Fremdleistungen lediglich vermittelt werden (z.B. Ausflüge, Eintrittskarten, Karten für Beförderungsleistungen, Sportveranstaltungen, Theaterbesuche, Ausstellungen usw.). Entsprechendes gilt für Fremdleistungen, die vom Gastgeber bereits zusammen mit der Buchung der Unterkunft vermittelt werden, soweit diese in der Ausschreibung bzw. der Buchungsbestätigung ausdrücklich als Fremdleistungen gekennzeichnet sind.
8. Besondere Regelungen im Zusammenhang mit Pandemien (insbesondere dem Corona-Virus)
8.1. Die Parteien sind sich einig, dass die vereinbarten Leistungen durch den jeweiligen Gastgeber stets unter Einhaltung und nach Maßgabe der zum jeweiligen Reisezeitpunkt geltenden behördlichen Vorgaben und Auflagen erbracht werden.
8.2. Der Gast erklärt sich einverstanden, angemessene Nutzungsregelungen oder -beschränkungen von THG und den Gastgebern bei der Inanspruchnahme von Leistungen zu beachten und im Falle von auftretenden typischen Krankheitssymptomen den Gastgeber unverzüglich zu verständigen.
9. Alternative Streitbeilegung; Rechtswahl und Gerichtsstand
9.1. THG und der Gastgeber weisen im Hinblick auf das Gesetz über Verbraucherstreitbeilegung wird darauf hin, dass weder THG noch der Gastgeber derzeit an einer freiwilligen Verbraucherstreitbeilegung teilnehmen, soweit in Printmedien oder Internetauftritten der Gastgeber nichts anderes angegeben ist. Sofern die Teilnahme an einer Einrichtung zur Verbraucherstreitbeilegung nach Drucklegung dieser Vermittlungs- und Gastaufnahmebedingungen für den Gastgeber verpflichtend würde, wird der Gast hierüber in geeigneter Form informiert. Für alle Vermittlungs- und Gastaufnahmeverträge, die im elektronischen Rechtsverkehr geschlossen wurden, wird auf die europäische Online-Streitbeilegungs-Plattform https://ec.europa.eu/consumers/odr/ hingewiesen.
9.2. Auf das Vertragsverhältnis zwischen dem Gast und dem Gastgeber findet ausschließlich deutsches Recht Anwendung. Entsprechendes gilt für das sonstige Rechtsverhältnis.
9.3. Der Gast kann den Gastgeber nur an dessen Sitz verklagen.
9.4. Für Klagen des Gastgebers gegen den Gast ist dessen Wohnsitz maßgebend. Für Klagen gegen Gäste, die Kaufleute, juristische Personen des öffentlichen oder privaten Rechts oder Personen sind, die Ihren Wohn-/Geschäftssitz oder gewöhnlichen Aufenthaltsort im Ausland haben, oder deren Wohn-/Geschäftssitz oder gewöhnlicher Aufenthalt im Zeitpunkt der Klageerhebung nicht bekannt ist, wird als Gerichtsstand der Sitz des Gastgebers vereinbart.
9.5. Die vorstehenden Bestimmungen gelten nicht, wenn und insoweit auf den Vertrag anwendbare, nicht abdingbare Bestimmungen der Europäischen Union oder andere internationale Bestimmungen anwendbar sind.
© Urheberrechtlich geschützt; Noll | Hütten | Dukic Rechtsanwälte, München | Stuttgart, 2022
Vermittler der Gastaufnahmeverträge ist: Tourismus Hörnerdörfer GmbH, Am Anger 15, 87538 Fischen i. Allgäu, Geschäftsführer: Bernward Lingemann, Tel. +49 8326 36460, Fax +49 8326 364656, info@hoernerdoerfer.de, www.hoernerdoerfer.de, Registereintragung: HRB 8730 (AG Kempten)
137
Flexibel anreisen in die Hörnerdörfer
Mit der Bahn Montag bis Freitag aus Dortmund und Hamburg mit dem IC direkt in die Hörnerdörfer, Bahnstation Fischen i. Allgäu. Bitte beachten Sie aktuelle Baustellen. Weitere gute Anschlüsse über Ulm und Augsburg. Den Rest des Weges in die Hörnerdörfer können Sie in alle Richtungen bequem mit Bus oder Taxi zurücklegen.
DB-Gepäckservice
Lassen Sie
Ihr Gepäck von Haus zu Haus befördern. Abholzeiten bitte gleich beim Kauf des Bahn-Tickets bei der DB Verkaufsstelle (DB Reisezentren) vereinbaren oder telefonisch unter Tel. 0180 6996633
Mit dem Auto
erreichen Sie uns über die Autobahnen A7 bis Autobahnkreuz Allgäu und A980, Ausfahrt Waltenhofen. Weiter auf der vierspurigen Schnellstraße B19 bis Sonthofen und in weiteren 16 Min. in die Hörnerdörfer.
Per Flugzeug
Bodensee-Airport Friedrichshafen Entfernung ca. 100 km. Shuttle vom Flughafen Friedrichshafen in die Hörnerdörfer möglich. Shuttle-Fahrplan unter www.allgaeu-walser-express.com Infos und Flug-Buchung unter www.bodensee-airport.eu
Allgäu Airport Memmingen
Weitere Auskünfte
erhalten Sie in den Gästeinformationen der Hörnerdörfer, unter Tel. 08326 36460 oder www.hoernerdoerfer.de/ anreise.
Entfernung ca. 80 km. Shuttle vom Flughafen Memmingen in die Hörnerdörfer möglich. Flughafentransfer buchbar unter www.allgaeu-airport-express.de Infos und Flug-Buchung unter www.memmingen-airport.de
ÖPNV – und Ihr Auto hat Urlaub
Gönnen Sie Ihrem Auto im Urlaub eine Pause und steigen Sie bequem auf Bus und Bahn des öffentlichen Nahverkehrs um. Mit der exklusiven ÖPNV-Urlaubskarte sind Sie stets mobil und sparen sich zudem die zeitraubende Parkplatzsuche.
Die Urlaubskarte gilt wahlweise für 4, 7 oder 14 Tage im südlichen Oberallgäu und Kleinwalsertal. Preis für Erwachsene: 4 Tage: 17,- € 7 Tage: 23,- € 14 Tage: 36,- € Kinder unter 15 Jahren fahren in Begleitung eines Elternteils kostenlos.
Stand Mai 2022. Änderungen vorbehalten.
Das Ticket wird ganz bequem auf Ihre Gästekarte aufgebucht. Fragen Sie Ihren Gastgeber oder besuchen Sie uns in einer der Gästeinformationen der fünf Hörnerdörfer.
BALDERSCHWANG Stuttgart
Oberstdorf Hindelang FISCHEN OBERMAISELSTEIN BOLSTERLANG OFTERSCHWANG Sonthofen Immenstadt Oberstaufen Lindau Friedrichshafen (90 km) D CH A Kempten Memmingen (78 km) Oy-Mittelberg Waltenhofen Richtung Ulm/Stuttgart Richtung Füssen/Österreich Richtung Kleinwalsertal A7 A7 B12 B19 B19 A980 B310 B308 B308 Richtung München Bodensee N
(202 km) München (189 km)
Stand Mai 2022
138
PiktogrammeGästeinformationen
Fischen
Am Anger 15 | 87538 Fischen | Tel. 08326 36460 fischen@hoernerdoerfer.de
Ofterschwang
Kirchgasse 1 | 87527 Ofterschwang | Tel. 08321 82157 ofterschwang@hoernerdoerfer.de
Obermaiselstein
Am Scheid 18 | 87538 Obermaiselstein | Tel. 08326 277 obermaiselstein@hoernerdoerfer.de
Bolsterlang
Rathausweg 4 | 87538 Bolsterlang | Tel. 08326 8314 bolsterlang@hoernerdoerfer.de
Balderschwang
Dorf 11 | 87538 Balderschwang | Tel. 08328 1056 balderschwang@hoernerdoerfer.de


Sonderpiktogramme
Freie Fahrt mit den Allgäuer Hörnerbahnen
Gutes vom Dorf
Bergbahnen Oberstdorf/ Kleinwalsertal gratis Bauernhof
Gastgeber mit Herz
e

Frühstücksbuffet
Bei FeWo: Frühstück auf Anfrage Brötchenservice Bad/Dusche/WC
Wohn-/Schlafraum getrennt 2 getrennte Schlafzimmer Kochgelegenheit Küche Balkon/Terrasse Liegewiese Spielplatz/-wiese Kinderausstattung Aufenthaltsraum
Nichtraucherzimmer/-FeWo bzw. -haus Sat-TV in Zimmer/FeWo Internet-PC für Gäste vorhanden W-LAN Waschmaschine Haustiere auf Anfrage Hallen-/Schwimmbad Whirlpool Sauna Solarium Kosmetik/Massage Golf Fahrradverleih Parkplatz am Haus Garage Personenlift
Rollstuhl-/behindertengerecht Englisch Französisch Niederländisch
c
1 h i j k l m n o s v w x t I z r a g b d 2 3 4 q 5 f 6 7 8 9
139


Gästeinformationen in den Hörnerdörfern: Fischen i. Allgäu, Tel. 08326 36460 | Ofterschwang, Tel. 08321 82157 | Obermaiselstein, Tel. 08326 277 Bolsterlang, Tel. 08326 8314 | Balderschwang, Tel. 08328 1056 www.hoernerdoerfer.de
Fischen | Ofterschwang | Obermaiselstein | Bolsterlang | Balderschwang









 Kempten
Kempten



























 Sonderdorfer Kreuz
Sonderdorfer Kreuz



































































 Aus der alten Venediger Spiegel-Sage
Aus der alten Venediger Spiegel-Sage







 Auf dem Weg zum Riedberger Horn
Auf dem Weg zum Riedberger Horn


















































































































































































































































































































 Hotel Landhaus Schmid
Hotel Landhaus Schmid






















































 Gästehaus Koch 3F BBBB A1
Zuhaus am Malerwinkel
Gästehaus Koch 3F BBBB A1
Zuhaus am Malerwinkel



















































































































































































































































































 Landhaus Buhl B5
Landhaus Buhl B5



















 Landhaus Milena B5
Haus Natterer A4
Landhaus Milena B5
Haus Natterer A4















































































































































































































 Charivari Landhaus
Charivari Landhaus





























 Haus Sichler
H2
Haus Tannheimer G3
Landhaus Vogler E2
Haus Sichler
H2
Haus Tannheimer G3
Landhaus Vogler E2
 HörnerDörfer
HörnerDörfer






























